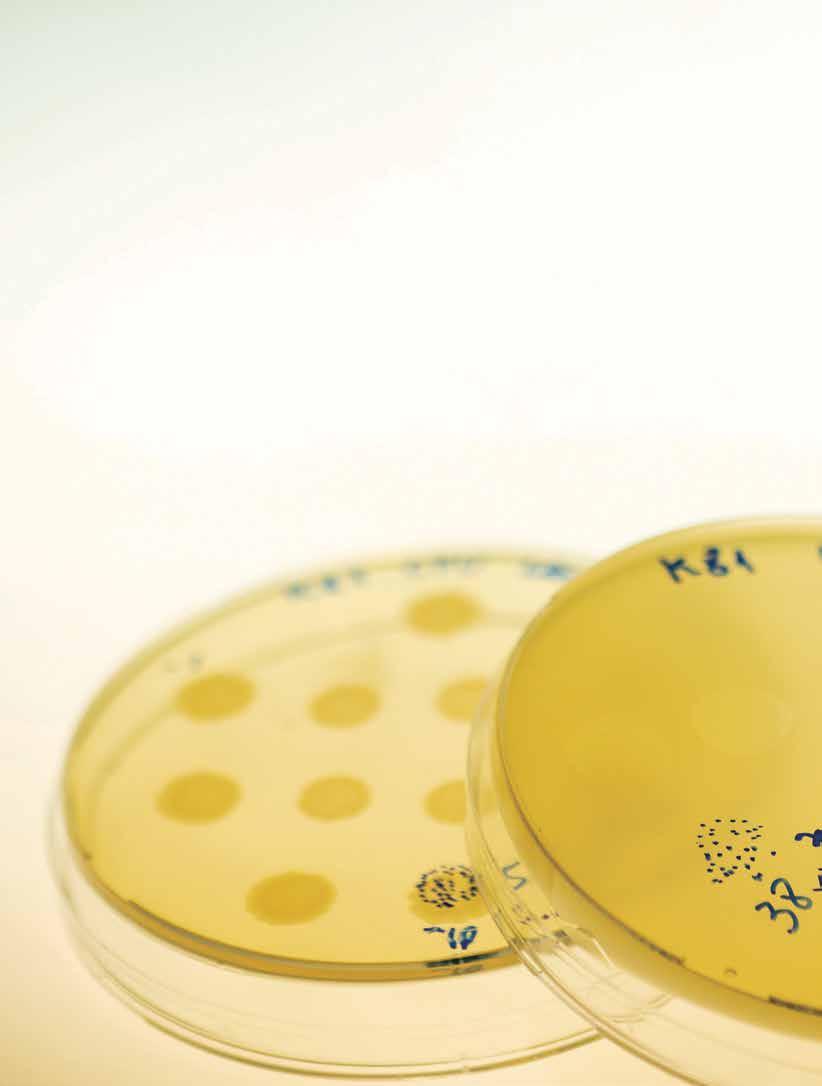
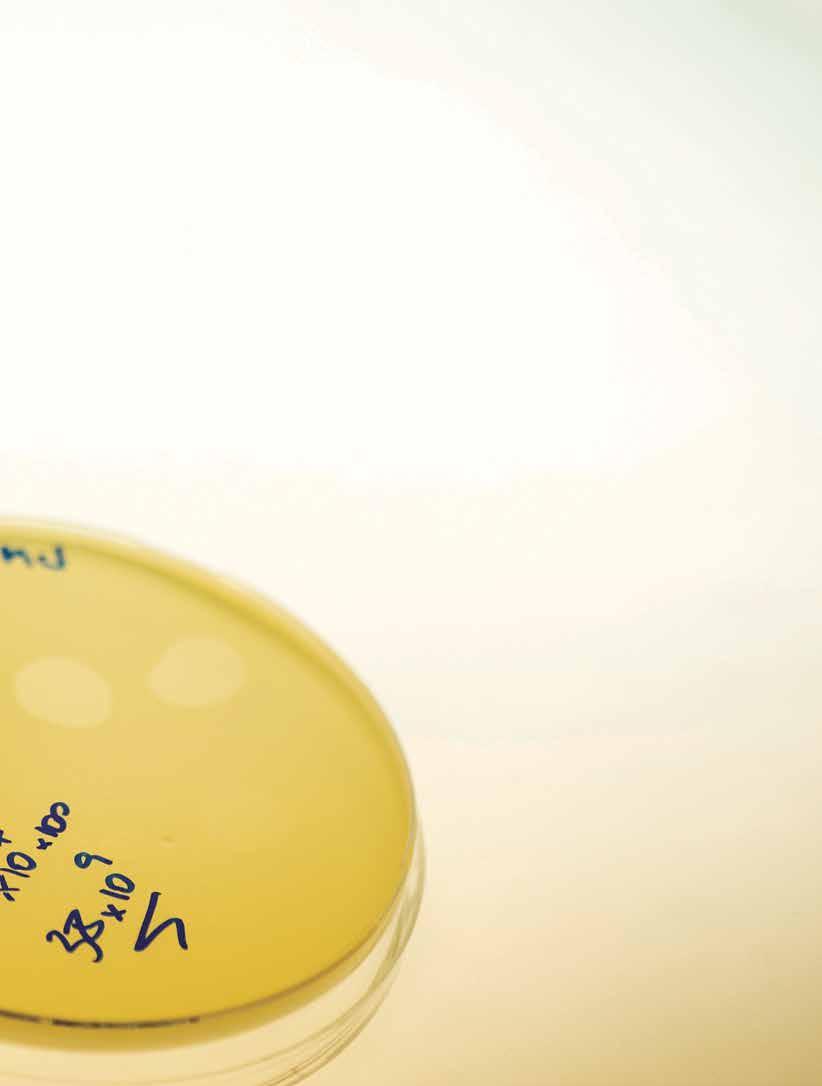

pesquisafapesp



Tratamentos com vírus que atacam bactérias ganham espaço contra infecções resistentes a antibióticos
Consumo de drogas ilícitas cresceu cerca de 80% no Brasil de 2012 a 2023
Levantamento aponta cientistas brasileiros mais influentes nas políticas públicas
Gás de efeito estufa, metano pode ser usado para fabricar plásticos e fertilizantes
Milton Santos, 100 anos: geógrafo refletiu sobre o espaço e as desigualdades sociais
Em quatro décadas, Pantanal foi o bioma que mais aqueceu e secou no país
ACESSO ABERTO E COM ATUALIZAÇÕES DIÁRIAS
REPORTAGENS EXCLUSIVAS
VÍDEOS, PODCASTS E GALERIAS DE IMAGENS
NAVEGAÇÃO SIMPLES
COMPATÍVEL COM DISPOSITIVOS MÓVEIS



Cadastre-se e receba nossas newsletters gratuitas
O letrista Kekel desenha o nome do barco em um rio do Pará: trabalho artesanal (DESIGN, P. 80)

5 CARTA DA EDITORA 6 NOTAS
CAPA
Representação artística de vírus sobre uma bactéria
ALEXANDRE AFFONSO/ REVISTA PESQUISA FAPESP
CAPA
12 Com regulamentação, fagoterapia pode se tornar alternativa contra infecções multirresistentes
20 Médico paraense foi um dos pioneiros no tratamento com vírus, um século atrás
ENTREVISTA
22 Ex-ministro Luiz Carlos Bresser-Pereira revê sua trajetória de economista e gestor
FINANCIAMENTO
28 Cresce fomento à pesquisa nos estados em meio a oscilações de investimentos federais
ACESSO ABERTO
31 Autores brasileiros passam a ter isenção de taxas em milhares de periódicos científicos
INDICADORES
34 Levantamento aponta cientistas brasileiros que mais influenciam nas políticas públicas
ENTREVISTA
38 Médico Aluísio Segurado fala de planos e prioridades à frente da reitoria da USP
BOAS PRÁTICAS
40 Inteligência artificial impulsiona escrita de artigos e é usada na avaliação por pares
DADOS
43 Pedidos de patentes depositados no Brasil
AMBIENTE
44 Pantanal é o bioma nacional que mais aqueceu e perdeu chuvas em 40 anos
49 2025 foi o terceiro ano mais quente desde a era pré-industrial
ECOLOGIA
50 Em experimentos, queimadas e pastejo melhoram a saúde de campos de Cerrado
ZOOLOGIA
54 Sons de baleias-bicudas são registrados em águas profundas da bacia da foz do Amazonas
NEUROLOGIA
56 Terapia gênica em dose única melhora movimentos em crianças com atrofia muscular espinhal
VIROLOGIA
58 Vírus da gripe aviária entrou no Brasil por duas rotas migratórias em 2025
SAÚDE PÚBLICA
61 Consumo de drogas ilícitas cresceu cerca de 80% no país
FÍSICA
64 Descoberta sobre como o próton perde energia pode ser útil para terapia contra o câncer
ENGENHARIA AERONÁUTICA
66 Carro voador brasileiro inicia campanha de testes para obter certificação
BIOTECNOLOGIA
70 Startup constrói biorreator para automatizar a produção de insumos agrícolas

Irerês, aves aquáticas comuns no país: espécie foi atingida pela gripe aviária (VIROLOGIA, P. 58)
QUÍMICA
73 Nova rota pode converter metano em insumo para fabricar plásticos e combustíveis sustentáveis
GEOGRAFIA
76 No marco do seu centenário, Milton Santos é lembrado pelas contribuições à sua área
DESIGN
80 Letristas populares inserem sotaque próprio no espaço público

Estudada no Brasil há mais de 100 anos, a impressão digital continua central na ciência forense (MEMÓRIA, P. 90)
DEMOGRAFIA
84 Enfermeiros enfrentam sobrecarga, baixos salários e múltiplos vínculos trabalhistas
OBITUÁRIO
88 Rubens Junqueira Villela (1930-2026)
MEMÓRIA
90 Galdino Ramos ajudou a moldar a ciência das impressões digitais no início do século XX
ITINERÁRIOS DE PESQUISA
94 Curador no Museu Field (EUA), o paraibano Anderson Feijó estuda mamíferos mundo afora
RESENHA
96 Elisa Martins da Silveira: “Arte naïf” posta em questão, de Felipe Scovino. Por Roberto Conduru
97 COMENTÁRIOS
98 FOTOLAB
WWW.REVISTAPESQUISA.FAPESP.BR

ESTUDANTES PRETOS E PARDOS AMPLIAM PRESENÇA NA PÓS-GRADUAÇÃO
Desigualdade racial no acesso ao mestrado e doutorado, no entanto, ainda é expressiva

COMO DRONES
ESTÃO AJUDANDO A COMBATER INCÊNDIOS
Sensores e inteligência artificial são usados para monitorar florestas e detectar focos de fogo

PODCAST
TERRITÓRIOS
AGRÍCOLAS EM MOVIMENTO
O debate sobre as culturas que vêm migrando para novas áreas no Brasil e como as mudanças climáticas podem acelerar esse processo. E mais: biorrepositório; peixe-jaguar; simbiose
Este conteúdo está disponível em acesso aberto no site www.revistapesquisa.fapesp.br, que contém, além de edições anteriores, versões em inglês e espanhol e material exclusivo
Os primeiros registros conhecidos de infecções em hominídeos datam de centenas de milhares de anos atrás, e há evidência do uso de compostos para combater essas formas de contágio em civilizações como o Egito Antigo, há 3.500 anos. No final do século XIX, bactérias foram identificadas como causadoras de diversas infecções, o que direcionou a busca por curas. E foi na década de 1910 que cientistas observaram a existência de vírus que atacam bactérias. Dos bacteriófagos – do grego phago, devorar – nasceu uma forma de tratamento chamada fagoterapia.
Demorou pouco para que a novidade chegasse ao Brasil: no Instituto Oswaldo Cruz, no Rio, o médico paraense José da Costa Cruz isolou esses vírus especializados em infectar, parasitar e destruir células bacterianas. Estudando o comportamento dos fagos, em 1921 testou com sucesso seu uso em pacientes durante surtos de disenteria. Costa Cruz analisou características como especificidade, estabilidade, resistência e adaptação dos bacteriófagos, comparando resultados obtidos em distintas regiões do país ( pá gina 20).
A descoberta e o uso em massa dos antibióticos no tratamento de infecções bacterianas, a partir dos anos 1940, levaram ao gradual abandono dessa forma de terapia, exceto em alguns países, como a Geórgia. O interesse pelos fagos vem sendo retomado, em decorrência do avanço da resistência bacteriana e das limitações do a rsenal disponível de antibióticos para tratar infecções graves.
Nosso colaborador Guilherme Costa conta que, a partir de uma biblioteca de fagos, se pode montar coquetéis com vírus diferentes, capazes de atacar as espécies bacterianas mais comuns ou as identificadas nos pacientes. Por invadi-
rem células específicas, com o fim da infecção esses vírus desaparecem do organismo humano, sem que tenham sido identificados efeitos colaterais. As complexidades desse tipo de terapia e o estado da arte das pesquisas no Brasil e no exterior são apresentados na reportagem de capa ( página 12).
Em muitos momentos, o fazer jornalístico se entrelaça com o ofício historiográfico. A seção Memória traz a história de Galdino Ramos – tal como Costa Cruz, um médico originário de regiões mais distantes do centro político e econômico brasileiro na virada para o século XX. O piauiense foi pioneiro na datiloscopia, ciência das impressões digitais, e sua trajetória fascinou o perito Gabriel Gomes, da Polícia Federal do Paraná. Integrante do grupo de pesquisa em papiloscopia forense da Academia Nacional de Polícia, Gomes “descobriu” Ramos durante o mestrado em estatística na UnB. Com seu orientador, o físico e estatístico Raul Matsushita, e a historiadora e bibliotecária da Fiocruz Maria Cláudia Santiago, ele localizou a tese de Galdino Ramos, “Da identificação”, defendida em 1906 na então Faculdade de Medicina do Rio de Janeiro, e realizou um trabalho sistemático de resgate da memória científica do médico ( página 90). Ao ser procurado por Pesquisa FAPESP, Gomes aproveitou a solicitação de imagens para ilustrar a reportagem e entrou em contato com a família de Ramos, o que resultou na ampliação do acervo público de fotografias do médico, algumas das quais reproduzidas nesta edição. Essa história foi contada por nossa colaboradora potiguar Mariana Ceci. Em um sentido poético, são todos abridores de letras – termo usado em regiões do país para definir o ofício de traçar, com um pincel, letras que formam nomes, dizeres e palavras em barcos, muros e fachadas ( página 80).

Um voluntário remove óleo cru de uma praia de Camaçari, na Bahia, em novembro de 2019; e garrafa com óleo que chegou ao litoral dos Estados Unidos (abaixo)

Do final de maio a setembro de 2020, os integrantes da organização não governamental Friends of Palm Beach, dedicada à limpeza do litoral da famosa cidade da Flórida, nos Estados Unidos, notaram a chegada de uma quantidade incomum de garrafas de vidro e plástico com rótulos em português, espanhol ou inglês com camadas de resíduos pretos sobre elas. O número de itens diários coletados chegou a 12 em junho e julho, caindo para três em setembro. Era intrigante, porque nenhum derramamento de óleo recente havia sido relatado naquela região. Atraídos para o problema, pesquisadores da Universidade Northeastern e do Instituto Oceanográfico Woods Hole, ambos dos Estados Unidos, e da Universidade Federal do Ceará verificaram que o óleo tinha o mesmo perfil químico do que vazou de um navio não identificado e se espalhou por 3 mil quilômetros (km) do litoral brasileiro de agosto a dezembro de 2019. A análise da circulação marinha reforçou a conclusão de que o óleo deve ter percorrido 8,5 mil km da costa brasileira à da Flórida em cerca de 240 dias, carregado pelos detritos (Environmental Science & Technology, 7 de janeiro).
Um grupo de pesquisadores brasileiros caracterizou a frequência e a gravidade das manifestações associadas à síndrome congênita do zika (SCZ), com base em informações sobre 843 crianças. “Até o momento, a caracterização da SCZ se baseava em séries de casos e estudos com poucos participantes”, explicou a neonatologista Maria Elisabeth Moreira, da Fundação Oswaldo Cruz, uma das autoras do estudo, em um comunicado à imprensa. Dos bebês infectados pelo zika na gestação, 80% nasceram com microcefalia (o cérebro menor que o normal para o tamanho e a idade gestacional) e 20% a desenvolveram nos primeiros meses de vida. As alterações mais frequentes foram as calcificações no cérebro, o aumento das cavidades cerebrais e a atrofia do córtex. Os problemas neurológicos mais comuns foram persistência dos reflexos primitivos (manutenção de movimentos involuntários que deveriam desaparecer com o amadurecimento) e epilepsia. Metade delas também apresentava dificuldade de prestar atenção a quem lhes dirige a palavra ou de seguir instruções para realizar tarefas (PLOS Global Public Health, 29 de dezembro).
Em março, o infectologista brasileiro Marcus Vinicius Guimarães Lacerda, da Universidade do Estado do Amazonas e da Universidade do Texas, Divisão Médica, nos Estados Unidos, assume como diretor do Programa Especial para Pesquisa e Treinamento em Doenças Tropicais (TDR) da Organização Mundial da Saúde (OMS). Também pesquisador da Fundação Oswaldo Cruz (Fiocruz) Amazônia, em Manaus, trabalhou com comunidades remotas tratando doenças tropicais e participou da implementação da profilaxia oral e injetável para HIV e de tafenoquina em dose única para tratamento de malária vivax na região. Durante a pandemia de Covid-19, sofreu perseguição por ter coordenado um estudo que atestava a ineficácia do medicamento cloroquina contra a doença. Atualmente coordena um projeto que usa tecnologia para garantir acesso a diagnósticos mais rápidos e tratamento mais eficaz contra a malária para quem vive em localidades amazônicas remotas. Criado em 1975, o TDR é uma colaboração científica global para desenvolver soluções inovadoras contra doenças infecciosas que afetam os mais pobres (Fiocruz, 15 de janeiro).

de microscopia eletrônica de cópias do vírus zika (em vermelho) obtidas de uma criança brasileira com microcefalia
Na Fazenda Solar de Jack, no Colorado, nos Estados Unidos, fileiras de painéis solares se erguem sobre as plantações, produzindo energia e projetando faixas de sombra que beneficiam tanto as plantas quanto os trabalhadores rurais. É o resultado de experimentos da Universidade do Arizona, apresentados em dezembro na reunião anual da União Americana de Geofísica (AGU), em Nova Orleans, também nos Estados Unidos. Os campos híbridos de cultivo solar, conhecidos como sistemas agrivoltaicos, envolvem painéis solares instalados na altura da cabeça ou acima dela, espaçados entre as plantações para permitir que a luz solar passe pelos espaços entre eles. Os sistemas agrivoltaicos reduziram a temperatura em até 5,5 graus Celsius (°C), em comparação com fazendas sem eles, oferecendo proteção contra o sol, água potável mais fresca e redução da fadiga. “Os trabalhadores podem colocar suas garrafas embaixo dos painéis e elas permanecem frescas o dia todo”, disse Talitha Neesham-McTiernan, da Universidade do Arizona, em um comunicado (AGU, 15 de dezembro).

A sombra dos painéis solares desta fazenda no Colorado (EUA) beneficia as plantas e os trabalhadores rurais
Como parte de uma campanha para combater a obesidade infantil, o Reino Unido proibiu a veiculação de anúncios de alimentos e bebidas não saudáveis na televisão antes das 21h e na internet a qualquer hora. Esses mantimentos contêm alto teor de gordura, sal e açúcar, incluindo refrigerantes, chocolates e doces, pizzas e sorvetes. Válida desde 5 de janeiro, a proibição abrange alguns cereais matinais e mingaus, produtos de panificação adoçados, refeições e sanduíches. Em uma entrevista à BBC, Katherine Brown, professora de mudança comportamental em saúde na Universidade de Hertfordshire, disse que a proibição é algo que já deveria ter sido implementada há muito tempo: “É um passo na direção certa”. Os fabricantes de alimentos ainda poderão anunciar suas marcas, mas não produtos específicos. Os que não cumprirem as novas regras correm o risco de sofrer sanções da Autoridade de Padrões de Publicidade. Segundo o Serviço Nacional


Anúncio em rua de Londres: restrição afeta televisão e internet
de Saúde do Reino Unido, uma em cada 10 crianças em idade pré-escolar está obesa, enquanto uma em cada cinco apresenta cárie dentária aos 5 anos. O governo estima que a proibição dos anúncios evitará cerca de 20 mil casos de obesidade infantil (BBC, 5 de janeiro).
O mexilhão-dourado espalha-se com rapidez e altera o equilíbrio ecológico
Com menos de 22 milímetros (mm) de comprimento, o mexilhão-dourado (Limnoperna fortunei ), uma espécie invasora, originária do Sudeste Asiático, foi encontrado no rio Tocantins muito antes do previsto por pesquisadores. A proliferação era esperada para 2030, mas especialistas do Instituto Chico Mendes de Conservação da Biodiversidade (ICMBio) e da Universidade Federal do Pará (UFPA) identificaram uma densidade populacional média de 11.940 indivíduos por metro quadrado (m²), muito superior à de 88 indivíduos por m² encontrada em 2023. O molusco tem uma alta capacidade de filtração da água, o que altera a cadeia alimentar, e acumula metais pesados e toxinas que podem ser transferidos na cadeia alimentar. Os mexilhões se incrustam em pontes, estruturas de reservatórios e tubulações de captação de água. Segundo o engenheiro de pesca Rafael Chagas, do ICMBio, há relatos de moradores que encontraram mexilhões em caixas-d’água, presos em redes de pesca e causando mau cheiro em praias do rio Tocantins. “Reverter sua presença é extremamente difícil ou até impossível, o que resta são medidas de controle e monitoramento”, observou ( Acta Limnologica Brasiliensia, 19 de dezembro).
Os animais tendem a se adaptar às opções de comida quando as habituais saem do cardápio. “Alguns defendem que os mosquitos são ecléticos, o que acho possível para algumas espécies, mas acreditamos que a maior parte tenha suas preferências”, afirma o virologista Sergio Machado, da Universidade Federal do Rio de Janeiro (UFRJ). O desmatamento e outras ações humanas sobre a Mata Atlântica têm reduzido as fontes alimentares preferenciais de mosquitos culicídeos (o grupo dos pernilongos e muriçocas) e, por isso, eles têm se alimentado cada vez mais de sangue humano em vez do de outros tipos de animais. O achado é preocupante, porque pode acarretar o aumento da circulação de doenças como febre amarela, chikungunya e leishmaniose. Para contornar o problema, os pesquisadores aconselham a recomposição da vegetação nativa, a intensificação da vigilância epidemiológica e o acompanhamento do comportamento dos mosquitos (Frontiers, dezembro).
Desmatamento na República Centro-africana: menos florestas, mais carbono na atmosfera

africanas liberam mais
Concentradas na República Democrática do Congo, República do Congo, Gabão, Guiné Equatorial, Camarões e República Centro-africana, as florestas e savanas arborizadas da África deixaram de absorver o carbono atmosférico, armazenando-o como biomassa na vegetação. Por causa do desmatamento contínuo, começou a ocorrer o inverso em 2010, com as matas liberando mais carbono do que absorvem – o mesmo fenômeno já percebido na Amazônia (ver Pesquisa FAPESP no 287 ). O continente perdeu aproximadamente 106 bilhões de quilos de biomassa florestal por ano de 2010 a 2017, em consequência da perda de vegetação nativa. “Esse é um alerta crucial para a política climática global”, comentou Heiko Balzter, da Universidade de Leicester, em um comunicado. “Se as florestas africanas deixarem de absorver carbono, isso significa que outras regiões e o mundo como um todo precisarão reduzir ainda mais as emissões de gases de efeito estufa para se manterem abaixo do limite de 2 graus Celsius estabelecido pelo Acordo de Paris e evitar mudanças climáticas catastróficas” (Scientific Reports, 28 de novembro).
Há cerca de 55 milhões de anos, aves corredoras, crocodilos terrestres e estranhos mamíferos herbívoros, todos já extintos, circulavam na região de Itaboraí, a leste do estado do Rio de Janeiro, entre pinheiros, araucárias e arbustos. Com base em fósseis de moluscos, anfíbios, répteis, aves e mamíferos singulares, além de grãos de pólen, um grupo de paleontólogos organizou e publicou um guia da flora e da fauna antiga de Itaboraí na última Era do Gelo. Coordenado por André Eduardo Piacentini Pinheiro, da Universidade do Estado do Rio de Janeiro (Uerj), com ilustrações do artista Felipe Alves Elias, o Guia ilustrado da paleobiota de Itaboraí pode ser acessado gratuitamente pelo link https://shre. ink/5vmm. A região abriga hoje um dos principais sítios de fósseis do país, descobertos durante a mineração de calcário, que se prolongou por 51 anos, até meados dos anos 1980.
As descrições do guia contêm informações sobre o tamanho e hábitos dos animais

Com a análise do material genético de 238 pessoas que viveram nos últimos 10 milênios no Cone Sul, principalmente na Argentina, o evolucionista espanhol Javier Maravall López, estudante de doutorado na Universidade Harvard, nos Estados Unidos, detectou um povo indígena até agora desconhecido. Seus integrantes teriam predominado na região 8.500 anos atrás, possivelmente até o século XIX. Mais surpreendente é a ausência de indícios de mistura com outros povos, padrão que pode ter sido comum na região: um indivíduo que viveu cerca de 10 mil anos atrás onde agora é a Argentina central apresentou diferenças genéticas em relação às populações da porção central dos Andes e do atual Brasil. “Povos com a mesma ancestralidade, distribuídos como se fossem um arquipélago, desenvolveram culturas e línguas distintas enquanto permaneciam isolados do ponto de vista biológico”, disse López ao site Science Alert. “Com a tecnologia atual para dados de DNA antigo, é possível construir mapas refinados das mudanças de tamanho populacional e de migrações, como já existe com riqueza de detalhes na Europa, e esse estudo começa a fazer isso para a Argentina”, afirmou o geneticista David Reich, orientador de López (Nature, 5 de novembro).

Fácil de escapar das usinas de produção de energia limpa, o hidrogênio prolonga o tempo do metano na atmosfera

O hidrogênio (H₂) não é tão ambientalmente amigável quanto se pensava. Visto como alternativa limpa aos combustíveis fósseis, esse gás pode contribuir para o aumento da temperatura por ajudar o metano, um potente gás de efeito estufa, a permanecer por mais tempo na atmosfera. De acordo com as análises de uma equipe internacional formada por pesquisadores dos Estados Unidos, do Reino Unido, da Alemanha e do Japão, a concentração de H₂ na atmosfera aumentou em cerca de 4 milhões de toneladas (t) desde 1990 e chegou a 27 milhões de t em 2020. Associadas principalmente às atividades humanas, as emissões de hidrogênio contribuíram com uma fração de grau – ou 0,02 grau Celsius (°C) – para o aumento de quase 1,5 °C nas temperaturas médias desde o período pré-industrial. “O hidrogênio é a menor molécula do mundo e escapa facilmente de dutos, instalações de produção e locais de armazenamento”, disse Rob Jackson, da Universidade Stanford, nos Estados Unidos, um dos principais autores do estudo, em um comunicado. “Precisamos compreender melhor o ciclo global do hidrogênio e suas ligações com o aquecimento global para apoiar uma economia de hidrogênio segura para o clima e sustentável.” (Nature, 17 de dezembro).
Tartaruga de osso encontrada em sítio arqueológico pode ter sido feita há um milênio
Formada por folhas em decomposição, solo, nutrientes e material biológico vivo, a matéria orgânica transportada pelos rios da região siberiana da Rússia para o Círculo Polar Ártico libera gases que formam minúsculas partículas no ar, conhecidas como aerossóis. As partículas atuam como sementes para a formação de nuvens e permitem que o vapor de água se condense ao seu redor, criando gotículas de nuvem. De acordo com uma equipe internacional de pesquisadores, as partículas de aerossol afetadas por esse escoamento fluvial se formaram 300% mais rápido e cresceram 60% mais rápido durante os nove anos de observações, mapeamento por satélites e coleta de dados em campo. O aumento na quantidade de partículas de aerossol favorece a formação de nuvens e contribui para manter as temperaturas baixas da região. A descoberta aprimora os modelos computacionais de previsão climática no Ártico, que está aquecendo quatro vezes mais rápido que outras partes do mundo (Communications Earth & Environment, 22 de janeiro).
Usando uma impressora 3D de uso doméstico, moldagem de silicone e uma resina transparente tratada por radiação ultravioleta, pesquisadores da Universidade de Strathclyde, em Glasgow, na Escócia, criaram lentes de baixo custo e alta qualidade, a um custo de menos de US$ 1. Em seguida as usaram em um microscópio de iluminação estruturada multifocal, que captura múltiplas imagens depois combinadas computacionalmente, e geraram figuras de microtúbulos no citoesqueleto de uma célula com uma resolução de cerca de 150 nanômetros (nm). Em um comunicado, o autor principal do trabalho, Jay Christopher, da Universidade de Strathclyde, comentou que essa abordagem poderia permitir a produção de lentes para atender necessidades específicas dos usuários e dispensar os serviços de alto custo de fabricação de vidro. A possibilidade de adicionar mais resina transparente durante a impressão, para aumentar a clareza e a transparência da lente, mostrou-se mais rápida do que a abordagem tradicional de polimento e resultou em lentes com superfícies suficientemente lisas para competir com lentes de vidro comerciais (Biomedical Optics Express, 13 de dezembro).
Um estudo pode servir de argumento para quem diz que cães entendem o que seres humanos dizem. O experimento feito por pesquisadores da Universidade Eötvös Loránd, na Hungria, testou a capacidade de aprendizado de 20 cães e classificou as habilidades sociocognitivas de alguns como similares às de bebês humanos de 18 meses. Basta entreouvir conversas e observar a interação entre humanos para que consigam assimilar palavras e associá-las a objetos. Em um dos testes, duas pessoas conversavam sobre um objeto que não tinha sido apresentado ao cão,

Feixes de laser das microlentes produzidas por impressão 3D, moldagem em silicone e resina transparente

dizendo seu nome em voz alta sem dar atenção ao animal. Depois, o objeto era guardado em um balde e o pesquisador pedia que o cachorro trouxesse o objeto. Cinco, entre os oito animais avaliados, trouxeram o objeto correto. Os resultados indicam, até aqui, que as habilidades sociais e cognitivas que sustentam a aprendizagem de palavras não são exclusividade humana e que a capacidade de aprender por observação pode ter evoluído a partir de mecanismos sociocognitivos que precedem a linguagem (Science, 8 de janeiro).
O border collie húngaro Max sabe o nome de centenas de brinquedos
Bactéria resistente isolada de paciente e cultivada em placa de petri no laboratório do Cepid B3, em alguns pontos eliminada por bacteriófago
Mesmo sem regulamentação para tratamentos clínicos e ainda restrita ao uso compassivo, fagoterapia pode ser alternativa contra infecções multirresistentes
GUILHERME COSTA
De um ferimento comum no tornozelo a uma infecção que se tornou uma ameaça à vida de um menino de 12 anos, ativo e saudável, em Bruxelas, na Bélgica. Trata-se de uma fasciíte necrosante, doença que destrói rapidamente os tecidos moles do organismo, causada pela bactéria Staphylococcus aureus. Após o fracasso do tratamento convencional com antibióticos e de múltiplas intervenções cirúrgicas, a equipe médica decidiu recorrer a uma estratégia excepcional: uma terapia personalizada usando os vírus que infectam e destroem bactérias, os bacteriófagos (ver infográfico na página 15), mais conhecidos como fagos. O tratamento envolve a aplicação de um coquetel com vírus diferentes, capazes de atacar cada uma das espécies bacterianas identificadas. A administração do coquetel produzido por manipulação, combinado com antibióticos, permitiu reverter progressivamente a infecção e resultou na cura do paciente.
O caso, descrito em um artigo publicado na revista científica Frontiers in Cellular and Infection Microbiology, em 2024, ilustra de forma dramática um cenário que a Organização Mundial da Saúde (OMS) tem alardeado: uma em cada seis infecções bacterianas já se mostra resistente ao tratamento com antibióticos. Essa estatística está no “Relatório global de vigilância da resistência aos antibióticos 2025”, lançado em outubro pela instituição.
“Buscamos a fagoterapia personalizada, selecionando geralmente de um a três fagos que apresentem atividade in vitro contra as cepas bacterianas colhidas do paciente”, destaca em entrevista a Pesquisa FAPESP o engenheiro industrial belga Jean-Paul Pirnay, líder do Laboratório de Tec -
nologia Molecular e Celular do Hospital Militar Rainha Astrid, instituição belga na qual o menino foi tratado. “Apenas em casos muito urgentes, quando não há tempo para selecionar fagos específicos a partir da bactéria isolada do paciente, recorre-se a coquetéis mais amplos, formados por fagos com provável atividade contra as bactérias envolvidas na infecção”, detalha.
Pirnay é um dos autores do artigo que descreve o caso do jovem e de outro paper, publicado também em 2024 na revista Nature Microbiology, que apresenta os resultados dos 100 primeiros casos de tratamento à base de fagos na Bélgica. Além disso, é coautor de um artigo de janeiro de 2025 da revista Antibiotics sobre os três primeiros casos de fagoterapia para infecções ortopédicas no Reino Unido.
Ao longo da última década, a Bélgica se consolidou como uma das principais referências internacionais em fagoterapia (ver box na página 18). O país desenvolveu um marco regulatório específico para uso clínico de bacteriófagos e reconheceu essas preparações como medicamentos manipulados, passíveis de prescrição médica fora de protocolos experimentais. A retomada do interesse pelos fagos não é casual e acompanha o avanço global da resistência bacteriana e a constatação de que o arsenal de antibióticos disponível vem se tornando insuficiente para lidar com infecções graves.
Essa não é a primeira vez que os bacteriófagos despertam atenção da comunidade científica, contudo. Descobertos na Europa na década de 1910, eles passaram a ser estudados e aplicados clinicamente pouco depois em diferentes países, inclusive no Brasil. Pesquisadores do então Instituto Oswaldo Cruz, no Rio de Janeiro, investigaram e utilizaram fagos no tratamento de
infecções bacterianas já nos anos 1920. Com a disseminação dos antibióticos a partir da década de 1940, porém, essas pesquisas foram gradualmente abandonadas (ver reportagem na página 20).
Dados do Ministério da Saúde divulgados no final de 2025 apontam mais de 33 mil mortes anuais atribuídas à resistência aos antimicrobianos (RAM) no Brasil. Além de infecções mais difíceis de debelar e de exigir tratamentos prolongados, a RAM compromete procedimentos como cirurgias, transplantes e quimioterapias. Também impõe um impacto econômico significativo, com projeção de queda de US$ 3,4 trilhões por ano no PIB global até 2030, estimativa apresentada pela OMS e pela Organização Pan-americana da Saúde (Opas) em evento realizado em novembro, em Brasília.
O t ratamento clínico com fagos, no entanto, ainda não é viável no país, pois depende de uma regulamentação específica para a fagoterapia e da produção de bacteriófagos atendendo às recomendações de Boas Práticas de Fabricação de Medicamentos. “Temos aplicação de fagos em casos de mastite bovina no Brasil, na agropecuária, mas ainda não existem estudos para uso clínico em seres humanos”, destaca a infectologista Ana Cristina Gales, da Universidade Federal de São Paulo (Unifesp). “Nosso cenário regulatório é contraditório. A A nvisa [Agência Nacional de Vigilância Sanitária], por um lado, considera que o fago é um produto biológico passível de manipulação, o que poderia dispensar a exigência de ensaios clínicos; por outro, estabelece que qualquer produto destinado ao uso clínico terapêutico deve obrigatoriamente

Tubos com proteína purificada de bactérias para teste com potenciais fármacos, no IQ-USP
O tratamento pode ser um complemento essencial aos antibióticos, que enfrentam desafios
Fagos são vírus altamente específicos, incapazes de infectar células humanas, animais ou vegetais. Eles reconhecem e atacam apenas bactérias determinadas

Um fago se liga à superfície da bactéria, injeta seu material genético, multiplica-se dentro dela e provoca seu rompimento –destruindo apenas o alvo microbiano
passar por estudos clínicos de fases 1, 2 e 3.” Ela é vice-coordenadora do Instituto Paulista de Resistência aos Antimicrobianos (Cepid Aries), integra a Câmara Técnica de Resistência Microbiana da Anvisa e o Comitê Científico do Global Antibiotic Research and Development Partnership, uma organização internacional sem fins lucrativos que desenvolve novos tratamentos para infecções resistentes a antimicrobianos.
Por enquanto, o único uso possível para fagos no país é o compassivo, quando outros tratamentos já falharam e há risco iminente de morte. Um raro exemplo ocorreu com o médico infectologista Roberto Badaró, do Instituto Senai de Inovação em Sistemas Avançados de Saúde (Senai Cimatec), com sede em Salvador, que tratou um paciente com infecção por Acinetobacter baumannii e Pseudomonas aeruginosa multirresistentes, prestes a sofrer amputação do pé. Badaró aplicou uma combinação de fagos previamente caracterizados – uma dose intravenosa e aplica-
Com o avanço da resistência aos antimicrobianos, muitas bactérias não respondem mais aos antibióticos. Fagos surgem como alternativa terapêutica capaz de atuar contra infecções multirresistentes
A fagoterapia costuma ser feita sob medida: selecionam-se fagos capazes de atacar a bactéria do paciente, em muitos casos combinados a antibióticos
Casos documentados mostram melhora clínica e redução da carga bacteriana, inclusive em infecções graves e resistentes. Mas ainda há desafios, como padronização, regulamentação e produção em escala
ções tópicas diárias por 30 dias –, associada a um antibiótico que, sozinho, não havia surtido efeito. Segundo o médico, o quadro evoluiu bem, a ferida cicatrizou e o paciente manteve o membro. “Isso é um uso por compaixão, uma coisa excepcional. Agora, estamos aguardando a aprovação da Anvisa para que possamos fazer um estudo clínico”, revela. O relato desse caso está em fase de preparação para publicação.
Badaró é associado ao Centro para Aplicações e Terapias Inovadoras com Fagos (Ipath), sediado na Universidade da Califórnia em San Diego (UCSD), nos Estados Unidos. Um avanço recente do grupo foi mostrar que é possível, por meio de evolução experimental ao longo de 30 dias, aumentar o espectro de ação de fagos contra a bactéria Klebsiella pneumoniae, com frequência resistente a antibióticos, conforme artigo publicado em novembro na Nature Communications. E nquanto a regulamentação não avança, alguns grupos brasileiros já se movimentam para c riar as bases de um futuro uso clínico dos fagos. Um dos exemplos é o Centro de Pesquisa em Biologia de Bactérias e Bacteriófagos (Cepid B3),
que reúne mais de 160 pesquisadores das universidades de São Paulo (USP), Estadual de Campinas (Unicamp) e Estadual Paulista (Unesp), e Unifesp. A rede compõe, desde 2023, um dos Centros de Pesquisa, Inovação e Difusão (Cepid) financiados pela FAPESP.
No B3, cientistas de diferentes áreas trabalham com bactérias variadas, desde aquelas que afetam plantas e animais até as que causam infecções humanas. O estudo de fagos ganhou força no grupo e se tornou uma das linhas impulsionadas pela bioquímica Aline Maria da Silva, que coordenou a área dentro do centro (ver Pesquisa FAPESP nº 257) até morrer, em 2024, em consequência de um câncer. “Ela era uma pioneira, tinha uma visão da fagoterapia quando poucas pessoas no Brasil estavam pensando sobre isso”, destaca o bioquímico Shaker Chuck Farah, coordenador do Cepid e vice-diretor do Instituto de Química (IQ) da USP. “Eu vejo que a terapia com fagos é uma promessa enorme, inclusive para a linha de pesquisa que ela inaugurou aqui na USP”, afirma a bióloga Layla Farage Martins, que foi orientada por Silva no doutorado e era sua colaboradora mais próxima.
Para transformar o conhecimento acumulado na pesquisa básica em aplicação prática, por volta de cinco anos atrás o B3 estabeleceu uma p arceria científica com o Hospital das Clínicas da Faculdade de Medicina (HC-FM) da USP, que possibilita aos pesquisadores do Cepid o acesso a isolados clínicos de bactérias multirresistentes. Atualmente, um protocolo de uso clínico está em desenvolvimento pelas instituições. Uma vez estabelecido um flu-
Como um fago personalizado é preparado em poucos dias
Novos processos vêm sendo implementados para atingir a escala e a agilidade necessárias ao atendimento clínico
xo contínuo de amostras, o centro estruturará u ma linha de trabalho que começa na caracterização genômica das cepas e avança para testes sistemáticos com o acervo de fagos – etapa c rucial para identificar quais vírus são capazes de eliminar cada bactéria. A meta é consolidar, gradualmente, um banco integrado de bactérias e fagos que permita reagir com agilidade diante de casos difíceis de tratar.
“Estamos em uma etapa de pesquisa translacional”, explica o biólogo Ariosvaldo Pereira dos Santos Junior, pesquisador em estágio pós- doutoral no IQ-USP. “Nós começamos respondendo a perguntas básicas sobre os fagos e agora queremos acrescentar esse olhar terapêutico.”
O trabalho do pesquisador, após um período de doutorado nos Estados Unidos, tem sido entender quais vírus têm potencial clínico, aperfeiçoar a produção e criar protocolos que permitam chegar a uma preparação segura o suficiente para ser usada em casos compassivos. É um processo que exige testar, selecionar e descartar. Uma etapa com a qual, segundo afirma, a pesquisa brasileira ainda está aprendendo a lidar.
A Unifesp tem avançado na mesma direção. Gales já teve um protocolo aprovado no comitê de ética da instituição e busca as condições necessárias para produzir os fagos com o cuidado d e boas práticas de manufatura, etapa indispensável para iniciar o estudo. O projeto, cujo p rotocolo foi publicado em janeiro na revista International Journal of Antimicrobial Agents, prevê testar a capacidade dos fagos de descolonizar pacientes carregando bactérias multirresistentes, sobretudo em ambientes hospitalares, a ntes que passem a causar infecções graves. A proposta envolve selecionar fagos seguros e bem
A preparação começa com a identificação da bactéria causadora da infecção e a definição da necessidade terapêutica do paciente
A triagem inicial ocorre em um biobanco de fagos já catalogados, o que permite apontar rapidamente os candidatos mais promissores
São feitas análises genômicas e testes fenotípicos para identificar quais fagos têm maior chance de eficácia contra a bactéria específica
Os fagos com melhor desempenho são priorizados para acelerar o desenvolvimento terapêutico
A biblioteca de bactérias e fagos fica armazenada em freezers de centros de pesquisa

caracterizados, aplicá-los de forma controlada e monitorar se conseguem reduzir a proliferação das bactérias. Por serem especializados em invadir essas células bacterianas específicas, eles desaparecem do organismo humano junto com a infecção. Os estudos publicados até o momento não apontam a existência de efeitos colaterais graves com o uso de fagos.
A pesquisadora também avalia o sucesso da pulverização de bacteriófagos na descontaminação de ambientes hospitalares, por meio do projeto FagoLimp, financiado no âmbito do Cepid e pelo Conselho Nacional de Desenvolvimento Científico e Tecnológico (CNPq). Em um dos três hospitais testados, a estratégia conseguiu reduzir a contaminação ambiental por Klebsiella
5. Segurança por IA 6. Produção acelerada
7. Entrega e desfecho clínico
pneumoniae, uma bactéria que vem causando sérios problemas de infecção em Unidades de Terapia Intensiva (UTIs). O sucesso ainda limitado indica que a pulverização não resolve o problema, mas vale investigar sua ação integrada a outras técnicas de descontaminação.
Gales tem participado de conversas que reúnem diferentes grupos, como o B3 e o Instituto Butantan, em uma tentativa de criar bases comuns, padronizar métodos e, no futuro, formar um banco paulista de fagos que possa apoiar aplicações clínicas com mais segurança. Segundo Santos Junior, o B3 reúne cerca de 300 fagos já mapeados. Em 2025, o farmacêutico Julio Cezar Franco, do campus de Diadema da Unifesp e integrante do grupo, caracterizou 62 novos bacteriófagos obtidos a partir de uma ampla varredura em diferentes fontes. Ele recorreu a amostras de compostagem, água de rios urbanos, coleções de bactérias usadas em controle microbiológico de alimentos – como cepas de Salmonella e Listeria monocytogenes – e isolados clínicos de Escherichia coli fornecidos por grupos da própria Unifesp, formando uma rede de colaboração que permitiu ampliar o repertório de vírus disponíveis. “É preciso sempre gerar material novo nessa perspectiva da fagoterapia. É o que a gente chama de phage hunt, a caçada de fagos.”
Modelos avançados de predição estrutural permitem verificar a ausência de genes indesejáveis antes da seleção final
A formulação é fabricada em um sistema otimizado, reduzindo o tempo de processamento
O tratamento chega ao hospital e é aplicado no paciente conforme orientação médica
Em Belém, a biomédica Danielle Murici Brasiliense, pesquisadora em saúde pública do Instituto Evandro Chagas, órgão de vigilância e pesquisa vinculado à Secretaria de Vigilância em Saúde e Ambiente do Ministério da Saúde, pretende aprofundar o conhecimento nos fagos amazônicos
A Bélgica se tornou uma referência recente em fagoterapia ao criar, em 2018, o primeiro marco regulatório para o uso clínico desses vírus. Desde então, o país permite que médicos prescrevam os medicamentos à base de fagos, produzidos sob demanda para cada paciente. Segundo o engenheiro industrial belga Jean-Paul Pirnay, do Hospital Militar Rainha Astrid, apenas nessa instituição de Bruxelas, mais de 200 casos já foram atendidos, com taxas superiores a 70% de melhora clínica. “Da análise dos nossos primeiros 100 casos, houve melhora clínica e erradicação da bactéria-alvo em 77,2% e 61,3% das infecções”, celebra, em entrevista a Pesquisa FAPESP
O país opera uma rede com produção certificada, protocolos estáveis e um banco de fagos disponível para triagem rápida. Como o laboratório que conduz esse trabalho é uma estrutura de pesquisa, não tem capacidade para atender todas as solicitações que chegam. Por isso, foi criado um processo para priorizar os pacientes mais graves.
Em dezembro de 2024, Portugal adotou um enquadramento regulatório na mesma linha. O país passou a reconhecer o fago como um produto biológico que pode ser manipulado em farmácias especializadas. Embora
ainda esteja em fase de implementação prática, com hospitais e laboratórios ajustando fluxos internos, a mudança abriu caminho para o tratamento de infecções multirresistentes.
Ainda no continente europeu, na fronteira com a Ásia, a Geórgia é o país com mais tradição no uso de fagos. O Instituto Eliava, fundado em 1923, manteve a prática clínica da fagoterapia ao longo do século XX, mesmo durante períodos de instabilidade política na região e enquanto o Ocidente abandonava a abordagem devido à ascensão dos antibióticos. Essa trajetória resultou em um acúmulo de experiência clínica considerado único no mundo, que serve de referência para centros europeus que retomam a terapia fágica. Os fagos fazem parte do sistema de saúde georgiano: qualquer médico pode prescrever e qualquer cidadão pode comprar preparações diretamente em farmácias para quadros cotidianos como dor de garganta, sem necessidade de antibióticos ou consulta médica.
Na América Latina, no final de 2024, o Ministério da Saúde uruguaio autorizou a terapia personalizada com fagos para tratamento e prevenção de infecções causadas por bactérias multirresistentes. O marco foi construído em parceria com a Kinzbio,
startup fundada em 2020 pelo cientista de microbiomas Gregorio Iraola. Ele e a bióloga Josefina Puig observaram que muitos pacientes internados durante a pandemia de Covid-19 morriam não do vírus, mas de infecções resistentes a antibióticos, cenário que motivou a criação de uma plataforma dedicada à fagoterapia.
A Kinzbio opera com um biobanco de fagos e afirma adotar um processo que permite entregar preparações semipersonalizadas em 5 a 15 dias (ver infográfico nas páginas 16 e 17 ). “Em mais de 20 casos recentes, nossos tratamentos demonstraram resultados clínicos convincentes. Observamos uma taxa superior a 90% de cura microbiológica completa e não registramos efeitos adversos ou colaterais em nenhum dos casos tratados”, enfatiza Iraola a Pesquisa FAPESP. Seu grupo depositou como preprint no repositório Research Square, em outubro, o que ele qualifica como o primeiro relato de caso de tratamento contemporâneo documentado na América Latina. No Brasil, a empresa participa do Programa de Aceleração para Startups da Eretz.bio, hub de startups do Einstein Hospital Israelita, e tem processo submetido à Agência Nacional de Vigilância Sanitária (Anvisa) para regulamentação de sua plataforma de fagoterapia.

Ao computador, análise genômica da suscetibilidade de Staphylococcus aureus aos fagos terapêuticos da empresa uruguaia 1
Os hospitais, especialmente as UTIs, são foco de bactérias multirressistentes que causam preocupação crescente

e, no futuro, constituir um banco local. Embora estude microrganismos multirresistentes há anos, seu primeiro contato com os fagos ocorreu a partir de um projeto aprovado em edital de internacionalização do CNPq, que previa testar a suscetibilidade de isolados da bactéria Klebsiella pneumoniae da região amazônica a uma coleção de bacteriófagos da Universidade de Oxford, no Reino Unido.
Embora dificuldades logísticas tenham impedido o envio das amostras locais, a pesquisadora analisou mais de 100 fagos disponíveis no laboratório inglês e montou coquetéis capazes de inibir completamente o crescimento das bactérias. A experiência consolidou a base para o próximo passo: a criação, a partir deste ano, de uma coleção própria de fagos isolados na Amazônia. “Se há uma diversidade tão grande de microrganismos na Amazônia, certamente temos uma diversidade muito grande de fagos”, pondera.
Bem distante do calor amazônico, o biólogo brasileiro Gabriel Almeida tem apostado em outra abordagem: o uso profilático dos fagos. Da Universidade do Ártico da Noruega e integrante do Centro para Novas Estratégias Antibacterianas (Cans), também no país nórdico, ele direciona seus estudos para entender como esses vírus podem atuar antes mesmo de uma infecção se instalar.
Seu foco está na relação dos fagos com as mucosas, dinâmica que ele já havia explorado na Finlândia e agora tenta levar para um teste clínico em parceria com grupos europeus. O pesquisador explica que alguns bacteriófagos teriam evoluído
para ligar-se às superfícies mucosas, como as do intestino e do pulmão, onde conseguem permanecer retidos por dias. Essa retenção faria com que atuassem como uma linha de defesa antecipada, já posicionada para agir assim que uma bactéria patogênica entre em contato com a mucosa.
Almeida investiga agora formas de prever essas interações a partir do genoma dos vírus, em u m esforço que reúne equipes de diferentes países. “Queremos predizer essas interações entre fago e mucosa a partir do genoma. Atualmente, temos que testar um por um na bancada, o que é possível, mas gasta tempo, reagentes e precisa de gente para fazer”, enumera. Para ganhar agilidade e precisão, Almeida pretende desenvolver um sistema capaz de, a partir do genoma do fago, indicar automaticamente seu potencial de ação, facilitando inclusive a escolha clínica em situações reais.
A utilização de inteligência artificial (IA) também começa a remodelar as fronteiras da pesquisa com bacteriófagos. Um artigo ainda não validado por pares, publicado em setembro no repositório de preprints bioRxiv, descreve a criação de um fago inteiramente projetado por IA, com um genoma sintético funcional. O resultado do trabalho conduzido por pesquisadores do Arc Institute, da Universidade Stanford, e do Memorial Sloan Kettering Cancer Center, todos nos Estados Unidos, aponta para um futuro em que os fagos possam ser desenhados sob medida. Caso essa abordagem se confirme segura e replicável, abrirá caminho para ampliar rapidamente o repertório terapêutico disponível. l
Os projetos e os artigos científicos consultados para esta reportagem estão listados na versão on-line.
Poucos anos após as primeiras descobertas na Europa, médico paraense começou a aplicar o tratamento em Minas Gerais
GUILHERME COSTA
OBrasil entrou muito cedo na história da fagoterapia, quase em paralelo às primeiras descobertas que deram origem a essa abordagem terapêutica no início do século XX. Em 1915, o b acteriologista inglês Frederick William Twort (1877-1950) descreveu um “agente filtrável” capaz de destruir bactérias, sugerindo tratar-se de um vírus. Dois anos depois, em 1917, o microbiologista franco-canadense Félix d’Hérelle (1873-1949), então no Instituto Pasteur, em Paris, chegou de forma independente à mesma conclusão, caracterizou esses agentes como vírus parasitas de bactérias e cunhou o termo “bacteriófago”. Essa dupla descoberta é considerada o marco fundacional da fagoterapia e explica a observação anterior do bacteriologista britânico Ernest Hankin (1865-1939), que em 1896 descreveu na revista Annales de L’Institut Pasteur a observação de que havia menos bactérias nos rios Yamuna e Ganges, na Índia, do que em cursos-d’água equivalentes na Europa. Em seus experimentos, a água dos rios indianos teve ação bactericida contra o bacilo causador da cólera, o que mais tarde foi visto por alguns como possível primeira observação de bacteriófagos. Pouco tempo depois, a teoria começou a ganhar corpo na prática clínica. Em 1919, d’Hérelle utilizou bacteriófagos para tratar casos de disenteria e, ao longo da década de 1920, relatou aplicações bem-sucedidas também contra a cólera, inclusive em campanhas profiláticas na Índia. Essas experiências ajudaram a consolidar a ideia, então inovadora, de que vírus poderiam ser usa-

dos deliberadamente como agentes terapêuticos contra bactérias patogênicas.
No Brasil, o nome central desse período foi o médico paraense José da Costa Cruz (1894-1940), do Instituto Oswaldo Cruz (IOC), no Rio de Janeiro. Ele isolou fagos, investigou seu comportamento e os testou em pacientes durante surtos de d isenteria. As primeiras aplicações ocorreram em 1921, em Barbacena (MG), quando Costa Cruz tratou casos graves de diarreia infecciosa com preparações produzidas no próprio instituto. Dois anos depois, diante de novos episódios da doença no Rio de Janeiro, ele apresentou resultados positivos: segundo seus registros, muitos pacientes relataram melhora em poucas horas e cura em um a dois dias.
Propaganda publicada em 1934 de produtos à base de bacteriófagos produzidos pelo laboratório Raul Leite, no Rio de Janeiro

José da Costa Cruz (na outra página) esteve entre os cientistas que receberam Albert Einstein na Fiocruz em 1925: na foto (à dir.) ele aparece atrás do ombro esquerdo do ilustre físico alemão

O avanço levou o instituto a produzir e distribuir nacionalmente a Bacteriofagina disenterica, considerado o primeiro produto terapêutico brasileiro à base de fagos e uma das primeiras preparações desse tipo feitas em larga escala no mundo. O trabalho combinava investigação básica, desenvolvimento tecnológico e aplicação clínica. Costa Cruz testava especificidade, estabilidade, adaptação, resistência e aspectos imunológicos dos bacteriófagos, além de comparar resultados entre diferentes regiões do país.
Apesar do pioneirismo, a fagoterapia acabou sendo descontinuada no Brasil. De acordo com o historiador Jorge Tibilletti de Lara, pesquisador em estágio pós-doutoral na Fundação Oswaldo Cruz (Fiocruz), no Rio de Janeiro, a partir dos anos 1940 o IOC reorganizou suas prioridades e o foco dos estudos passou a ser os vírus responsáveis por epidemias humanas, como varíola, gripe, sarampo, febre amarela, e a produção de vacinas. A chegada dos antibióticos, vistos como solução mais simples e escalável, completou a mudança de rota.
As pesquisas de Costa Cruz deixaram de integrar a agenda institucional e se perderam no tempo. Essa história foi recentemente reconstituída em razão da curiosidade do biólogo brasileiro Gabriel Almeida, da Universidade do Ártico da Noruega. Apaixonado por história da ciência, ele conta que ouviu, em um congresso, um pesquisador francês mencionar o Brasil como um
dos países que haviam testado fagos no início do século passado. Intrigado, rastreou a referência e, já na Finlândia, decidiu investigar o assunto no pouco tempo livre que tinha no laboratório. Encontrou o obituário de Costa Cruz, localizou as publicações originais do pesquisador e reuniu documentos dispersos em acervos da Fiocruz, da USP, do Instituto Butantan e da Biblioteca Nacional da França, com apoio de bibliotecários que enviavam fotos e cópias de materiais raros. O resultado desse trabalho foi publicado em 2020 na revista científica The Lancet Infectious Diseases. Mais de um século depois, a fagoterapia volta ao debate global, mas o cenário brasileiro é outro. Um levantamento realizado pela infectologista francesa Iris Najjar sobre a pesquisa com bacteriófagos na América do Sul, publicado em 2025 na revista CMI Communications, aponta que o Brasil lidera o volume de publicações na região, mas com uma produção concentrada em áreas como agricultura, alimentos e microbiologia ambiental. Apenas um quinto dos estudos tem foco em aplicações médicas e nenhum caso clínico de uso terapêutico em humanos foi registrado desde a retomada da terapia com fagos. O trabalho também mostra que, embora a infraestrutura científica brasileira seja superior à de outros países latino-americanos, há lacunas importantes, como ausência de ensaios clínicos e pouca pesquisa voltada para patógenos envolvidos em resistência aos antimicrobianos. l
Os artigos científicos consultados para esta reportagem estão listados na versão on-line.
O economista que foi ministro da Fazenda e da Reforma do Estado revê sua trajetória e lembra como implementou suas propostas acadêmicas em Brasília
FABRICIO MARQUES retrato LÉO RAMOS CHAVES
Aos 91 anos, o economista Luiz Carlos Bresser-Pereira segue em franca atividade acadêmica, lecionando na Fundação Getulio Vargas (FGV), em São Paulo, onde trabalha desde 1959, e publicando livros e artigos cujo mote principal é a crítica ao baixo crescimento econômico do Brasil desde a década de 1980. Em anos recentes, ele formulou um modelo teórico, batizado de “novo desenvolvimentismo”, que propõe uma série de medidas macroeconômicas, como o combate à apreciação excessiva do câmbio e à elevação exagerada das taxas de juros, para devolver o fôlego à atividade industrial do país e tirar a economia de um estado crônico que ele classifica como “quase estagnação”.
Em sua trajetória de pesquisador e homem público, Bresser-Pereira teve chances de implementar suas ideias e transformá-las em políticas. Foi ministro da Fazenda durante sete meses, em 1987, em um momento conturbado da economia nos primeiros anos da redemocratização do país, quando a inflação retomou fôlego após o fracasso do Plano Cruzado. Levava na bagagem anos de estudos sobre a inércia que mantinha a inflação em um patamar sempre elevado, mas não teve apoio nem condições políticas para fazer os ajustes que propunha. Já em 1994 teve mais sucesso como ministro da Administração Federal e Reforma do Estado ao criar um arcabouço teórico que abriu caminho, por exemplo, para a criação de organizações sociais, entidades sem fins lucrativos responsáveis por oferecer serviços públicos por meio de contratos de gestão em parceria com o Estado. Em dezembro, ele relembrou sua trajetória em duas conversas com Pesquisa FAPESP.
ESPECIALIDADE
Economia
INSTITUIÇÃO
Fundação Getulio Vargas
FORMAÇÃO
Graduação em Direito (1957) pela Universidade de São Paulo (USP), mestrado em administração de empresas (1961) pela Universidade Estadual de Michigan e doutorado em economia (1972) pela USP

Começando por suas origens, como era sua família?
Era uma família de classe média intelectualizada. Meus avós maternos eram p rofessores. Tem escolas com o nome do meu avô aqui em São Paulo, Alfredo Bresser. Meu avô paterno era advogado. Eram todos paulistanos. Fiz a Faculdade de Direito da USP [Universidade de São P aulo]. Queria ser juiz de direito, mas mudei de ideia no terceiro ano da faculdade. Li a revista Cadernos do Nosso Te mpo, publicada pelos intelectuais que formariam em seguida o Iseb [Instituto Superior de Estudos Brasileiros]. Eram todos nacionalistas desenvolvimentistas e admiradores de Getúlio Vargas. Fiquei fascinado e descobri que o Brasil, após a Independência em 1822, tinha se tornado uma semicolônia e que a nação só começou a ganhar força nos anos 1930 com os tenentes e o movimento que o Getúlio representou. Quando terminei a leitura da revista, resolvi que ia ser sociólogo ou economista do desenvolvimento.
Mas concluiu o curso de direito… Terminei a faculdade, mas com o propósito de não trabalhar na área. Não conhecia ninguém na sociologia ou na economia da USP, que eram as duas áreas que me interessavam. Eu trabalhava desde os 16 anos como jornalista. Primeiro no jornal do meu pai, Sylvio Gonçalves Pereira, que foi um advogado bem-sucedido, eleito deputado estadual na Constituinte de 1947. Mas não foi reeleito e aí criou um jornal, O Tempo. Pagou dívidas durante 15 anos depois que o jornal faliu. Trabalhei como repórter, copidesque e crítico de cinema. Quando o jornal fechou em 1955, consegui um emprego no Última Hora. Mas não pagavam direito. Já estava casado e fui trabalhar em publicidade, enquanto procurava uma oportunidade em economia ou sociologia. Surgiu uma na FGV, depois de várias tentativas.
Era para ser professor na FGV? De administração de empresas. Fui aprovado em um concurso. Fiquei um ano no Brasil me preparando, com uma missão norte-americana, para passar um a no e meio nos Estados Unidos fazendo mestrado. Como ninguém sabia muito de administração de empresas naquela época, do ponto de vista teórico, a fundação criou um programa de formação
e m combinação com a Usaid [Agência dos Estados Unidos para o Desenvolvimento Internacional] e a Universidade Estadual de Michigan – depois também entrou, secundariamente, a Universidade Harvard. Era preciso fazer um paper para conseguir participar. Escrevi um artigo intitulado “The rise of middle class and middle management in Brazil”. Embarquei para os Estados Unidos em 1960. Q uando cheguei lá, mostrei o paper para um professor de macroeconomia e ele recomendou que eu mandasse para uma revista. Foi publicado. Fiquei um ano em Michigan e deu tempo para ir a Harvard, em um programa de formação de professores. Voltei para o Brasil e fui ser professor de administração de empresas na FG V. Em 1970, mudei para o Departamento de Economia. Antes, eu tinha sido admitido na USP para fazer o doutorado em economia com orientação do Delfim Netto [1928-2024], que concluí em 1972.
Antes do Delfim, o senhor chegou a procurar o Florestan Fernandes [1920-1995], não foi?
Sim. Cheguei dos Estados Unidos em setembro de 1962. Em outubro, bati à porta do Florestan. Ele me recebeu, mas não
deu a menor bola. Em janeiro de 1963, a Unesco organizou na USP, coordenado pelo Delfim, um seminário em que ele trouxe alguns grandes economistas. Fiquei muito interessado e, no final da reunião, procurei o Delfim e perguntei se ele podia me aceitar para o doutorado. Ele aceitou. Depois ele foi para o governo e, quando defendi o doutorado, a orientadora foi a professora Diva Benevides Pinho.
Paralelamente, o senhor se tornou um executivo do grupo Pão de Açúcar. Como conciliou a carreira acadêmica com a corporativa?
O salário na FGV era baixo e, ainda que se falasse que era trabalho de tempo integral, todo mundo tinha outra atividade. Conheci o Abílio Diniz, que tinha sido colega do meu irmão na FGV. Ele e o pai me convidaram para trabalhar. Aceitei, mas meio período. Logo me tornei diretor do Pão de Açúcar. Ajudei a inaugurar a loja número 2. Quando saí para trabalhar no governo de São Paulo, no início dos anos 1980, tinha 400 lojas e era a maior rede de supermercados da América Latina. O Abílio era um grande empresário. Eu era o administrador. Fazíamos uma boa dupla. Mas o meu objetivo principal sempre foi a vida acadêmica.
Quando publicou seu primeiro livro?
Me perguntaram por que aceitei ser ministro da Fazenda naquela circunstância. Respondi que eu havia sido treinado para isso
Eu tinha começado com aquele paper, que é o embrião da teoria sobre a tecnoburocracia ou classe gerencial que eu iria desenvolver nos anos 1970. Quando voltei ao Brasil, conduzi duas pesquisas, uma sobre as origens étnicas dos empresários, outra sobre as origens étnicas e sociais de dirigentes de empresas, e comecei a escrever artigos. Em 1968, eu juntei alguns dos papers, organizei um livro chamado Desenvolvimento e crise no Brasil. A primeira edição, feita pela editora Zahar, esgotou. Aí veio o Ato Institucional nº 5 e a Zahar avisou que não podia publicar uma reimpressão. Mais tarde, a Brasiliense mostrou interesse. Publiquei lá a segunda edição e muitas outras.
Que ideias amadureceu ali?
A defesa do desenvolvimentismo. O Roberto Campos [1917-2001], que tinha sido m inistro do Planejamento do governo Castelo Branco, não gostou do livro e foi reclamar na FGV. O diretor da escola me defendeu firmemente. O Roberto Campos
me convidou para um debate público. Eu topei. Mas ele pensou melhor, me convidou para almoçar e trouxe um exemplar todo anotado. Ele era um homem muito inteligente e discutimos amavelmente.
Qual era o problema?
Era a crítica ao ajuste feito pelo Roberto Campos quando assumiu o ministério. Hoje, acho que ele tinha mais razão que eu, porque era mesmo necessário fazer um ajuste. O Juscelino [Kubitschek, 1902-1976] tinha desorganizado as finanças públicas com a construção de Brasília. O Jânio não tinha ajudado e o Jango não teve chance de fazer nada, porque não o deixaram governar. Então, era preciso um ajuste. O Roberto Campos e o Octávio Bulhões [1906-1990], que era o ministro da Fazenda, fizeram. Para um desenvolvimentista como eu, o ajuste era incômodo. Naquela época, eu estava escrevendo coisas bem diferentes, um ensaio sobre a revolução estudantil e outro, mais importante para mim, sobre a revolução política na Igreja Católica, a partir da reunião dos bispos em Medellín, na Colômbia, em 1968. Os dois livros escrevi a convite da editora Vozes.
Do que tratava o seu trabalho sobre tecnoburocracia?
Em 1972, resolvi fazer um ensaio sobre isso, chamado “Emergência da tecnoburocracia”, e me propus a apresentá-lo no Cebrap [Centro Brasileiro de Análise e Planejamento]. O Chico de Oliveira [1933-2019], que era marxista, disse: “Mas, se você tem uma nova classe social, qual é a relação de produção correspondente?”. Levei um susto e respondi: “Não sei”. Passei cinco anos com aquilo na cabeça, até que encontrei uma resposta. Escrevi em um ensaio chamado “Notas introdutórias ao modo tecnoburocrático ou estatal de produção”. E qual era a resposta? A nova relação de produção era a propriedade coletiva dos meios de produção por tecnoburocratas, gerentes privados e públicos. Na Rússia, a revolução não conseguiu ser socialista porque os trabalhadores não tinham condições de dirigir as empresas e o governo. Rapidamente, a revolução deslizou para um sistema tecnoburocrático estatal. Em 1981, publiquei o livro A sociedade estatal e a tecnoburocracia, em que reuni os trabalhos sobre esse tema.
não deu crescimento nenhum
Nos anos 1980, o senhor se notabilizou por estudos sobre a inflação. Como enveredou para esse tema?
Chegamos em 1980 e entramos na crise. Primeiro a da dívida externa, encadeada com a da inflação inercial. Escrevemos, o economista Yoshiaki Nakano e eu, um primeiro paper em 1980, publicado na minha revista, a Revista de Economia Política , que nasceu em 1981. Hoje, ela é a revista brasileira de economia que tem mais citações. Agora passei a revista para a FGV, mas continuo sendo o editor.
Como formulou a teoria da inflação inercial?
Mostrei que a inflação se mantinha porque, supondo-se três empresas, A, B e C, a primeira aumentava os seus preços em 10% no começo do mês; a segunda aumentava em 10% no dia 10; a terceira fazia o mesmo no dia 20, e ninguém sabia quem tinha começado a brincadeira. Quando chegava no primeiro dia do mês seguinte, a empresa A voltava a aumentar seus preços em 10%, de forma que a inflação continuava em 10% independentemente de demanda. Nakano e eu começamos a escrever alguns artigos
sobre esse assunto. O primeiro e o mais importante chamou-se “Fatores aceleradores, mantenedores e sancionadores da inflação”. A teoria da inflação inercial está descrita no título. O acelerador era um choque qualquer que levava a um aumento de preços. O fator mantenedor era esse processo de indexação formal e informal da economia: todos aumentavam os preços de acordo com a taxa de inflação vigente. Finalmente, o fator sancionador era a quantidade de moeda, que precisava aumentar para que a liquidez do sistema não diminuísse e impedisse que fossem realizadas as trocas. O livro Inflação e recessão, meu e do Nakano, com todos os nossos papers, saiu no final de 1984. Nesse momento eu tinha sido convidado pelo governador de São Paulo Franco Montoro [1916-1999] para presidir o Banespa.
Sua vida pública começa no governo Montoro?
Sim, em 1983 no Banespa. Em 1985, me tornei secretário de governo do Franco Montoro, em uma atividade completamente política. O Montoro era um homem extraordinário, de um idealismo imenso. Passei brevemente pela Secretaria da Ciência e Tecnologia do Estado de São Paulo no governo Orestes Quércia [1938-2010]. E aí o José Sarney me convidou para ser ministro da Fazenda.
Foi uma experiência curta, que gerou um plano que não conseguiu estabilizar a inflação após o fracasso do Plano Cruzado. Como foi?
Naqueles sete meses, trabalhei de forma absolutamente desesperada. A crise era muito grande. A inflação caminhava para 20% ao mês. Os salários, que tinham subido no cruzado, caíram. As empresas e os estados estavam quebrando. Me perguntaram por que aceitei ser ministro da Fazenda naquela circunstância. Respondi que eu havia sido treinado para isso. E que tinha a obrigação de aceitar. Defini dois objetivos fundamentais: resolver o problema da dívida externa e o da inflação.
Por que o Plano Bresser não vingou?
Propus um ajuste, que chamei de Plano de Controle Macroeconômico. Era um plano bem heterodoxo, mas envolvia um ajuste fiscal forte e a renegociação da dí-
vida externa. Eu sabia que as chances de êxito eram pequenas, porque os preços relativos estavam desequilibrados. Eles evoluíram rapidamente de uma situação de estabilidade para um alto crescimento, sem a calma necessária para que se acomodassem em um novo nível. Em pouco tempo, percebi que o FMI [Fundo Monetário Internacional] não tinha condições de me dar apoio, porque o Sarney resolveu, um mês depois que eu assumi, que queria ficar mais um ano no governo e propôs um mandato de cinco anos. Aí ele ficou nas mãos do Centrão, que, aliás, despontou na Constituinte. O Plano Bresser foi fracassando. Eu estava preparando com o Nakano, meu secretário de Política Econômica, um novo plano que seria não de congelamento, mas baseado no uso da ORTN [Obrigação Reajustável do Tesouro Nacional] como referência de valor estável em meio à desvalorização da moeda. O modelo seria adotado depois no real, com a URV [Unidade Real de Valor]. Ao mesmo tempo, eu estava às voltas com a dívida externa. O Brasil estava em moratória, declarada pelo meu antecessor, o Dilson Funaro [1933-1989].
O senhor propôs uma solução de securitização da dívida, que acabou vingando mais tarde. Como teve a ideia?
Eu queria ter uma solução para a dívida externa que permitisse ao Brasil voltar a crescer. Um dia, o economista Roberto Giannetti da Fonseca me disse: “Soube que, em Nova York, um financista norte-americano, chamado Felix Rohatyn [1928-2019], resolveu a crise financeira radical com uma securitização”. “O que é isso?”, perguntei. “Trocaram os contratos de empréstimo dos bancos por títulos lançados no mercado”, ele me disse. Não tinha entendido bem, mas falei: é o que vou fazer. Eu estava pronto para apresentar o meu plano na reunião do FMI e do Banco Mundial, que aconteceria em setembro de 1987. Aí o Sarney vazou a notícia. Ele não tinha entendido bem do que se tratava, mas contou para jornalistas, que publicaram na Folha de S.Paulo. No dia seguinte, o plano começou a ser atacado com reportagens e artigos violentos.
E aí levou o plano aos credores… Cheguei a Washington no dia 7 ou 8 de setembro para falar com o secretário do Tesouro, James Baker. Ele me recebeu re-
servadamente por uma hora. Apresentei o plano e, quando disse que a ideia era fazer uma securitização obrigatória, ele respondeu que isso era um non-starter [inviável]. Expliquei que não era o mais importante, podia ser facultativo, mas era essencial que o governo norte-americano estivesse de acordo. E pedi que houvesse um acoplamento entre o FMI e os bancos comerciais. Porque toda vez que eu queria negociar com os bancos, eles diziam que primeiro tinha que falar com o FMI. E o FMI dizia que primeiro tinha que falar com os bancos. O Baker concordou. Depois fomos para uma reunião com assessores. Dois assessores dele se opuseram ferozmente. Entendi que estava aprovado, já que o que vale é a palavra do ministro. Combinamos que eu falaria para a imprensa. Desci as escadarias do Tesouro, os jornalistas estavam lá embaixo. Expliquei tudo. E fui almoçar na embaixada. Lá, fui informado de que o Baker estava furioso, porque a Reuters tinha dado uma notícia falsa. Telefonei para o Baker. Ele falou: “Não se preocupe, já dei uma nota para a imprensa”. Voltei para o Brasil e só vi a nota quando cheguei ao Rio: “Baker disse que o plano do Brasil é um non-starter ”. Quinze dias de-
pois, voltei aos Estados Unidos. Antes de ir a Washington, tive um almoço em Nova York com os ministros da fazenda da A rgentina e do México. Quando cheguei ao restaurante, um jornalista do Estado de S. Paulo me disse: “Ministro, mudou tudo nesses últimos 15 dias. Só se fala no seu projeto”. O Nicholas Brady assumiu a Secretaria do Tesouro em 1989 e propôs o Plano Brady para a dívida de países latino-americanos, que era o meu plano.
O senhor deixou o ministério no final de 1987. Por quê?
Foi ficando claro que eu não ia conseguir fazer o segundo plano. O Sarney não tinha condições de me apoiar. Alguns dias depois, fiz uma proposta para estabelecer o pagamento de impostos sobre os dividendos e o Sarney recusou. Resolvi me demitir. No final do governo, tínhamos hiperinflação: 80% ao mês.
No retorno à vida acadêmica, por quais temas se interessou?
Propus a reforma do aparelho do Estado e da gestão pública. Montei toda a estrutura teórica.
Foi um grande experimento
Fiz um paper sobre a virada na dívida externa e escrevi um livro chamado A crise do Estado. No final de 1988, participei de uma reunião na Unicamp [Universidade Estadual de Campinas] sobre o socialismo. Estava no fundo da plateia o cientista político Adam Przeworski, que eu não conhecia, e gritou: “Não é a transição para o socialismo que vocês têm que discutir aqui, é a transição para o capitalismo”. Era o que estava acontecendo na Polônia, onde ele nasceu. Pouco depois, nos anos 1990, ele me convidou para participar de um projeto de pesquisa para discutir as reformas econômicas em um conjunto de países que viveram transições para a democracia nos anos 1970 e 1980, começando por Portugal e Espanha.
O senhor voltaria a Brasília para ocupar o Ministério da Administração Federal e Reforma do Estado no governo Fernando Henrique, fora da área econômica. O senhor é apontado em estudos como um “empreendedor de políticas públicas” por ter levado adiante uma reforma no aparelho do Estado. Como foi a experiência? No começo do governo, houve reuniões de ministério na Granja do Torto. Perguntei ao Fernando Henrique qual era a estratégia de desenvolvimento. Ele disse que era crescer com poupança externa.
Não fiquei convencido. Nos oito anos do governo, o crescimento foi baixo. Felizmente, eu estava no Ministério da Administração Federal e lá eu fiz uma festa. Propus a reforma do aparelho do Estado e da gestão pública. Montei uma estrutura teórica. Os servidores ficaram com medo, porque falei que queria terminar com a estabilidade total. Queria e acabei, teoricamente. Achava aquele tipo de estabilidade desmoralizante para eles, na grande maioria pessoas competentes. Logo perceberam que eu estava a favor deles. Foi um grande experimento.
Quais foram as mudanças principais?
A mudança principal era uma nova visão da estrutura do Estado e da sociedade e do Estado na sociedade. Eu dizia que havia diversas formas de propriedade. Havia a propriedade estatal, a propriedade pública não estatal, a propriedade coletiva, ou de clube. E havia a propriedade privada. Na propriedade estatal, o Estado era dono de tudo. A propriedade pública não estatal era voltada para o interesse público, mas não era necessariamente estatal, podia também ser privada. Propus que instâncias do setor público que antes eram estatais virassem organizações sociais, entidades sem fins lucrativos que assinavam contratos de gestão com o Estado, com definição de metas, e recebiam financiamento público. Gradualmente, seus funcionários deveriam entrar para o regime de CLT.
O senhor também teve uma passagem pelo Ministério da Ciência e Tecnologia. Conseguiu fazer algo marcante? Empresas como a Petrobras tinham fundos para investir em pesquisa. Quem sabia disso era o meu vice-ministro, o Carlos Américo Pacheco. Vi que havia uma chance para criar fundos ligados a setores da economia para financiar a pesquisa. Estava fazendo um plano quando o Fernando Henrique me demitiu, em uma reforma ministerial. Retornei à vida acadêmica, jurando que não voltaria para cargos políticos ou administrativos.
E então o senhor propôs a teoria do novo desenvolvimentismo. Quais são as bases?
Nos anos 1980, o Brasil ficou completamente estagnado e, nos anos 1990, quando se esperava um grande crescimento
A
dominante não é mais de empresários, que inovam e se arriscam, mas de rentistas, que vivem do trabalho alheio
no governo do Fernando Henrique, o país cresceu em nível baixo. Fiz um paper sobre isso, “Incompetence and confidence building behind 20 years of quasi-stagnation in Latin America”, mas continuei a pensar. Lembrei que o Fernando Henrique disse que a estratégia era crescer com poupança externa. Significa crescer com déficit em conta corrente financiado pela poupança dos outros. Isso não deu crescimento nenhum. Desenvolvi o primeiro modelo do novo desenvolvimentismo, que foi a crítica do crescimento com poupança externa. O argumento era que, quando se tem déficit em conta corrente, entra mais capital do que sai. A taxa de câmbio tende a se apreciar e as empresas nacionais deixavam de ser capazes de enfrentar a concorrência de bens importados e eram substituídas pela indústria estrangeira. Em 2006, escrevi um artigo mostrando que, para sair da quase estagnação, era preciso um novo desenvolvimentismo que envolvesse uma macroeconomia do desenvolvimento, apoiada na taxa de câmbio e na taxa de juros. Escrevi dois artigos com o Nakano na época. Em 2008, fiz um artigo sobre a chamada doença holandesa. A expressão
foi inventada pela revista The Economist em 1973, em uma reportagem que relembrava o que tinha acontecido nos Países Baixos nos anos 1960: a exploração de gás e petróleo tinha apreciado tanto o florim que quase acabou com a indústria holandesa. A doença holandesa acontece quando há um boom de commodities que o país exporta, mas depois acaba. No boom de commodities, a taxa de câmbio se aprecia fortemente, especialmente a aplicada à indústria. A taxa de câmbio para a agricultura é apreciada, mas os preços das commodities também aumentam. Uma coisa compensa a outra e ainda sobra para o agronegócio. Para a indústria, só tem o efeito ruim do câmbio. Eu entendo que existe um equilíbrio mais depreciado da moeda que interessa só à indústria, uma taxa de câmbio que torna satisfatória a taxa de lucros das empresas diante da doença holandesa. Em 2024, publiquei o livro Novo desenvolvimentismo – Introduzindo uma nova teoria econômica e economia política, que tem a teoria toda.
E esse foi o seu livro mais recente? Não, tem outros dois ainda. Fiz um com propostas em relação à taxa de juros e à taxa de câmbio chamado Um projeto para o Brasil contra a quase-estagnação, que saiu recentemente. Passei cinco anos escrevendo um livro sobre o capitalismo. Em 2025, ele foi publicado pela Oxford University Press. Chama-se The rise and fall of neoliberal rentier capitalism. Nesse livro, afirmo que, no neoliberalismo, a classe dominante não é mais de empresários, mas de rentistas, ou dos filhos dos empresários ou pessoas que ganharam dinheiro de outras formas, às vezes não muito honestas. Vivem do trabalho alheio, diferentemente dos empresários, que inovam e se arriscam.
Ainda dá aulas na FGV?
Em 2024, disse para o diretor da escola que queria me aposentar. Ele falou que não queria de jeito nenhum. Creio que há um interesse, inclusive prático, que eu permaneça. Meus papers rendem pontos na avaliação de programas de pós-graduação. Eu dava dois cursos por ano. Passei a dar só um curso de dois meses e meio, chamado Estado, Capitalismo e Democracia, com um jovem professor, Alexandre Abdal, e estamos transformando as aulas num livro. l
AP – Fapeap
AC – Fapac
RO – Fapero
RR – FAPERR
RN – Fapern
TO – FAPT
SE – Fapitec
PI – Fapepi
MT – Fapemat
MS – Fundect
PA – Fapespa
AL – Fapeal
BA – Fapesb
PB – Fapesq
RS – Fapergs
GO – Fapeg
MA – Fapema
DF – FAPDF
PE – Facepe
AM – Fapeam
ES – Fapes
PR – Araucária
CE – Funcap
SC – Fapesc
MG – Fapemig
RJ – Faperj
SP – FAPESP
Painel aponta aumento dos recursos orçamentários das fundações estaduais de apoio à pesquisa em meio a oscilações de investimentos federais FABRÍCIO
Um levantamento produzido pelo Centro de Estudos Sociedade, Universidade e Ciência (SoU_Ciência) indica que, entre 2018 e 2024, os orçamentos do conjunto das 27 Fundações Estaduais de Amparo à Pesquisa (FAP) cresceram de modo consistente, o que ajudou a compensar as oscilações na capacidade de financiamento das principais agências de fomento à ciência do governo federal. Os dados, corrigidos pela inflação, mostram que o conjunto das FAP, que obtêm seus recursos orçamentários da arrecadação de impostos dos respectivos estados, dispôs de R$ 4,9 bilhões em 2024 – ante um patamar na casa dos R$ 3,5 bilhões entre 2018 e 2021. Já o Conselho Nacional de Desenvolvimento Científico e Tecnológico (CNPq), principal agência federal de apoio à ciência, e a Coordenação de Aperfeiçoamento de Pessoal de Nível Superior (Capes), que tem um papel importante no financiamento de bolsas em programas de pós-graduação, tiveram perdas orçamentárias fortes entre 2018 e 2022 e experimentaram uma recupe -
Os investimentos de cada estado
Orçamento das FAP – por unidade da federação (2024)
ração em 2023. Mas o crescimento não se repetiu em 2024 e houve até alguma perda de fôlego (ver gráfico abaixo).
“As fundações estaduais vêm ganhando importância no financiamento à pesquisa, o que é uma boa notícia p ara a ciência brasileira. Mas não se deve perder de vista que há uma demanda crescente por investimentos em b olsas e projetos, que requerem uma estruturação contínua das fundações e uma recuperação mais consistente do orçamento das agências federais”, diz a pesquisadora da Escola Paulista de Medicina Soraya Smaili, reitora d a Universidade Federal de São Paulo (Unifesp) entre 2013 e 2021 e coordenadora-geral do SoU_Ciência, órgão c omplementar da Unifesp responsável por analisar políticas e modos de f inanciamento da educação superior e da ciência. O levantamento sobre as FAP, disponível no endereço souciencia. unifesp.br/dados-fctesp/faps, é o segundo painel de investimentos produzido pelo SoU_Ciência. Anteriormente, a instituição divulgou um estudo semelhante sobre os orçamentos das universidades e institutos de pesquisa federais.
Ainda há grande desigualdade regional no investimento dos estados em suas FAP. A FAPESP, que é a mais antiga fundação do sistema, com 63 anos de atividades, teve uma receita orçamentária de R$ 2,8 bilhões em 2024, o equivalente a 57% dos recursos do conjunto das fundações em 2024. Conforme estabelece a Constituição do estado de São Paulo de 1989, a FAPESP recebe 1% da arrecadação estadual de impostos – o índice médio das FAP brasileiras, segundo o levantamento do SoU_Ciência, é de 0,51% da arrecadação tributária estadual. Outros destaques são as fundações do Rio de Janeiro (orçamento de R$ 647 milhões em 2024), de Minas Gerais (R$ 552 milhões) e de Santa Catarina (R$ 306 milhões). Já as com menor patamar de financiamento são as do Acre e do Amapá, cada qual na casa dos R$ 7 milhões em 2024. Elas estão entre as mais recentes do sistema, criadas apenas na década passada.
Não há um critério uniforme para os investimentos das fundações. Algumas delas, como a FAPESP, concentram investimentos em bolsas e projetos de pesquisa e destinam apenas 5% para suas despesas administrativas. Mas isso varia muito: há
Evolução dos investimentos do conjunto das fundações estaduais e de duas agências federais
instituições que também se encarregam de manter a estrutura de órgãos e instituições ligados à ciência na administração estadual e de pagar seus servidores. A destinação dos investimentos das FAP é orientada por demandas regionais. “Os estados se organizaram para criar estratégias locais relacionadas a ciência, tecnologia e inovação e apoiá-las”, diz Márcio de A raújo Pereira, que até dezembro presidia o Conselho Nacional das Fundações Estaduais de Amparo à Pesquisa (Confap).
“Fundações como a do Espírito Santo e de Minas Gerais vêm se dedicando também a investir nos ecossistemas locais de inovação, enquanto as do Centro-Oeste têm vocação especial para fomentar ciência com impacto no agronegócio”, explica. Os temas de maior interesse são variados. “Em Goiás, a fundação estadual investiu recentemente na criação de centros de referência em inteligência artificial, enquanto a da Paraíba investiu em computação quântica e as da região Norte em bioeconomia”, afirma Pereira, que entre 2020 e 2025 foi diretor-presidente da Fundação de Apoio ao Desenvolvimento do Ensino, Ciência e Tecnologia de Mato Grosso do Sul.
Opresidente do CNPq, o físico Olival Freire Jr., destaca que o crescimento do orçamento das FAP é saudável. “ E há algumas fundações em fase de consolidação que têm bastante espaço para crescer. Ao menos oito delas ainda não oferecem bolsas de mestrado e de doutorado”, afirma. Em relação aos recursos do CNPq, Freire Jr. observa que o orçamento executado de 2024, que inclui recursos de parceiros externos e emendas parlamentares, foi praticamente igual, em valores nominais, ao de 2023 – na casa dos R$ 2,9 bilhões. Em 2025 houve uma recuperação dos valores. “Além do orçamento aprovado, o CNPq conta com recursos
do Fundo Nacional de Desenvolvimento Científico e Tecnológico e do Ministério da Saúde”, afirma.
Odiretor científico da FAPESP, Marcio de Castro Silva Filho, destaca a necessidade de as agências federais ampliarem seus investimentos a fim de que o sistema brasileiro de ciência, tecnologia e inovação opere de forma mais equânime e eficiente. “Temos hoje mais de 25 mil doutores formados por ano no país, mas a quantidade de bolsas federais para pós-doutores é restrita, o que limita a evolução da carreira desses pesquisadores. A FAPESP financia atualmente 2,2 mil bolsas de pós-doc. A maioria dos estados não consegue fazer esse tipo de investimento”, exemplifica.
Ele lembra que a diminuição dos recursos das agências federais nos últimos 2 0 anos fez com que elas focalizassem sua ação na oferta de bolsas, investindo proporcionalmente cada vez menos em projetos de pesquisa. A redução foi apenas parcialmente compensada pelo aumento
de recursos em 2023 e seria preciso um esforço maior para combater as desigualdades do sistema. “Ainda há uma concentração forte dos esforços de pesquisa do país em São Paulo, que decorre de uma política de Estado segundo a qual as universidades estaduais têm autonomia administrativa, são mantidas com um percentual da arrecadação de impostos e há investimentos contínuos e regulares em pesquisa promovidos pela FAPESP”, afirma. Essa desigualdade se expressa em indicadores como a presença de autores de instituições paulistas em 42% d a produção científica brasileira ou na liderança de São Paulo no Índice Brasil de Inovação e Desenvolvimento, de 0,87 em uma escala que vai de 0 a 1, desempenho três vezes superior à média nacional – o indicador é produzido pelo Instituto Nacional da Propriedade Industrial (INPI). “A excelência científica está presente em todas as unidades da federação e é preciso investimento regular para aproveitá-la de forma equilibrada”, diz.
As perspectivas de mudança desse panorama não são muito favoráveis no curto prazo. Os investimentos federais em ciência, tecnologia e inovação sofre-
Investimentos em infraestrutura e bens duráveis nas universidades federais – em R$ corrigidos em 2025
ram cortes na lei orçamentária aprovada pelo Congresso em dezembro, embora o governo tenha anunciado em janeiro medidas para recompor os valores. O orçamento da Capes, ligada ao Ministério da Educação (MEC), chegou a perder R$ 359,3 milhões e o do CNPq, vinculado ao Ministério da Ciência, Tecnologia e Inovação (MCTI), R$ 92,4 milhões, em relação aos montantes que o governo havia proposto ao Parlamento. A redução nos recursos disponíveis chegou a 7% em termos reais, na comparação com 2025. “Nossas preocupações se concentraram nos cortes em bolsas, especialmente porque os valores que constavam no orçamento enviado ao Congresso já estavam abaixo das necessidades da agência”, explica Freire Jr.
Uma nota divulgada no final de dezembro pela Sociedade Brasileira para o Progresso da Ciência (SBPC) e pela Academia Brasileira de Ciências (ABC) apontou como “particularmente grave” a situação da Capes, com impacto na oferta de bolsas. “O orçamento aprovado implica perda real de capacidade de financiamento da pós-graduação brasileira, afetando tanto o ensino superior quanto a formação de professores da educação básica”, informa a nota. As universidades federais igualmente foram alvo de cortes e perderam R$ 488 milhões em seus recursos discricionários, aqueles que são aplicados no funcionamento das instituições, na manutenção da infraestrutura e na assistência estudantil. A verba prevista pelo governo era de R$ 6,89 bilhões, mas caiu para R$ 6,43 bilhões no texto aprovado pelo Congresso.
No final de janeiro, o governo federal anunciou a abertura de um crédito complementar de R$ 1,36 bilhão para reforçar os orçamentos do MEC e MCTI em 2026. O pacote foi lançado para evitar que as perdas impostas na tramitação da lei orçamentária comprometam o pagamento de bolsas e o funcionamento das universidades neste ano. l

Capes amplia acordos com editoras e autores brasileiros passam a ter isenção de taxas em milhares de periódicos
SARAH SCHMIDT
Desde janeiro, pesquisadores do país podem publicar trabalhos científicos em acesso aberto sem pagar pelas taxas de processamento de artigos em 1.738 revistas científicas da editora Springer Nature e 1.619 da Elsevier. Um contrato nos mesmos moldes, que engloba a coleção completa da Association for Computing Machinery (ACM), começou em dezembro. O arranjo faz parte de um acordo estabelecido entre a Coordenação de Aperfeiçoamento de Pessoal de Nível Superior (Capes) e as três editoras e prevê um custo total de R$ 1 bilhão por três anos. A versão anterior desses contratos era R$ 70 milhões por ano mais barata, mas garantia apenas o direito à leitura de artigos por meio do Portal de Periódicos da Capes, biblioteca digital que dá aos
pesquisadores do país acesso a artigos e outros documentos científicos. A novidade é incluir no mesmo pacote também o custo de taxas de publicação. A expectativa é de que sejam publicados 6 mil artigos nos periódicos da Springer, 12 mil na Elsevier e 600 artigos na ACM por ano, ampliando a quantidade de papers em acesso aberto escritos por autores brasileiros nessas revistas. No caso da Springer e Elsevier, o convênio é válido apenas para títulos que adotam o chamado modelo híbrido, no qual as revistas, embora cobrem assinaturas, abrem a possibilidade de publicação de estudos em acesso aberto se os autores desembolsarem uma taxa. Agora, pesquisadores brasileiros não precisarão pagar nada. Não há limite para o número de papers a serem publicados, mas alguns títulos importantes estão fora do acordo, como as da coleção Nature, disponíveis apenas para leitura. Segundo a Capes, atualmente a editora não contempla a publicação ilimitada nas revistas da marca Nature nesse tipo de acordo, e o volume de artigos de autores brasileiros nesses títulos ainda é reduzido.
Convênios d esse tipo – celebrados pelas editoras com consórcios de bibliotecas, universidades e instituições de pesquisa – são chamados de acordos transformativos e surgiram com o objetivo de promover u ma transição gradual dos periódicos que cobram por assinatura para modelos de acesso aberto total. Por meio deles, os recursos que eram utilizados com o pagamento de assinaturas são transferidos para o pagamento de taxas de publicação de artigos de seus pesquisadores em revistas que se comprometem a ampliar progressivamente suas atividades em acesso aberto. Essa estratégia vem sendo impulsionada no exterior desde 2021 com o advento do Plano S, iniciativa para expandir o acesso aberto na comunicação científica criada por instituições de fomento à pesquisa de 17 países, na maioria europeus.
“Além da possibilidade de ler e de publicar, o acordo inclui o acesso a ferramentas de inteligência artificial [IA] generativa que pesquisadores nos relataram ser úteis, como o Scopus IA e Science Direct IA”, explica a economista Andrea Vieira, coordenadora do Portal de Periódicos da Capes e responsável por liderar as negociações. Essas ferramentas podem auxiliar em funções como identificar temas emergentes de pesquisa e oferecer buscas em conteúdo de base científica, entre outras finalidades. A negociação durou dois anos. “O mais desafiador foi conseguir o direito de publicar de maneira ilimitada. Até onde sabemos, a Springer Nature ainda não havia feito
nenhum convênio sem um limite preestabelecido com essa amplitude”, ressalta Vieira.
A presidente da Capes, Denise Pires de Carvalho, destaca que a agência tem procurado nacionalizar esses contratos principalmente porque as instituições sozinhas enfrentam dificuldades para negociar os custos de publicação. “Garantimos equidade de acesso, já que as instituições do país trabalham com condições e tempos diferentes de produção acadêmica”, observa. A agência, que remunerava as editoras a fim de oferecer seus artigos no Portal de Periódicos, estava em condição favorável para barganhar a incorporação nos contratos dos custos de publicação. Convênios semelhantes já haviam sido estabelecidos anteriormente. O primeiro deles foi realizado com a American Chemical Society (ACS) e passou a vigorar em maio de 2024. Depois vieram os acordos com o Institute of Electrical and Electronics Engineers (IEEE), a Wiley e a Royal Society Publishing (RSP).
De maio de 2024 a novembro de 2025, segundo dados do Painel APC da Capes, foram publicados

Editoras com as quais o país tem acordos vigentes
EDITORA
Springer Nature
Elsevier
Wiley
Institute of Electrical and Electronics Engineers (IEEE)
American Chemical Society (ACS)
Association for Computing Machinery (ACM)
Royal Society Publishing (RSP)


três anos
4.105 artigos com autores correspondentes brasileiros em periódicos dessas quatro editoras. Segundo a agência, em 2025, os acordos com ACS, IEEE e Wiley trouxeram uma economia de cerca de US$ 13 milhões em taxas de publicação que deixaram de ser pagas pelos pesquisadores.
DE OLHO NAS REGRAS Pesquisadores vinculados às 452 instituições que têm acesso ao Portal de Periódicos – que completou 25 anos em dezembro – poderão usufruir do benefício, incluindo alunos de pós-graduação. No entanto, o número de instituições elegíveis para cada contrato pode variar dependendo da editora. É preciso conferir os detalhes na página de acordos transformativos da Capes. “O principal meio de identificação da vinculação do pesquisador para a liberação do benefício é o seu cadastro na Plataforma Sucupira”, diz Vieira, referindo-se ao banco de dados mantido pela Capes que fornece informações sobre os programas de pós-graduação brasileiros. “Por isso, é importante que ele mantenha seus dados atualizados.” Quando um pesquisador tem seu artigo aceito para publicação em um periódico, a isenção do pagamento deve ocorrer de maneira automática dentro da plataforma das editoras, depois da validação de seu vínculo com a instituição de pesquisa. A bioquímica Alicia Kowaltowski, do Instituto de Química da Universidade de São Paulo (USP), que estuda o modelo de acesso aberto, já foi beneficiada por um acordo desse tipo celebrado com a editora Wiley. “Fiz uma publicação em 2025 e foi tudo automático. Após indicar o país de origem e selecionar o contrato da Capes, a publicação foi liberada.” A pesquisadora alerta, no entanto, que assim como nos acordos da Elsevier e da Springer Nature, o da Wiley também contempla somente os periódicos híbridos. Já os convênios com a ACM, ACS e a Royal Society incluem tanto revistas híbridas quanto as que já são totalmente de acesso aberto. Kowaltowski sugere que os pesquisadores estejam atentos aos detalhes dos convênios de cada uma das editoras. “Isso é fundamental para que o cientista não tenha uma surpresa ao descobrir depois que algo não pode ser coberto.”
Vieira, da Capes, alerta para a importância de checar as regras de submissão de cada revista. Is-
so porque há publicações que cobram, por exemplo, taxas extras para divulgar figuras coloridas ou um número maior de páginas. “Os acordos estabelecidos pela Capes cobrem apenas o custo de processamento. Qualquer taxa extra será enviada pela editora ao pesquisador.” Segundo ela, a escolha dos periódicos que integram os acordos é feita com base em demandas das universidades, seguindo critérios que já eram adotados nos contratos de leitura do portal de periódicos. “Avaliamos o perfil da revista, se está indexada e, em casos de solicitações de coleções completas, analisamos se o portfólio é abrangente.”
Para Abel Packer, coordenador da biblioteca eletrônica SciELO, pioneira em acesso aberto, a medida é importante e chega em um momento em que a Capes tem apoiado a ciência aberta como uma política institucional. Uma das iniciativas destacadas por ele foi o movimento de nacionalizar a SciELO, criada pela FAPESP em 1997. Em agosto de 2024, a coleção de mais de 300 revistas de acesso aberto do Brasil passou a ser financiada por um consórcio de agências de apoio à pesquisa, composto pela Capes e pelo Conselho Nacional de Desenvolvimento Científico e Tecnológico (CNPq), além da FAPESP (ver Pesquisa FAPESP nº 345).
Packer lembra que, na Europa, o modelo de acordos transformativos geralmente é feito por universidades ou por consórcios de instituições. “O Brasil é um caso particular, porque tem um portal de periódicos nacional, com uma grande dimensão, que tem liderado esses convênios. Talvez seja o único país com uma política tão ampla.” Ele considera que o estabelecimento desses acordos é importante. “Mas, como produtor de ciência de alto nível, o país precisa continuar fortalecendo seus próprios periódicos. A SciELO, reconhecida mundialmente como modelo de acesso aberto, deve evoluir para atuar como publisher internacional competitiva.”
Segundo Packer, os acordos transformativos evidenciam uma desigualdade: enquanto se paga em média US$ 2 mil por artigo no exterior, os periódicos brasileiros operam com cerca de US$ 200 por artigo. “Seria importante pensar em acordos também com os periódicos do Brasil, com a SciELO representando-os e a Capes fi rmando parcerias diretas”, propõe. Ele complementa: “É preciso, ainda, uma mudança de mentalidade da comunidade científica que valorize a publicação em periódicos de qualidade editados nacionalmente, de modo a tornar o Brasil competitivo também na comunicação científica internacional”. l
Levantamento mostra quem são os pesquisadores do país cujo trabalho mais municia documentos de políticas públicas


Se a Organização Mundial da Saúde (OMS) recomenda às mães que alimentem seus bebês exclusivamente com leite materno durante os primeiros seis meses de vida, é porque evidências coletadas pelo grupo de epidemiologia da Universidade Federal de Pelotas (UFPel) já mostravam a importância dessa estratégia na década de 1980. Se o governo federal reduziu para 15% o limite de alimentos processados e ultraprocessados nas escolas públicas em 2025, deve-se isso ao conhecimento gerado pelo Núcleo de Pesquisas Epidemiológicas em Nutrição e Saúde (Nupens), da Universidade de São Paulo (USP), que desenvolveu o conceito de comida ultraprocessada: formulações e aditivos criados para substituir alimentos e preparações culinárias a fim de reduzir custos e aumentar receitas. Esses são alguns exemplos de estudos conduzidos por cientistas brasileiros que ajudaram a moldar políticas públicas no Brasil e no mundo. Uma maneira de demonstrar esse impacto é mensurar a frequência com a qual pesquisas são citadas nas referências bibliográficas de documentos de governos, instituições internacionais e do terceiro setor em diversos países. Foi o que fez um relatório publicado em novembro pela Agência Bori em parceria com a plataforma Overton, empresa com sede no Reino Unido especializada em mapear a interface entre ciência e

Pedro Brancalion (ao lado) se destacou com pesquisas sobre restauração florestal; e Ester Sabino com trabalhos sobre Covid-19

Cesar Victora liderou estudos que mostraram a importância da amamentação exclusiva nos primeiros meses de vida

políticas públicas. O levantamento apontou os 107 pesquisadores do país que receberam ao menos 150 citações em 13.742 documentos estratégicos entre 2019 e julho de 2025 (veja a lista completa no site de Pesquisa Fapesp).
Os cinco nomes mais citados concentram-se na UFPel e na USP. O epidemiologista Cesar Victora, da universidade gaúcha, é o primeiro da lista, com 231 papers mencionados em 3.109 documentos (ver tabela na página 36 ). Seu trabalho mais referenciado, de acordo com dados detalhados da Overton enviados a Pesquisa FAPESP, é um artigo publicado na revista The Lancet em 2013 que mostra que a má nutrição materna e infantil em países de baixa e média renda promove tanto a subnutrição quanto o crescimento do sobrepeso e da obesidade. Entre as conclusões, o estudo apontou que a desnutrição, além da amamentação inadequada, seria responsável por 3,1 milhões de mortes infantis por ano, o que correspondeu a 45% de todas as mortes de crianças em 2011. Victora lembra que essas pesquisas vieram na esteira de um estudo publicado no fim dos anos 1980, que mostrou que a amamentação exclusiva nos primeiros seis meses de vida protege contra infecções infantis. “Na época, esse conceito ainda não era amplamente reconhecido”, diz. A publicação teve grande repercussão e suas conclusões foram confirmadas em estudos do Peru e das Filipinas. “Políticas públicas nunca mudam com base em um único estudo. Com o acúmulo de evidências, em 1991 a ONU [Organização das Nações Unidas] e o Unicef [Fundo das Nações Unidas para a Infância] passaram a recomendar o aleitamento materno exclusivo nos primeiros seis meses. Hoje, essa proposição é adotada por cerca de 140 países.”
Entre seus colaboradores está o epidemiologista Aluísio Barros, também da UFPel, que figura

em terceiro lugar na lista da Overton, com 143 artigos citados em 874 documentos. Os dois papers de Barros mais mencionados em documentos de políticas públicas no período foram publicados na Lancet e também são voltados para a saúde materno-infantil. “Nossos estudos em saúde global, como cuidado pré-natal, vacinação e atenção ao parto, têm servido de subsídio para organizações internacionais como o Unicef, a OMS e a Gavi, the Vaccine Alliance.”
Outro nome da UFPel é o epidemiologista Pedro Hallal, quinto colocado na lista, com 72 artigos citados em 618 documentos. Hoje professor da Universidade de Illinois, nos Estados Unidos, seu paper mais citado em documentos ligados a políticas públicas é um trabalho divulgado em 2008 na Lancet – em que Victora, que foi seu orientador no doutorado, é um dos coautores – sobre desnutrição materna e infantil. Hallal também se destacou quando o assunto é atividade física e, durante a pandemia, sobre Covid-19. Entre seus artigos mais referenciados está um sobre os níveis globais de atividade física, que saiu em 2012 na Lancet. “Esse foi o primeiro estudo descrevendo os níveis de atividade física da população mundial, com dados de mais de 120 países. Mostramos que 30% dos adultos e 80% dos adolescentes eram inativos”, conta ele, que mantém o vínculo com a UFPel como pesquisador colaborador.
“Quando a OMS lança seu guia de atividades para a população, usa nossos dados. Vários países, quando lançam seus guias, também citam esse trabalho”, diz Hallal, que foi um dos coordenadores técnicos do Guia de atividade física para população
brasileira, publicado em 2021. Ele avalia que o destaque da UFPel, com três pesquisadores entre os primeiros da lista, pode ser explicado pelos estudos de coorte de nascimento criados por Victora em 1982 – o primeiro acompanha até hoje cerca de 6 mil pessoas, e novos ciclos se iniciam a cada 11 anos. “Eles permitem um grande volume de pesquisas e ajudam a entender por que uma universidade do interior alcança tanto destaque internacional.”
Hallal enfatiza a importância do trabalho em colaboração. Em 2025, passou um ano na USP – instituição que reúne quase um quarto dos 107 pesquisadores – como professor visitante, com apoio da FAPESP, sob supervisão do médico epidemiologista Carlos Augusto Monteiro, que figura em segundo lugar na lista da Overton, com 142 artigos mencionados em 890 documentos. Monteiro e seu grupo de pesquisa, o Nupens, desenvolveram o conceito de alimento ultraprocessado. Seu artigo mais citado em políticas públicas, com menções em documentos produzidos por instituições como a FAO (Organização das Nações Unidas para a Alimentação e a Agricultura) e a OMS, é justamente um trabalho que aborda como esses produtos passaram a dominar o sistema alimentar global e sua relação com o aumento da obesidade, publicado em 2012 na revista Obesity Reviews. Monteiro avalia que uma das causas da projeção de seus estudos é a própria natureza da epidemiologia nutricional: “Estudamos problemas que são grandes no Brasil e no mundo. Nosso núcleo tem estreita colaboração com os gestores de saúde pública, como o Ministério da Saúde”. O grupo criou a classificação Nova, que organiza os alimentos segundo o grau de processamento
industrial. Ela mostrou que o problema não está em nutrientes isolados, mas na substituição de padrões alimentares tradicionais por produtos ultraprocessados prontos para consumo, um fenômeno observado no Brasil e no mundo. “Com base nesses estudos, o Ministério da Saúde do Brasil publicou em 2014 o Guia alimentar para a população brasileira, pioneiro ao romper com o nutricionismo ao orientar as pessoas a comerem alimentos de verdade, preparados em casa, evitando produtos ultraprocessados”, observa. “Essa abordagem teve grande impacto na alimentação escolar, antes dominada pela indústria de ultraprocessados.” O pesquisador destaca que o guia também inspirou modelos adotados na América Latina e fora da região, como França, Índia e Canadá.
Ainda na USP, na área de clima e atmosfera, o patologista Paulo Saldiva aparece em quarto lugar no levantamento, com 100 artigos mencionados em 631 documentos. Entre seus papers mais influentes está o que trata do risco de mortalidade relacionada a temperaturas ambientais altas e baixas em 13 países, incluindo o Brasil, publicado em julho de 2015 na Lancet, além de trabalhos sobre poluição atmosférica e como ela impacta a saúde. Saldiva participou de dois marcos internacionais: em 2005, colaborou na definição dos novos padrões de qualidade do ar da OMS, escrevendo o capítulo sobre ozônio; em 2014, integrou o painel da International Agency for Research on Cancer, que avaliou a carga de casos de câncer atribuível à poluição do ar. “Considero minha participação na lista como a de alguém que produziu evidências científicas, não como formulador direto de políticas públicas”, observa.
Embora os primeiros lugares do levantamento sejam ocupados por pesquisadores ligados à saúde e nutrição, a maioria dos estudos citados

Brasileiros mais citados em documentos de tomada de decisão entre 2019 e julho de 2025
Nome
Cesar Victora
Carlos Augusto Monteiro
Aluísio Barros
Paulo Saldiva
Pedro Hallal
João Campari
Pedro Brancalion
Bernardo Strassburg
Álvaro Avezum
Britaldo Soares-Filho
Área dos documentos
Alimentação e nutrição
Alimentação e nutrição
Doenças não transmissíveis e serviços
Clima e atmosfera
Doenças não transmissíveis e serviços
Clima e atmosfera; ecossistemas e uso da terra
Ecossistemas e uso da terra
Ecossistemas e uso da terra
Doenças infecciosas e vacinas
Ecossistemas e uso da

(35%) aborda temas relacionados a ecossistemas e uso da terra, seguido por doenças infecciosas e vacina, e clima e atmosfera. O engenheiro-agrônomo Pedro Brancalion, da Escola Superior de Agricultura Luiz de Queiroz (Esalq) da USP, ocupa o sétimo lugar na lista da Bori-Overton, com 106 artigos mencionados em 583 documentos. Seu trabalho mais citado, publicado na revista Nature em 2020, mostrou que, caso fossem restauradas apenas 15% de áreas prioritárias globais selecionadas sugeridas no artigo, seria possível evitar cerca de 60% das extinções previstas de espécies animais e vegetais. Nessas áreas estão, por exemplo, regiões de Mata Atlântica. “Esse estudo serviu de base para a estratégia de implementação da Década da Restauração de Ecossistemas da ONU, que vai de 2021 a 2030, bem como está orientando o Plano Nacional de Recuperação da Vegetação Nativa do Brasil”, conta Brancalion.
Oeconomista João Campari, da organização não governamental World Wide Fund for Nature (WWF), aparece em sexto lugar, com três artigos citados em 586 documentos. “Sinto-me lisonjeado como único representante de uma organização da sociedade civil, e não da academia, entre os primeiros colocados.” Seu artigo mais citado, publicado em 2017 na PNAS, avalia 20 ações práticas de soluções baseadas na natureza, como evitar o desmatamento, restaurar florestas e melhorar o manejo agrícola. O texto conclui que essas ações poderiam reduzir um terço das emissões necessárias até 2030 para limitar o aquecimento global a menos de 2 °C. Na época, Campari era assessor ambiental do Ministério da Agricultura e Pecuária.


Dos 107 pesquisadores citados no levantamento, apenas 20,5% são mulheres e nenhuma delas aparece entre os 10 primeiros lugares. Essa distribuição não é homogênea: alimentação e nutrição concentram mais pesquisadoras (31,3%), seguidas por economia e finanças (28,6%). Em outras áreas, como doenças não transmissíveis e serviços, são 23,5%; seguidas por doenças infecciosas e vacinas (18,2%) e ecossistemas e uso da terra (13,5%). “Apesar de avanços, as mulheres ainda estão longe da igualdade, especialmente no acesso a financiamento e posições de liderança”, avalia a médica Ester Sabino, da USP, q ue figura na lista, com 37 artigos citados em 160 documentos. Seu trabalho mais mencionado foi publicado em fevereiro de 2021 quando a nalisou por que os casos de Covid-19 voltaram a crescer em Manaus mesmo após uma grande parte da população já ter sido infectada com a variante Gamma.
“O estudo teve grande repercussão. Na época, participei de discussões em reuniões da OMS”, lembra. O principal achado da pesquisa foi mostrar que a chamada imunidade de rebanho não era suficiente para impedir novas ondas da doença. O artigo foi citado, entre outras fontes, em diversos boletins epidemiológicos da OMS sobre a pandemia. “Por muito tempo, esse tipo de influência foi pouco valorizado”, observa Sabino sobre o relatório que dimensionou citações em documentos de políticas públicas. “Da exigência exclusiva de citações acadêmicas tem surgido nos últimos anos uma preocupação maior em avaliar o quanto a pesquisa científica impacta a vida das pessoas”, conclui. l
O documento consultado para esta reportagem está listado na versão on-line.
Médico infectologista, o novo reitor da USP fala de seus planos para melhorar o diálogo com a sociedade e a qualidade da formação dos alunos FABRÍCIO MARQUES

Omédico infectologista Aluísio Augusto Cotrim Segurado, de 68 anos, tomou posse na tarde de 23 de janeiro como o novo reitor da Universidade de São Paulo (USP). Graduado em 1980 na Faculdade de Medicina da USP, onde é professor do Departamento de Infectologia e Medicina Tropical, tem uma carreira dedicada a linhas de pesquisa relacionadas à epidemia de HIV no Brasil e outras doenças sexualmente transmissíveis, e ocupou vários cargos na administração da universidade: foi vice-reitor executivo de Relações Internacionais (2013-2014), coordenador do Escritório de Gestão de Indicadores de Desempenho Acadêmico (2018-2022) e pró-reitor de Graduação (2022-2025). Também foi o diretor do Instituto Central do Hospital das Clínicas (HC) de São Paulo durante a pandemia de Covid-19. Nos quatro anos de mandato, terá como vice-reitora a engenheira Liedi Légi Bariani Bernucci, de 67 anos, professora da Escola Politécnica da USP. Eles sucedem o reitor Carlos Gilberto Carlotti Junior e a vice-reitora Maria Arminda do Nascimento Arruda, que comandavam a USP desde 2022. No discurso de posse, Segurado enumerou desafios de sua gestão, como a criação de um escritório para orientar a comunidade acadêmica sobre o uso ético da inteligência artificial e o debate sobre uma nova forma de calcular os repasses do Tesouro às universidades estaduais paulistas depois que o ICMS deixar de existir. “Propomo-nos, a professora Liedi e eu, enfrentar com determinação os novos desafios que se apresentam. Identificamos como prioridades garantir e consolidar a autonomia universitária, fortalecer a convivência democrática e incorporar de forma crítica e responsável as tecnologias digitais disruptivas de inteligência artificial às atividades acadêmicas e de gestão”, afirmou. Ele recebeu Pesquisa FAPESP para a entrevista a seguir.
A USP segue sendo o maior polo de pesquisa e de produção científica do país. Os pesquisadores da universidade assinam 18% dos artigos científicos de autores brasileiros. Como manter a qualidade da pesquisa da USP e tentar avançar?
A USP é uma liderança na pesquisa básica e fundamental, que precisa continuar sendo apoiada integralmente com liberdade científica e acadêmica. Há um componente de pesquisa aplicada que é muito forte na USP em várias áreas de excelência. E há a pesquisa que se traduz em inovação, que está sendo proposta com uma concepção que não se restringe à inovação de produtos, mas também abrange a inovação de processos e a inovação social, a aplicação do conhecimento gerado da USP em subsídio de políticas públicas. Para que isso o corra, deve haver mais incentivos à atuação inter e multidisciplinar a fim de melhorar as conexões entre diferentes categorias de pesquisa e campos do conhecimento.
Inteligência artificial e garantia de financiamento estão entre as preocupações de Aluísio Segurado

O senhor foi o primeiro coordenador do Escritório de Gestão de Indicadores de Desempenho Acadêmico da USP. Quais são os indicadores mais relevantes para a USP?
Ainda não foram definidos completamente quais são as métricas e indicadores mais adequados e precisamos fomentar esse debate. Algo que se propõe é aferir em que medida a geração do conhecimento na universidade se traduz em desenvolvimento econômico e social. Como esse conhecimento se reverte na economia paulista e brasileira? Ele se traduz na atuação de empresas? Gera empregos? No lado social, temos hoje ferramentas e plataformas que vêm nos ajudando a buscar a tradução do conhecimento gerado na USP na formulação de políticas públicas, em que medida documentos oficiais, nacionais ou mesmo de instituições estrangeiras, são pautados no conhecimento gerado na universidade. Há um movimento da pós-graduação brasileira que tem procurado dar maior ênfase às métricas de impacto social da pesquisa
gerada na pós-graduação. Vamos caminhar para além da avaliação de métricas b aseadas na qualidade de periódicos e aprimorar indicadores de impacto social.
O senhor tem falado sobre a importância de criar um primeiro ano da graduação mais acolhedor. O que pretende fazer?
Queremos propor, e a próxima Pró-reitoria de Graduação tem essa tarefa, redesenhar esse primeiro ano. Muitas vezes, nossos cursos têm um primeiro ano muito árido e desconectado da prática profissional. O aluno não entende por que está estudando aqueles conteúdos. Pode ser estimulante para ele se introduzirmos logo disciplinas que apresentem a profissão. O estudante de oceanografia quer entrar em um navio no primeiro ano. Claro que ele precisa ter o conteúdo básico para ser um bom oceanógrafo, mas, se ele for embarcado logo de cara, vai pensar: “opa, entendi por que tenho que estudar física ou biologia, vai ser importante na hora em que eu estiver atuando como profissional”. Pense também no potencial de promoção e difusão da cultura que existe na USP. Colocar uma disciplina de conteúdos humanísticos em currículos de cursos que não são profissionalmente voltados para essa área também pode nos ajudar a formar cidadãos e cidadãs socialmente mais responsáveis com o exercício da sua profissão.
Como vai funcionar o novo Escritório de Transformação Digital e Inteligência Artificial?
Será um espaço institucional que ajudará a preparar nossos alunos, servidores, professores e professoras, para o uso da inteligência artificial de forma ética e adequada em processos pedagógicos, no apoio à pesquisa e nos processos de gestão administrativa. Vamos nos valer, por exemplo, de um novo cluster de computação avançada para buscar maior aproximação com as plataformas de grandes modelos de linguagem. Uma de suas dimensões é a formação. Tem que haver c ursos desde conceitos básicos em inteligência artificial até conteúdos mais elaborados para quem precisa se aprofundar. Uma disciplina está sendo desenhada para ser ofertada este ano, de introdução à inteligência artificial, que vai se valer também de ensino a distância. Alunos de todos os cursos poderão se matricular.
Nos próximos anos também vai ser modificado o cálculo dos repasses do Tesouro às universidades estaduais paulistas. Elas recebem um percentual do ICMS e esse imposto vai deixar de existir. Quais são as suas expectativas?
O desafio da garantia do financiamento é prioritário. Se o imposto no qual se baseava o cálculo da transferência de recursos para as universidades é extinto, outro imposto irá substituí-lo. A discussão que já começou no âmbito do Conselho de Reitores das Universidades Estaduais Paulistas [Cruesp] é como fazer que o novo cálculo não gere perdas orçamentárias. Há um compromisso estabelecido pelo governador Tarcísio de Freitas de que não haverá comprometimento dos valores, mas a discussão sobre a regulamentação disso será feita na Assembleia Legislativa do Estado de São Paulo, com a qual temos que buscar um diálogo franco. Se formos capazes de demonstrar o quanto o investimento na universidade se traduz em benefícios para a sociedade, mais convincentes seremos.
Que universidade espera entregar para o seu sucessor em 2030? Em que o senhor espera que ela seja diferente da USP de hoje?
Espero que ela esteja sustentável do ponto de vista financeiro, que não haja fantasmas de instabilidade. Espero que ela tenha absorvido o entendimento de que a diversidade não antagoniza com a excelência acadêmica, pelo contrário, a potencializa. A pluralidade nos ambientes de pesquisa e pedagógicos favorece o desenvolvimento da solidariedade, da corresponsabilidade, da empatia e nos aproxima da sociedade. Ela fura a bolha que, por vezes, querem nos atribuir. E quero deixar uma USP conectada com os desafios do futuro. O mundo do trabalho mudou. Para que os nossos egressos continuem sendo líderes nas suas áreas de atuação, eles precisam ter elementos que permitam sua inserção no mundo do trabalho de forma qualificada e contemporânea às necessidades atuais. A busca pelo diálogo contínuo e aberto com a sociedade permite repensarmos as nossas práticas, procurando aprimorá-las a cada momento. A universidade não pode se fechar em si mesma. Ela precisa ter uma interação muito firme e benéfica com a sociedade. l

Estudos mostram que a inteligência artificial ajuda pesquisadores a ampliar seu número de publicações e avança como ferramenta na avaliação por pares
Autores que usam programas de inteligência artificial (IA) generativa para apoiar a escrita de artigos científicos estão multiplicando sua produtividade acadêmica, de acordo com uma análise feita por pesquisadores das universidades Cornell e da Califórnia, em Berkeley, nos Estados Unidos. Veiculado na revista Science , o estudo se baseou no exame de quase 2,1 milhões de resumos de preprints disponibilizados em três grandes repositórios on-line entre janeiro de 2018 e junho de 2024. Preprints são versões preliminares de trabalhos científicos ainda não avaliadas por especialistas nem publicadas em periódicos.
No arXiv, um dos mais antigos repositórios desse tipo de manuscrito, autores que utilizaram programas de IA ampliaram sua produção em cerca de 36% em relação ao patamar anterior ao advento do ChatGPT, em 2023. O arXiv foi criado no início da década de 1990 para hospedar papers de física, mas hoje recebe
trabalhos de diversas áreas das ciências exatas e aplicadas. Já no bioRxiv, com foco nas ciências biológicas, pesquisadores que se apoiam nesses programas expandiram o número de publicações em 53%. O aumento mais significativo foi observado entre os que recorreram ao Social Science Research Network (SSRN), voltado às ciências sociais, humanas e jurídicas: eles publicaram quase 60% mais manuscritos.
Para chegar a esses resultados, os responsáveis pelo estudo seguiram uma receita trabalhosa. Primeiro, pegaram todos os resumos de preprints depositados até 2023 – que estavam imunes à influência do ChatGPT – e pediram ao modelo GPT-3.5 Turbo 0125, da empresa OpenAI, que os reescrevesse. Desse modo, puderam comparar textos distintos baseados em um mesmo conteúdo – um deles escrito por humanos e o outro por IA – e mapear suas características. “Isso nos permitiu quantificar as diferenças na distribuição de palavras entre a escrita amparada por assistentes de linguagem e a escrita humana”, afirmaram os pesquisadores no artigo da Science. O passo seguinte foi identificar atributos típicos de textos gerados por IA nos resumos divulgados depois de 2023. Por fim, foram examinadas a produção dos autores ao longo do tempo e a evolução da quantidade de publicações dos que usaram e dos que não usaram IA.
Um dos dados mais notáveis foi o aumento proporcionado pela nova tecnologia na produtividade em países não anglófonos. O inglês é a língua franca da ciência e periódicos conceituados exigem que os manuscritos sejam escritos em inglês de alto nível, o que historicamente coloca em desvantagem cientistas não nativos nessa língua. Com a IA assumindo parte dessa tarefa, pesquisadores com nomes asiáticos e afiliados a instituições asiáticas viram sua produção aumentar em 43% no arXiv e quase 90% no bioRxiv e no SSRN.
O estudo, porém, chegou a um resultado preocupante em relação à qualidade dos manuscritos apoiados por IA. Esses textos apresentavam uma complexidade superior à exibida em trabalhos anteriores dos mesmos autores, que se manifestava, por exemplo, no uso de sentenças mais longas e explicações bem concatenadas. Mas o fato de estarem bem escritos não ampliou as chances de serem aceitos para publicação em revistas quando foram avaliados por especialistas. De acordo com o estudo, o uso de IA fez desaparecer a correlação, frequentemente observada por editores e revisores, entre o mérito científico de um artigo e a qualidade estilística de seu texto. “À medida que o esforço necessário para produzir uma prosa refinada diminui, também reduz a sua utilidade como um sinal do domínio do autor sobre um determinado tópico. Isso cria um risco para a atividade científica, pois uma enxurrada de pesquisas superficialmente convincentes, mas pouco robustas, poderia saturar a literatura. Se isso ocorrer, a comunidade perderá um tempo valioso separando descobertas genuínas de um emaranhado de trabalhos irrelevantes e potencialmente enganosos”, escreveram os autores.
Para um dos responsáveis pela pesquisa, o sociólogo Mathijs de Vaan, da Escola de Negócios Haas da Universidade da Califórnia em Berkeley, o rebuscamento na linguagem de trabalhos escritos com apoio de IA faz com que eles pareçam mais impressionantes do que realmente são. Mas ele observa que o suporte da inteligência artificial teve um efeito positivo na diversificação das referências bibliográficas, ajudando a gerar trabalhos que citaram com frequência pesquisas e livros publicados recentemente e a reduzir o uso de fontes canônicas e repetitivas. “O acesso a grandes modelos de linguagem permite que as pessoas referenciem trabalhos que antes não eram tão citados”, observou o pesquisador em entrevista à Chemical & Engineering News.
Além de avolumar a produção de pesquisadores, a IA generativa também pode auxiliá-los em tarefas do processo de revisão por pares. Segundo uma pesquisa realizada pela editora Frontiers com cerca de 1.600 acadêmicos em 111 países, mais de 50% disseram já ter utilizado inteligência artificial na revisão de manuscritos. O levantamento constatou que 59% dos entrevistados usaram a tecnologia para ajudar a escrever seus pareceres, 29% para resumir o manuscrito, identificar lacunas ou verificar referências e outros 28% para apontar eventuais indícios de má conduta acadêmica, como plágio e duplicação de imagens. Várias editoras, entre elas a própria Frontiers, permitem a utilização de IA em etapas do processo de avaliação por pares, mas proíbem que manuscritos ainda não publicados sejam compartilhados nos sites dessas ferramentas, pelo risco de vazamento de dados e de comprometimento da propriedade intelectual dos autores.
Seria a inteligência artificial capaz de criar análises consistentes na revisão por pares? A resposta é não, de acordo com um experimento realizado pelo engenheiro Mim Rahimi, pesquisador da Universidade do Texas, em Houston, nos Estados Unidos. Ele quis verificar se o programa GPT-5 conseguiria revisar um paper da Nature Communications do qual ele foi coautor. Testou quatro estratégias diferentes, desde fornecer apenas instruções básicas até municiar a ferramenta com estudos disponíveis na literatura para ajudá-la a avaliar a originalidade do trabalho, e comparou os resultados com os relatórios de revisão por pares que havia recebido da Nature Communications Embora o GPT-5 tenha conseguido imitar a estrutura de um relatório, falhou em produzir recomendações construtivas para aperfeiçoar o manuscrito, que é um dos propósitos da revisão por pares, e cometeu erros factuais. Segundo disse Rahimi à revista Nature, o experimento o ensinou que as ferramentas de IA “podem fornecer alguma informação, mas, se alguém for confiar apenas nela, isso seria bastante prejudicial”. l MÔNICA MANIR
Atestados médicos falsos apresentados por alunos se tornam um problema para universidades do Reino Unido
Oadvogado e especialista em ética médica Daniel Sokol chamou a atenção para um problema que ganha evidência em universidades do Reino Unido: o aumento no número de atestados médicos falsos produzidos por estudantes para abonar faltas, apresentar recursos ou cumprir tarefas fora do prazo. Sokol, que já foi professor de ética médica do Imperial College de Londres e escreve regularmente sobre o assunto no British Medical Journal, fala com conhecimento de causa. Seu escritório defende estudantes acusados de má conduta e tem recebido vários clientes, na maioria alunos estrangeiros,
que usaram atestados falsos produzidos com a ajuda de programas como o Photoshop e o ChatGPT.
“Alguns estudantes usam suas habilidades técnicas para replicar atestados m édicos que receberam no passado”, disse Sokol à revista eletrônica Times Higher Education . Rastrear atestados fraudulentos nem sempre é tarefa fácil, ele observa. “É possível consultar o Conselho Geral de Medicina para checar se o médico existe. Se o profissional for real, é preciso entrar em contato com ele para ter certeza do atendimento.” Já se for um médico estrangeiro, a verificação é mais difícil.
A dificuldade é agravada pela sobrecarga das equipes das universidades do Reino Unido com a análise de solicitações de alunos, que às vezes soam excessivas ainda que sigam as regras. Um levantamento publicado em 2025 na revista acadêmica Studies in Higher Education entrevistou 41 funcionários de uma universidade no nordeste da Inglaterra, cuja identidade foi mantida em sigilo, e eles
apontaram má-fé em pedidos frequentes apresentados por estudantes.
Para requerer um adiamento de prazo naquela universidade, o aluno precisa apenas apresentar uma declaração informando que está doente ou passando por u m problema. “Semanas antes do final do prazo, ouvi um aluno dizer que usaria uma autodeclaração para obter uma prorrogação porque iria visitar alguns amigos”, disse um dos funcionários entrevistados. Outro relatou a percepção de “desonestidade generalizada” entre os estudantes. “O sistema é muito permissivo”, explicou.
A autora do levantamento, a psicóloga Helen St. Clair-Thompson, da Universidade de Newcastle, disse à Times Higher Education que resolveu examinar o problema depois de ouvir relatos sobre volumes “enormes” de solicitações que se tornaram “incontroláveis”. “Alguns funcionários questionaram se não seria melhor ter sistemas automatizados que aprovassem um número mais restrito de solicitações, para que não fosse necessário avaliar tantos pedidos”, explicou.
Bibliografia de um relatório do Banco Mundial sobre obesidade na Ásia continha referências fabricadas
Um relatório do Banco Mundial que analisa a influência de sistemas alimentares no aumento da obesidade em países do sul da Ásia foi retirado da página na internet da instituição financeira e será revisto. A remoção ocorreu após um alerta feito pelo site Retraction Watch, que identificou inconsistências graves na bibliografia do estudo. Catorze entre 148 referências a artigos direcionavam a documentos inexistentes. Outras 14 citações, relacionadas a relatórios, documentos de políticas públicas e notícias, igualmente não puderam ser verificadas.
Três dos quatro autores do trabalho são funcionários do Banco Mundial. Nenhum deles respondeu ao Retraction Watch sobre como as citações falsas foram parar no documento. O banco informou que “espera que seus pesquisadores mantenham altos padrões profissionais, incluindo o uso correto das fontes”, e que o artigo, depois de revisto, será republicado com uma nota descrevendo as correções. Denúncias sobre referências fabricadas em trabalhos acadêmicos se tornaram frequentes nos últimos anos. Esse tipo de citação é comum em textos gerados por programas como o ChatGPT. Em maio, um relatório sobre saúde infantil lançado pelo governo dos Estados Unidos mencionou artigos fictícios sobre saúde mental, tratamento de crianças com asma e publicidade de medicamentos. Em julho, a editora Springer Nature removeu de seu site um livro sobre aprendizado de máquina que continha 12 referências bibliográficas com erros grosseiros ou que remetiam a trabalhos inexistentes.
Conhece a nossa newsletter de integridade científica?

Acesse o QR Code para assinar nossas newsletters

➔ Em 2024, foram depositados no Instituto Nacional da Propriedade Industrial (INPI) 31.036 pedidos de patentes de invenção, número ligeiramente superior aos 30.996, do ano anterior
➔ Desse total, 67,9% foram realizados por não residentes no Brasil e apenas 32,1% por residentes. Entre esses últimos, os realizados por pessoas físicas passaram de 3.116, em 2023, para 3.345, em 2024, enquanto os de pessoas jurídicas variaram entre 4.319 e 4.956, no mesmo período
UNIDADE
➔ Entre os residentes, São Paulo lidera entre as unidades da federação em número de depósitos. Nos últimos dois anos, passou de 2.306 para 2.463 (29,7% do total), variação de 6,8% no período
➔ Minas Gerais, Rio Grande do Sul, Rio de Janeiro, Paraná e Santa Catarina vêm a seguir, cada um com mais de 600 pedidos de patentes depositados em 2024
➔ Em relação aos não residentes, os pedidos originários dos Estados Unidos lideraram os depósitos registrados nos dois anos mais recentes: 7.683 em 2023, e 7.084 em 2024
➔ No último ano, os demais países com maior número de pedidos depositados no INPI foram China, Alemanha, Suíça e Japão, com mais de mil pedidos cada um. No período, apenas China e Reino Unido aumentaram esse número
➔ Embora São Paulo concentre os depósitos de residentes no país, seu protagonismo ocorre num ambiente em que depositantes estrangeiros dominam o espaço de proteção tecnológica no país
O menor bioma nacional é o que mais aqueceu e perdeu chuvas em 40 anos
MARCOS PIVETTA

Amaior planície alagável do mundo está secando e ficando mais quente a um ritmo acelerado. Em quatro décadas, o Pantanal, o menor bioma brasileiro, foi o que mais aqueceu e teve a maior redução na quantidade de chuvas. Essa dupla tendência, de mais calor e de menos pluviosidade, é visível em todos os ecossistemas nacionais – da Amazônia, no Norte, que engloba quase metade da área do país, ao Pampa, no Rio Grande do Sul, ainda que nesse bioma de forma bem menos perceptível. Mas ela é mais acentuada no Pantanal, que se estende por aproximadamente 150 mil quilômetros quadrados (km²), 1,8% do território nacional.
Entre 1985 e 2024, a temperatura média no bioma subiu 0,47 grau Celsius (ºC) por década, segundo dados da primeira edição do “MapBiomas atmosfera”, levantamento lançado em novembro do ano passado por uma plataforma colaborativa de mais de 70 organizações não governamentais (ONG), universidades e startups de tecnologia.

Em quatro décadas, o aumento acumulado no Pantanal chega a quase 1,9 ºC. Não é por acaso que os dois estados que mais esquentaram durante o período de 40 anos coberto pelo trabalho foram Mato Grosso do Sul e Mato Grosso.
A temperatura média anual subiu 0,40 ºC por década no primeiro e 0,35 ºC no segundo. O ritmo de crescimento do aquecimento no Pantanal é 60% superior ao calculado no mesmo período para o Brasil como um todo (de 0,29 ºC por década) e os biomas Amazônia (0,29 ºC) e Cerrado (0,31 ºC), que abrangem quase três quartos da área nacional. A velocidade de subida dos termômetros no Pantanal é ainda cerca do dobro da apresentada na Caatinga e na Mata Atlântica e mais do que o triplo da do Pampa nos 40 anos analisados (ver quadro na página 46 ). O Pantanal abrange 25% das áreas sul-mato-grossenses e 7% das mato-grossenses. A principal atividade econômica em suas terras é a p ecuária, presente na região há 200 anos. As pastagens ocupam aproximadamente 15% de seu território.
“Os biomas próximos do centro do continente, como o Pantanal e o Cerrado, estão longe da influência moderadora do oceano e aquecem mais rapidamente do que os ecossistemas mais perto da costa atlântica”, comenta Luciana Rizzo, do Instituto de Física da Universidade de São Paulo (IF-USP) e coordenadora do “MapBiomas atmosfera”. De acordo com o relatório, a temperatura média no Pantanal foi de 26,2 ºC entre 1985 e 2024, maior do que a do Brasil (24,6ºC) e a dos demais biomas. Os dados de temperatura usados no trabalho derivaram da base europeia ERA5, do Serviço de Mudança Climática Copernicus. O sistema reúne e valida uma série de informações meteorológicas monitoradas na superfície e na atmosfera por diferentes fontes (satélites, balões, aeronaves, sensores) e gera uma reanálise da evolução histórica do clima. O Copernicus é um dos serviços internacionais que acompanham a evolução do aquecimento global e divulgou em janeiro de 2026 que o ano passado foi o terceiro mais quente da história recente (ver reportagem na página 49)
Um artigo de pesquisadores do Instituto Nacional de Pesquisas Espaciais (Inpe) e da Universidade Estadual Paulista (Unesp), publicado no fi nal de novembro de 2025 na revista científica Atmosphere, chegou a resultados muito parecidos com os divulgados pelo MapBiomas. Feito t ambém a partir de dados da ERA5, o estudo abrangeu um período ligeiramente maior, de 1979 a 2024, e apontou igualmente o Pantanal como o bioma brasileiro que mais sofre os efeitos da elevação de temperatura e da redução de precipitação.
A questão da rarefação de chuvas é particularmente preocupante no bioma, onde a água é um elemento definidor de uma paisagem única e das condições de vida locais. Composto por terras baixas e planas, que periodicamente são inundadas pelas cheias do rio Paraguai e seus afluentes, o Pantanal vive no ritmo de seus corpos-d’água.
A subida do termômetro
Elevação da temperatura média em grau Celsius (O C) a cada década entre 1985 e 2024
Segundo o trabalho na Atmosphere , houve uma redução média de 10,45 milímetros (mm) na quantidade de chuva que caiu a cada década no bioma ao longo dos 45 anos analisados. No Cerrado, o segundo ecossistema mais afetado por essa tendência, a queda foi de 7,92 mm por década. Nos demais biomas, a diminuição de precipitação variou de 2,75 mm a 5,60 mm. Com frequência, o Pantanal já aparece como o segundo bioma com menor índice de pluviosidade anual, com chuvas totais entre 800 e 1.200 mm, menos seco apenas do que a Caatinga. É uma ironia, e um sinal de alerta, para um ecossistema tão associado à dança das águas em seus rios e lagoas.
Oartigo científico ainda mostrou que tanto o valor médio das temperaturas máximas como o das mínimas cresc em nos biomas brasileiros. Mas a velocidade de subida da média das máximas é geralmente o dobro da média das mínimas. Ou seja, os dias estão esquentando mais r apidamente do que as noites. “O artigo sugere que o aquecimento climático não é decorrente de uma causa natural e só pode ser causado por uma ação antropogênica”, comenta o meteorologista José Roberto Rozante, do Centro de Previsão de Tempo e Estudos Climáticos (CPTEC) do Inpe, autor principal do estudo. “Não se trata apenas de variações cíclicas que naturalmente ocorrem de tempos em tempos.”
Dois períodos recentes foram marcados por secas e grandes incêndios no Pantanal. Em 2020, mais de um quarto de sua área foi consumido por extensas queimadas. Estima-se que 17 milhões de animais vertebrados tenham morrido na ocasião. Em 2024, houve uma nova temporada de forte estiagem, considerada a maior dos últimos 40 anos, agravada por mais focos de incêndio. “A maioria das queimadas não tem origem natural, é causada pelo homem”, afirma o meteorologis-

Diminuição da pluviosidade média em milímetros (mm) a cada década entre 1979 e 2024
Quati toma água nos arredores da rodovia Transpantaneira, em Poconé (MT), em setembro de 2020, durante uma grande seca no Pantanal
ta Gilvan Sampaio, do CPTEC-Inpe. “É intencional e pode ser obra de criminosos.” Estudos recentes feitos pelo Laboratório de Aplicações de Satélites Ambientais do Departamento de Meteorologia da Universidade Federal do Rio de Janeiro (Lasa-UFRJ) indicam que 99% das queimadas no bioma foram causadas por atividades humanas. Apenas 1% tem origem natural.
O Pantanal é frequentemente apontado como o bioma mais bem protegido do país, com cerca de 85% de sua paisagem original preservada. O dado é correto, mas esconde pressões crescentes e uma vulnerabilidade climática que se tornou evidente nos últimos anos. Além da questão do aquecimento global, que empurra os termômetros para cima em todas as latitudes do planeta, a lterações dentro de seus limites geográficos e

nos dois grandes biomas vizinhos, a Amazônia e o Cerrado, contribuem para esquentar e tornar mais seca a região.
Um dos primeiros lugares que se beneficiam da umidade amazônica transportada pelos chamados rios voadores é a planície alagada no centro da América do Sul. Quando, em razão do desmatamento e da degradação de sua vegetação, a floresta t ropical reduz sua capacidade de reciclar água e redistribuí-la pelos ares para outras partes do continente, o Pantanal sente rapidamente seus efeitos. “É um bioma muito sensível”, diz o meteorologista Luiz Machado, do IF-USP, que trabalhou no levantamento “MapBiomas atmosfera”. “Se chove menos na Amazônia e menos umidade vai para o Pantanal, a vazão de água em seus rios é menor.”
Apluviosidade na região costuma se concentrar entre outubro e abril. Em anos úmidos, até 80% de suas terras podem permanecer inundadas por alguns meses. Boa parte da água que alaga a área vem de rios que se originam em áreas mais altas do Cerrado e da Amazônia, dois biomas que são os alvos preferenciais do desmatamento. Segundo estudo publicado em setembro de 2025 na revista científica Nature Communications, o desflorestamento é a alteração que mais reduz a pluviosidade na Amazônia durante a estação seca, entre maio e setembro, enquanto o aquecimento global é o fator que mais eleva sua temperatura. “Quase 75% da diminuição da pluviosidade está ligada à supressão da vegetação da floresta”, explica Machado, um dos autores do trabalho. As alterações climáticas estão apagando, aos poucos, portanto, o traço mais definidor do Pantanal: o chamado pulso de inundação, o ciclo de cheias e secas que faz seus rios e lagoas avançarem e recuarem sobre a terra ao longo do ano. Entre 1985 e 1994, a área anual que alagava no bioma chegava a 16 mil km², segundo dados do
MapBiomas. Entre 2014 e 2024, essa fatia caiu para 4,6 mil km², uma redução de quase de 75%. Em 2024, ano mais seco da história do bioma, a área que normalmente permanece inundada retrocedeu em 73% em relação à média histórica. O balé das águas é o que torna o Pantanal único e possibilita a sobrevivência de suas formas de vida mais típicas, como jacarés e tuiuiús. Ave símbolo do bioma, o tuiuiú vive sempre perto de corpos de água doce limpos.
Em meio ao aquecimento global, com um clima, em geral, mais seco e quente e suscetível a eventos extremos, e a pressões locais e regionais, como o crescimento da agropecuária no vizinho Cerrado e mesmo em suas terras, o Pantanal tem sofrido com estiagens prolongadas. A sucessão de abalos dificulta a recomposição plena de seu cenário. “O Pantanal não se recuperou das grandes secas e ondas de calor recentes”, comenta o climatologista José Marengo, do Centro Nacional de Monitoramento e Alertas de Desastres Naturais (Cemaden). “É uma região muito vulnerável, de transição entre a Amazônia e a bacia do rio da Prata.”
Quando dois fenômenos climáticos extremos ocorrem simultaneamente em um lugar, os pesquisadores denominam essas manifestações que se sobrepõem de “eventos compostos”. O Painel Intergovenamental sobre Mudanças Climáticas (IPCC) e uma série de estudos indicam que os
eventos compostos estão cada vez mais frequentes no mundo. O Pantanal, onde a seca prolongada costuma se associar às altas temperaturas, não é exceção. O dramático é que, ao não se refazer por completo dos impactos de um evento composto de grande magnitude, uma área se torna progressivamente mais propensa a ser alvo de novas anomalias climáticas severas. Esse mecanismo de retroalimentação cria uma espiral de vulnerabilidades. “Atualmente o centro e o norte do Pantanal são as partes mais afetadas pela redução do ciclo das águas no bioma”, diz Marengo. Em uma nota técnica do final de 2023 produzida pelo Inpe e Cemaden, que tratava do surgimento da primeira área com clima árido no Brasil, na divisa da Bahia e de Pernambuco, foi também mencionado o aparecimento no país de duas zonas subúmidas secas, a partir de 1990 (ver Pesquisa FAPESP nº 338). Até então, esse tipo de clima, que é um estágio que antecede o semiárido, não se manifestava no território nacional. Um dos lugares em que o subúmido seco, onde raramente chove mais do que 800 mm por ano, despontava era o norte do Rio de Janeiro. O outro era no oeste de Mato Grosso do Sul, em pleno Pantanal. Não é de hoje que a maior planície alagada do planeta vem secando e esquentando – muitas vezes de forma silenciosa, quase despercebida; em outras ocasiões, como nas recorrentes temporadas de incêndios, de maneira mais ruidosa. l
Os projetos e os artigos científicos consultados para esta reportagem estão listados na versão on-line.
Formação de chuva sobre o rio Madeira em Manicoré (AM): umidade da Amazônia abastece o Pantanal

A temperatura média anual do planeta em 2025 só foi menor do que em 2024 e 2023
MARCOS PIVETTA

AOrganização M eteorológica
Mundial (WMO) confirmou em janeiro que 2025 foi o terceiro ano mais quente desde a e ra pré-industrial, a segunda metade do século XIX, adotada como referência para calcular o aquecimento global. A entidade, ligada às Nações Unidas, consolidou os dados de oito serviços climáticos internacionais, dois a mais do que fizera em ocasiões anteriores, e concluiu que a temperatura média da superfície do planeta em 2025 foi de 15,08 graus Celsius (ºC). O valor faz com que o aquecimento global calculado ao longo do ano passado tenha sido de 1,44 ºC acima da média do período de base, entre 1850 e 1900. A margem de erro do cálculo é de 0,13 ºC para mais ou menos. Apenas 2024 e 2023, respectivamente o primeiro e o segundo ano mais quente da história recente, suplantaram a tempe -
ratura média de 2025. Segundo a WMO, o aquecimento global de 2024 chegou a 1,55 °C e o de 2023 a 1,45 °C. O período entre 2015 e 2025 engloba os 11 anos mais quentes desde a era pré-industrial. “Isso fornece mais evidências de uma tendência inegável rumo a um clima mais quente”, disse, em comunicado à imprensa, o físico italiano Carlo Buontempo, diretor do Serviço de Mudança Climática Copernicus, da União Europeia, uma das oito entidades que produzem sistematicamente os dados de temperatura consolidados pela WMO. “O mundo está se aproximando rapidamente do limite de temperatura de longo prazo estabelecido pelo Acordo de Paris.”
Segundo esse tratado internacional, que estimula os países a reduzir a emissão de gases de efeito estufa, seria desejável que o planeta não esquentas -
O ano de 2025 foi o terceiro mais quente da história recente, com uma temperatura média global 1,47 ⁰C acima da era pré-industrial
se mais do que 1,5 ºC em relação à era pré-industrial. Dessa forma, os efeitos das mudanças climáticas não seriam, em tese, tão catastróficos e ainda poderiam ser administrados pelos países. Dados do Copernicus sinalizam que as temperaturas estiveram muito altas em 2025, sobretudo nas regiões polares. O ano passado foi mais quente na Antártida e o segundo mais quente no Ártico, inclusive na Groenlândia. Nos trópicos, apesar de terem ocorrido ondas de calor, os ponteiros do termômetro subiram de forma menos pronunciada. Esse também foi o caso do Brasil. De acordo com os registros obtidos nas estações do Instituto Nacional de Meteorologia (Inmet), a temperatura média anual no Brasil em 2025 foi de 24,56 °C. “Foi o sétimo ano mais quente”, diz o meteorologista Glauber Willian de Souza Ferreira, do Inmet. l
Em experimentos, queimadas e pastejo melhoram a saúde de campos de Cerrado
GILBERTO STAM

Depois da queima controlada (à esq.), vegetação rebrota cada vez mais fortalecida (à dir.)
Entre 2015 e 2022, a equipe da engenheira florestal Giselda Durigan, do Instituto de Pesquisas Ambientais (IPA) do estado de São Paulo, ateou fogo uma vez por ano a campos abertos de Cerrado na Estação Ecológica de Santa Bárbara, no oeste paulista. Embora a vegetação desse ecossistema seja adaptada às chamas, raramente ela é exposta a queimadas intensas com essa frequência. Mesmo assim, as gramíneas nativas sobreviveram e o campo se tornou mais denso, como descrito em artigo publicado em dezembro de 2025 na revista Journal of Applied Ecology
“Depois da queimada, o número médio de espécies de capim aumentou em 15%, a vegetação se tornou mais densa e as gramíneas avançaram sobre trechos de terra exposta, tornando a cobertura vegetal mais contínua e homogênea”, relata Durigan. A pesquisadora é uma das autoras do artigo e coordenadora do projeto temático Biota Campos, financiado pela FAPESP, que estuda a biodiversidade dos campos naturais de São Paulo.
“Algumas plantas que não toleram a queima foram eliminadas e substituídas por espécies nativas resistentes”, acrescenta o biólogo Hudson Fontenele, estudante de doutorado da Universidade de Brasília (UnB) e primeiro autor do artigo. Os pesquisadores fizeram o experimento em três regiões da estação ecológica, cada uma delas
isolada das outras por faixas sem vegetação que impedem a propagação das labaredas para outras áreas não selecionadas. O levantamento de espécies e a contagem de indivíduos foram feitos antes e depois da sequência de queimadas. Além da FAPESP, o trabalho recebeu financiamento da National Science Foundation (NSF), dos Estados Unidos, da Coordenação de Aperfeiçoamento de Pessoal de Nível Superior (Capes) e do Conselho Nacional de Desenvolvimento Científico e Tecnológico (CNPq).
A bióloga Bruna Campos, que concluiu o estágio de pós-doutorado no Instituto de Pesquisas A mbientais (IPA) em 2025, com supervisão de Durigan, já havia detectado o efeito positivo da queima em outro experimento, conforme descreve em artigo publicado em outubro de 2025 na revista Journal of Vegetation Science, que, além das outras fontes de fomento, contou com recursos da empresa de energia AES Brasil. Entre 2 020 e 2021, a pesquisadora estudou 14 regiões campestres em Cerrados de Minas Gerais, de Mato Grosso do Sul, do Paraná, de São Paulo e de Goiás, cada uma delas com 1 hectare (ha), tamanho aproximado de um campo de futebol. A partir de imagens do satélite Landsat capturadas desde 1985 e dos dados de campo, ela verificou que as regiões que queimaram com mais f requência ao longo desses 35 anos tinham a maior diversidade de espécies.

No mesmo trabalho, Campos notou uma relação entre o clima e a composição de espécies vegetais. “Quanto mais as temperaturas mínimas eram parecidas entre locais, mais semelhante era a composição de espécies”, afirma a bióloga, primeira autora do trabalho. No entanto, ao contrário do que os pesquisadores esperavam, o solo não parece ser determinante para a composição das espécies vegetais, nem para a proporção entre gramíneas e outras plantas ou a quantidade de material vivo acima do solo, a biomassa.
“O fogo reduz as copas das árvores que fazem sombra e prejudicam o capim e as outras plantas pequenas, que correspondem a mais de 80% das espécies do Cerrado e dependem da insolação”, observa Durigan. Segundo a pesquisadora, ele ajuda a separar as diferentes feições do Cerrado, caracterizado por um mosaico de ambientes – além das gramíneas, também há campos com árvores retorcidas ou arbustos distribuídos de forma esparsa, áreas mais densas de floresta, com árvores de até 15 metros (m) de altura e as veredas, que crescem em áreas alagadas ladeando os rios e exibem as palmeiras conhecidas como buriti (Mauritia flexuosa). “Sua variedade de feições faz dele um dos biomas com a paisagem mais variada e a savana mais biodiversa do mundo, chegando a 40 espécies de plantas pequenas por metro quadrado”, ressalta Durigan.
“Os dois artigos fazem uma análise robusta que ajuda a entender como os campos do Cerrado reagem ao fogo”, reconhece o geólogo Britaldo S oares-Filho, da Universidade Federal de Minas Gerais (UFMG), que não participou do estudo. Para o pesquisador, no entanto, seria importante considerar as outras feições do Cerrado para entender o papel da queimada no bioma como um todo.
“As chamas favorecem as gramíneas, mas podem ser prejudiciais em áreas de maior biomassa, como as florestas do Cerrado”, alerta. Segundo ele, quando a biomassa se acumula no solo, devido à queda de folhas e galhos, o fogo pode sair do controle e se tornar danoso, especialmente na

estação seca. “Por isso, é recomendável conter as labaredas e não deixar que se espalhem por regiões amplas.”
Embora a pecuária seja um dos motivos da degradação do Cerrado, não só pela conversão do ambiente, mas pela disseminação de forrageiras exóticas invasoras, a equipe de Durigan resolveu testar a capacidade do gado de ajudar na recuperação da vegetação nativa invadida diminuindo a quantidade de capim exótico, como descrevem em artigo publicado neste mês na revista Agriculture, Ecosystems and Environment. “Os animais preferem o capim invasor, por ser mais palatável”, relata Campos, primeira autora do artigo.
Na Estação Ecológica de Santa Bárbara, Campos alternou períodos de pastejo e de pausio, sistema conhecido como rotacionado, durante dois anos. Ela comparou a ação do pastejo em uma área de campo cerrado invadida pelo capim conhecido como braquiária (Urochloa decumbens) com outra, vizinha, mantida sem gado. “A diver-

Outras fisionomias do Cerrado: savana (à esq.) e floresta (à dir.)


Nem todo campo é igual: os de Cerrado são sujeitos a secas (à esq.), e os de altitude (à dir.) podem receber geadas severas
sidade de plantas nativas aumentou em até 30% na área com gado e a gramínea exótica diminuiu drasticamente”, constatou Campos. Em 2024, o uso do pastejo foi aprovado por lei para manejo sustentável, no estado de São Paulo. “O estudo mostrou que a prática é ecologicamente sustentável e provavelmente a alternativa mais rentável para áreas de reserva legal no Cerrado, mantidas obrigatoriamente pelos proprietários rurais.”
De acordo com Durigan, uma das maiores limitações para a preservação dos campos nativos é a dificuldade de identificá-los e mapeá-los por meio de imagens de satélite. “Essas imagens não diferenciam com precisão a vegetação nativa das áreas cultivadas, de pastagens com gramíneas exóticas ou terras abandonadas”, diz Durigan. Ela relata que sua equipe examinou cerca de 400 localidades em busca de campos naturais paulistas e verificou que, por esse motivo, metade dos que ainda existem não constava em mapas.
O capim-gordura (Melinis minutiflora), espécie forrageira de origem africana que muitas vezes recobre campos inteiros, tem nas imagens de satélite a mesma coloração dos campos nativos. Outro problema é que iniciativas de restauração equivocadas de campos e savanas podem acabar prejudicando o ecossistema. Segundo Durigan, o foco das campanhas ecológicas no plantio de árvores acabou disseminando a ideia de que os campos naturais são áreas degradadas que perderam uma suposta floresta que ali existia. Uma reportagem do jornal norte-americano The New York Times relata que, em 2022, a organização não governamental (ONG) Eden People+Planet, daquele país, iniciou o plantio de árvores em alta densidade no norte de Goiás, o que pode prejudicar áreas preservadas de campos naturais. Em seu site, a ONG informa que tem um projeto ativo em Goiás, mas não detalha o andamento. Para in-
formar também o público não acadêmico sobre a ecologia dos campos abertos do Cerrado, Durigan fez parte da equipe que publicou, em 2024, o Manual para identificação e conservação das fisionomias abertas do Cerrado, disponível para download.
Indícios de que os campos são ambientes originais e antigos foram encontrados em arbustos que vivem dispersos pelos campos abertos. Quando queimados ou carcomidos por ruminantes, chegando ao ponto de quase desaparecer, suas raízes continuam vivas e são capazes de rebrotar. A cada ano, é nas raízes dessas plantas, e não nos caules destruídos pelo fogo, que reside o registro completo da idade dessas plantas, nos anéis de crescimento.
“A idade de um araçá-cinzento [Psidium grandifolium], uma planta típica do campo com cerca de 1 m de altura e frutos arroxeados, foi estimada em 136 anos”, relata a bióloga Claudia Fontana, pesquisadora em estágio de pós-doutorado no IPA e primeira autora de artigo publicado em janeiro na revista científica Dendrochronologia .
A equipe analisou 107 espécies de arbusto e subarbusto, totalizando 204 plantas, de 18 localidades de campo de Cerrado e de altitude nos estados de Goiás, Minas Gerais, São Paulo e Rio de Janeiro. Fontana conta que está usando técnica de dendrocronologia, complementada com radiocarbono, para datar as plantas e obteve resultados, ainda não publicados, que passam de 250 anos. “Esse achado sugere que campos nativos existem há mais de dois séculos e que, desde então, essas regiões foram cobertas por gramíneas, e não por árvores”, assinala. l
Os projetos e os artigos científicos consultados para esta reportagem estão listados na versão on-line.
Sons de espécies pouco conhecidas são registrados em águas profundas da bacia da foz do Amazonas
IGOR ZOLNERKEVIC

Até agora, apenas animais mortos encontrados em praias denunciavam, no país, a existência de baleias-bicudas, da família Ziphiidae. Agora uma equipe de zoólogos do Instituto Aqualie, da Universidade Federal de Juiz de Fora (UFJF) e da Universidade do Estado de Santa Catarina (Udesc) realizou o primeiro levantamento visual e sonoro desses animais, vivos, na costa brasileira. As observações ocorreram no extremo norte da bacia da foz do Amazonas, a cerca de 150 quilômetros (km) da costa do Amapá, próximo da área onde a Petrobras está perfurando um poço exploratório em busca de petróleo e gás natural.
A pesquisa foi financiada pela própria Petrobras, como um dos requisitos do Instituto Brasileiro do Meio Ambiente e dos Recursos Naturais Renováveis (Ibama) para a licença ambiental do empreendimento, concedida no último mês de outubro. Embora a biodiversidade dos man-
guezais e de outros ambientes costeiros da região seja relativamente bem conhecida, pouco se sabe sobre os animais que habitam seus 350 mil km² de águas oceânicas.
A estatal contratou a empresa de consultoria Mineral Engenharia e Meio Ambiente para organizar um projeto de monitoramento da vida marinha. Entre 2022 e 2023, especialistas em aves, tartarugas, baleias e golfinhos embarcaram oito vezes no Urano, um rebocador de 25 metros (m) de comprimento adaptado para pesquisa científica. Cada viagem durou cerca de 15 dias, partindo de Belém em direção ao alto-mar, até o norte do Amapá. A rota incluía 42 pontos por onde podem vir a circular navios de exploração petrolífera. Em uma plataforma no alto da embarcação, pesquisadores observavam continuamente a superfície do mar com binóculos e câmeras fotográficas, do nascer ao pôr do sol. Também mediam propriedades da água e faziam gravações acústicas. Em cada um dos pontos, o Urano desligava os motores e um microfone projetado para captar sons de cetáceos descia até 150 m,
gravando entre 30 e 60 minutos. Cetáceos são o grupo que engloba as 93 espécies conhecidas de baleias e golfinhos.
O biólogo Raphael Machado, estudante de doutorado orientado pelo zoólogo Artur Andriolo – professor da UFJF e diretor do Instituto Aqualie –, integrou o monitoramento de cetáceos. “Registramos vários golfinhos, como o golfinho-pintado-pantropical, o golfinho-rotador e o golfinho-de-dentes-rugosos”, ele conta. “Também baleias-piloto e um avistamento da baleia-jubarte.”
Nada, porém, chamou tanto a atenção quanto as baleias-bicudas. “Esperávamos encontrar uma ou outra, mas ficamos surpresos com a quantidade”, lembra Machado. Ao todo, foram quatro avistamentos delas descansando por poucos minutos na superfície, além de nove gravações acústicas com 1 a 22 minutos de duração. Apenas um dos relatos visuais coincidiu com uma gravação, mas foi rápido demais para ser fotografado.
Também chamadas de baleias-de-bico, as baleias-bicudas costumam ter um

par de dentes em forma de presas que medem entre 5 e 10 centímetros (cm) e um focinho alongado, semelhante ao dos golfinhos. Vivem em bandos de cinco a 10 indivíduos em todos os oceanos, exceto nas regiões polares. Embora formem a segunda família mais diversa dos cetáceos, com 24 espécies (atrás apenas dos golfinhos oceânicos, que têm 37 espécies), pouco se sabe sobre elas. O principal motivo é viverem longe da costa, fazendo mergulhos longos e profundos para caçar lulas, peixes e crustáceos. Em 2014, pesquisadores norte-americanos conseguiram implantar transmissores em algumas delas no sul da Califórnia, confirmando que podem permanecer quase duas horas submersas, atingindo profundidades próximas de 3 mil metros – dois recordes para mamíferos marinhos. Ficam pouco tempo n a superfície, raramente saltando ou fazendo outro movimento. Seu comportamento tímido é uma estratégia para e vitar chamar a atenção de seus principais predadores, as orcas.
Assim como as orcas e outros cetáceos com dentes, as baleias-de-bico também emitem estalidos ou cliques de ecolocalização – uma série de sons de alta frequência, inaudíveis ao ouvido humano, que refletem nos obstáculos ao seu redor e substituem a visão na escuridão do fundo do mar. Seus cliques, porém, têm uma característica peculiar. “As baleias-de-bico são as únicas que modulam a frequência sonora dos cliques enquanto nadam”, explica Machado.
Cada espécie vocaliza com uma frequência máxima que funciona como uma assinatura sonora, o que já permitiu a identificação só com base nas propriedades acústicas, em outros estudos. A biblioteca sonora desses cetáceos ainda tem muitas deficiências: um grupo de pesquisadores norte-americanos e mexicanos levou cinco anos para descobrir que gravações de 2020, na Baixa Califórnia, referiam-se à baleia-bicuda-de-ginkgo, uma espécie que nunca havia sido vista viva. Além disso, alguns sons de baleias-de-bico registrados nas
últimas duas décadas no Havaí, no golfo do México e na costa atlântica da África permanecem um completo mistério. Machado e colegas não conseguiram identificar todos os animais avistados. De acordo com os pesquisadores, um deles deve ser uma baleia-bicuda-de-gervais (Mesoplodon europaeus). As demais parecem pertencer à mesma espécie ou a duas outras, a baleia-bicuda-de-blainville (Mesoplodon densirostris) e a baleia-bicuda-de-cuvier (Ziphius cavirostris). As três são consideradas as mais comuns da costa brasileira.
Aanálise dos sons, no entanto, indica terem sido emitidos por três espécies diferentes, embora os registros acústicos não sejam idênticos aos obtidos em outras partes do mundo. Segundo Machado, variações geográficas são comuns. “A frequência de pico da baleia-bicuda-de-cuvier pode ser uma no Pacífico e outra no Atlântico, onde os animais enfrentam pressões ecológicas diferentes”, explica ele, que não descarta a possibilidade de serem espécies ainda não descritas. “Mas como não existe registro acústico confirmado no Brasil de espécie identificada, tomamos o cuidado de não atribuir os sons a nenhuma delas.”
“Não sabemos quase nada sobre as baleias-bicudas no Brasil”, afirma o zoólogo Eduardo Secchi, da Universidade Federal do Rio Grande (Furg) e autor de um guia de identificação de cetáceos, que não participou do estudo. Secchi considera que uma pesquisa preliminar como essa traz informações importantes para o planejamento. “Esses estudos podem apontar áreas preferenciais para espécies dessa família e, portanto, ajudar no planejamento espacial de atividades humanas potencialmente impactantes.”
Baleias-de-bico são muito sensíveis às explosões sonoras usadas na prospecção sísmica de petróleo e gás. Estudos mostram que elas evitam áreas ruidosas e mudam seu comportamento. “Ainda há poucas pesquisas no Brasil sobre o impacto de atividades sísmicas nos cetáceos”, diz Machado, preocupado com o futuro. l
O artigo científico consultado para esta reportagem está listado na versão on-line.

Terapia gênica em dose única melhorou a capacidade de realizar movimentos de crianças e adolescentes com atrofia muscular espinhal
MARIANA CECI
Um tratamento em dose única aplicado na região lombar da coluna vertebral mostrou resultados promissores para tratar uma doença rara – a atrofia muscular espinhal (AME) – em crianças com mais de 2 anos e adolescentes. Uma versão anterior da terapia, administrada na corrente sanguínea, era indicada para menores de 2 anos. Na nova abordagem, o material que corrige o defeito genético causador da AME foi injetado entre as membranas que protegem a medula espinhal (administração intratecal), facilitando a sua chegada ao alvo.
A AME é uma doença genética irreversível, causada por um defeito que leva à perda de função das duas cópias (materna e paterna) do gene SMN1. Esse gene codifica uma proteína – a survival motor neuron , SMN – que promove a sobrevivência do neurônio motor. Sem ela, os neurônios motores da medula espinhal morrem e deixam de transmitir para os músculos os comandos do cérebro. Como consequência, ocorre uma perda pro-
Em boa forma
Introdução de cópia saudável de gene evita a morte de neurônios que levam os comandos do cérebro para os músculos
1 Uma cópia funcional do gene SMN1 é inserida em um tipo de vírus com atração pelos neurônios motores
2 Por meio de uma punção na coluna, médicos injetam a solução contendo os vírus geneticamente modificados entre os tecidos que envolvem a medula espinhal
3 Os neurônios motores incorporam a cópia saudável do gene SMN1 e passam a produzir a proteína codificada por ele
gressiva do tônus e da força muscular, e a criança apresenta problemas para manter o corpo ereto, sentar-se, segurar objetos, engolir e até mesmo respirar. Nos casos extremos, a AME leva à morte precoce, ainda na infância.
No novo tratamento proposto, um vírus modificado em laboratório para se tornar inofensivo transporta para as células da medula espinhal uma cópia saudável do SMN1. Em um teste com 126 participantes de 14 países, entre eles o Brasil, essa terapia gênica melhorou de modo significativo a capacidade de crianças e adolescentes de manter a postura do corpo e realizar alguns movimentos. Os resultados foram apresentados em um artigo publicado em dezembro na revista Nature Medicine
Atualmente, há três tratamentos aprovados para AME. Todos tentam aumentar a disponibilidade da proteína SMN e estão entre as terapias mais caras do mundo. Dois deles são compostos que aprimoram o funcionamento do SMN2, uma espécie de gene reserva produt or de uma proteína similar à SMN1.
São o nusinersen, comercializado pelo laboratório norte-americano Biogen com o nome de Spinraza, e o risdiplam, vendido pela farmacêutica suíça Roche como Evrysdi. O primeiro é de administração intratecal, feita por meio de punções lombares periódicas, a um custo unitário de cerca de R$ 680 mil – após o primeiro ano de tratamento, o gasto anual fica na casa dos R$ 2 milhões. O segundo é feito por via oral e sai por R$ 1,3 milhão por ano. Ambos são terapias que precisam ser mantidas ao longo da vida para preservar os efeitos benéficos.
A terceira opção é a terapia gênica que agora foi testada em sua versão intratecal. Ela tem o nome técnico complicado de onasemnogene abeparvovec e é comercializada como Zolgensma pela empresa farmacêutica suíça Novartis. Usado em dose única, tem um custo estimado em quase R$ 7 milhões. Antes administrada via endovenosa a bebês e crianças de no máximo 21 quilos, ela usa um vírus geneticamente modificado – o AAV9 – para levar uma cópia funcional do gene SMN1 ao organismo. No ensaio clínico atual, os pesquisadores fizeram a aplicação intratecal do onasemnogene abeparvovec, o que permite ao vírus transportando a forma saudável do SMN1 chegar mais facilmente à medula espinhal, onde estão os neurônios motores – essa abordagem reduz a exposição de outros tecidos ao vírus. No Brasil, há cerca de 1,8 mil pessoas com AME, segundo o cadastro do Instituto Nacional de Atrofia Muscular Espinhal (Iname), e os três tratamentos são oferecidos pelo Sistema Único de Saúde (SUS). Por causa do custo elevado, tanto aqui quanto no exterior pesquisadores e for-
muladores de políticas públicas de saúde buscam identificar, entre as alternativas disponíveis, o tratamento que apresente a melhor relação entre custo e benefício. No trabalho publicado na Nature Medicine, a equipe liderada pelo neuropediatra Richard Finkel, do Hospital de Pesquisa Infantil Saint Jude, no Tennessee, Estados Unidos, avaliou a segurança e o desempenho da terapia gênica intratecal em crianças e adolescentes com idade entre 2 e 17 anos e 11 meses atendidas em 29 centros de 14 países. No Brasil, participaram equipes do Hospital das Clínicas da Faculdade de Medicina da Universidade de São Paulo (FM-USP), na capital paulista, do Hospital Erastinho, em Curitiba, no Paraná, do Hospital de Clínicas de Porto Alegre, no Rio Grande do Sul, e do Hospital de Clínicas da Universidade Estadual de Campinas (Unicamp), no interior de São Paulo.
Os 126 integrantes do estudo tinham AME e nunca haviam recebido tratamento. Eles começaram a apresentar os sintomas da doença menos de seis meses antes da inclusão no estudo e eram capazes de se sentar, mas não de caminhar de modo independente. Dos participantes, 75 receberam a aplicação do medicamento por meio de uma punção lombar. Os outros 51 integraram o grupo de controle. Nestes, os pesquisadores realizaram uma perfuração mais superficial, sem a injeção de líquido. Todos estavam sob efeito de anestesia durante o procedimento.
“Como o número de neurônios motores é definido desde o nascimento [cada indivíduo nasce com um certo número dessas células, que não se multiplicam nem são repostas ao longo da vida], a dose do tratamento por via intratecal é fixa”, conta a neurologista Adriana Banzzatto Ortega, do Hospital Pequeno Príncipe, uma das autoras do estudo. “Na versão endovenosa do Zolgensma, a dosagem varia de acordo com o peso porque o tratamento é transportado pelo sangue e se distribui por todo o corpo”, explica.
Depois de administrada a terapia gênica ou o procedimento placebo, os pesquisadores acompanharam a evolução dos participantes por um ano. O desempenho dos dois grupos foi medido por uma es-
cala que avalia habilidades motoras, como o controle do tronco, a capacidade de se sentar e de realizar movimentos voluntários. No primeiro mês após o procedimento, as crianças e adolescentes t ratadas com a terapia gênica intratecal apresentaram uma melhora modesta, mas significativa dos pontos de vista estatístico e clínico. Em média, o escore deles foi 2,4 pontos mais elevado do que antes do tratamento. Esse efeito durou todo o período de acompanhamento. Já no grupo de controle, a melhora foi de 0,5 ponto. Esses valores são medidos em uma escala que vai de zero a 66 pontos, sendo zero o indicador de incapacidade de realizar atividades de modo independente, e 66 o de a lta habilidade motora, como andar sem ajuda de outras pessoas. Se aprovado pela Agência Nacional de Vigilância Sanitária (Anvisa), o tratamento intratecal terá seu custo determinado mais adiante no país. “Sem tratamento, os pacientes costumam apresentar uma redução média a nual de cerca de 2 pontos na escala de mobilidade usada no estudo”, conta Ortega. “Com a terapia, além de estabilização, houve o ganho de 1 a 2 pontos. Isso tem impacto na autonomia dessas crianças e adolescentes, permitindo realizar atividades como se transferir da cadeira de rodas para a cama”, completa.
Com relação à segurança, o perfil de efeitos adversos foi semelhante nos dois grupos. Os eventos mais frequentes foram infecções respiratórias leves, febre e vômito. “A observação de poucos efeitos adversos após um ano é um sinal positivo, mas são necessários estudos de acompanhamento mais robustos para confirmar se a nova via de administração pode se revelar uma alternativa mais eficaz do que as terapias já disponíveis”, afirma a neurologista Alzira Siqueira de Carvalho, da Faculdade de Medicina do ABC (FMABC), que não fez parte do estudo. Ela coordena o Ambulatório de Doenças Neuromusculares da FMABC e participou de pesquisas no exterior mostrando que a identificação precoce da AME e o início rápido do tratamento são fundamentais para melhorar a evolução da criança. “Tratar antes do aparecimento dos sintomas é o que realmente impede a progressão da doença”, explica. l
O artigo científico consultado para esta reportagem está listado na versão on-line.

Cisne-negro, uma das espécies infectadas com o vírus no zoológico de Sapucaia
no
Vírus causador da gripe aviária de alta patogenicidade entrou no Brasil por duas rotas migratórias em 2025 e se espalhou por áreas distantes da costa
RICARDO ZORZETTO
Em maio de 2025, os produtores brasileiros de ovos e carne de frango levaram um susto que gerou apreensão. No dia 11 daquele mês, trabalhadores de uma granja comercial em Montenegro, um município de 66 mil habitantes no Rio Grande do Sul, reportaram às autoridades sanitárias a morte de várias aves, levantando a suspeita de infecção por uma variedade agressiva do vírus causador da gripe aviária. Na propriedade eram criadas matrizes pesadas, galos e galinhas geneticamente selecionados para gerar ovos férteis usados na produção de frangos de corte. Técnicos do Serviço Veterinário Oficial (SVO), órgão federal responsável pela sanidade animal, foram à cidade no dia seguinte, colocaram a propriedade em quarentena e coletaram amostras de secreções e tecidos das aves mortas. Em apenas três dias, 92% de 17.008 galos e galinhas da granja adoeceram e morreram. Os demais foram eliminados para evitar o risco de transmissão, assim como os ovos produzidos um pouco antes, que haviam sido distribuídos para três estados brasileiros. Nas semanas seguintes, a granja passou por um rigoroso processo de limpeza e desinfecção, enquanto outras 94 propriedades em um raio de 10 quilômetros foram submetidas a vistoria. O caso de Montenegro foi o primeiro no país – e, por ora, o único – de infecção de aves de um estabelecimento comercial pelo vírus da influenza A H5N1 de alta patogenicidade, causador de uma forma
bastante grave e letal de gripe aviária. A confirmação laboratorial da doença, divulgada no dia 16 daquele mês, levou a China e os países da União Europeia a suspenderem temporariamente a importação de carne de frango do Brasil, o segundo maior produtor e o maior exportador do produto no mundo, ao passo que outras nações impuseram restrições apenas à produção do Rio Grande do Sul. “A identificação em aves comerciais foi pontual no Brasil”, afirma a virologista Helena Lage Ferreira, da Universidade de São Paulo (USP), que estuda vírus que afetam animais e colabora com os ministérios da Agricultura e Pecuária, da Saúde e da Ciência, Tecnologia e Inovação em questões relacionadas à gripe aviária. “Desde o caso ocorrido no Rio Grande do Sul, não houve outro”, conta. A doença, no entanto, continua a afetar criações domésticas de aves.
Auditores fiscais agropecuários do Laboratório Federal de Defesa Agropecuária ( LFDA) em Campinas, interior de São Paulo, e do LFDA em Pedro Leopoldo, Minas Gerais, sequenciaram o genoma do vírus de Montenegro e constataram que ele pertencia à mesma variedade que surgira três meses antes na Argentina. O material genético de ambas é composto por uma combinação única dos genes de três linhagens do vírus: uma que se disseminou pela Europa e pela Ásia, outra encontrada na América do Norte e uma terceira surgida na América do Sul. Na semana do surto na granja comercial, a mesma variedade do H5N1 com material genético de origem tripla chegou ao zoo -
Estados com surtos de gripe aviária em 2025
Variedades do vírus da influenza A H5N1 chegaram ao Brasil por rotas distintas e atingiram sete espécies de aves
Espécies infectadas pela variedade vinda pela América Central ou Caribe
• Galinha (Gallus gallus)
• Galinha-d'angola (Numida meleagris)
• Irerê (Dendrocygna viduata)
• Cisne-negro (Cygnus atratus)
• Ema (Dromaius novaehollandiae)
Espécies infectadas pela variedade vinda da região sul da América do Sul
• Galinha (Gallus gallus)
• João-de-barro (Furnarius rufus)
• Cisne-negro (Cygnus atratus)
• Cisne-de-pescoço-preto (Cygnus melancoryphus)
lógico de Sapucaia do Sul, município a 33 quilômetros a sudeste de Montenegro, onde matou quase 170 aves – a maioria patos e cisnes, em particular os cisnes-negros (Cygnus atratus) e os cisnes-de-pescoço-preto (Cyg nus melancoryphus).
A semelhança entre os genomas do vírus da Argentina e do Rio Grande do Sul foi descrita por pesquisadores do LFDA, em parceria com colaboradores da Universidade Federal de Minas Gerais (UFMG), em um artigo publicado na edição de fevereiro da revista Virology e divulgado on-line em 27 de novembro passado. Ela sugere que a variedade que causou os dois surtos de 2025 no Sul do Brasil chegou ao país trazida por aves silvestres que percorrem uma rota migratória pelo sul do continente, vindas da costa do Pacífico. Essa variedade também guarda proximidade genética com a que circulou tempos atrás no Chile e em 2023 e 2024 causou surtos de gripe em aves migratórias marinhas e aves domésticas em uma faixa litorânea que vai do sul da Bahia ao Rio Grande do Sul (ver Pesquisa FAPESP nº 332), sem atingir cidades longe da costa. A variedade responsável pelos dois surtos do Rio Grande do Sul, no entanto, não foi a única a entrar no Brasil em 2025. A análise de 274 amostras de secreções e tecidos de aves coletadas entre janeiro e outubro do ano passado permitiu aos autores do artigo da Virology concluir que uma segunda variedade do vírus, geneticamente semelhante ao precursor do H5N1 que circulou no gado leiteiro dos Estados Unidos, chegou ao país vinda por outra rota. “Essa variedade parece
ter sido trazida ao Brasil por aves que migraram do hemisfério Norte para cá via América Central ou Caribe”, comenta o microbiologista Aristóteles Góes-Neto, da UFMG, coautor do estudo da Virology.
Avariedade norte-americana causou outros 17 surtos de gripe aviária (oito em aves silvestres e nove em criações de subsistência), distribuídos pelas regiões Sudeste, Centro-Oeste e Nordeste (ver mapa na página 59). Enquanto a que circulou pelo Sul se mostrou capaz de atingir o sistema nervoso central e causar danos neurológicos, deixando as aves desorientadas e com dificuldade de comer, o vírus que penetrou no interior infectou, além de galinhas (Gallus gallus) e galinhas-d’angola (Numida meleagris), aves silvestres como irerês (Dendrocygna viduata), emas (Dromaius novaehollandiae) e cisnes-negros, provocando problemas gastrointestinais.
“Houve uma interiorização do vírus, que está se dispersando por um número maior de espécies, entre elas as de aves aquáticas residentes no país, que têm capacidade de migrar por 200 ou 300 quilômetros e espalhá-lo regionalmente”, comenta Ferreira, que desenvolve pesquisas com o vírus, mas não participou do estudo publicado na Virology
A segunda variedade introduzida no país apresentava combinações gênicas ainda mais diversas. Foram identificadas 11, nenhuma registrada antes na América do Sul. Em geral, eram compostas por

parte dos genes semelhante ao do vírus que infectou o gado norte-americano e parte de origem indeterminada, às vezes de variedades do vírus de baixa patogenicidade. “Esses dados nos deixam em alerta”, diz Góes-Neto. “Ainda não se sabe se os vírus que resultam dessas combinações são mais agressivos.”
O material genético do vírus da influenza é composto por oito segmentos de genes de RNA (ácido ribonucleico). Ele é propenso a sofrer um tipo específico de rearranjo que envolve a troca de genes inteiros e só ocorre quando ao menos duas variedades infectam uma mesma célula. “Os achados desse estudo indicam que o vírus da gripe aviária continua circulando em aves silvestres na América do Sul e trocando material genético com outros vírus”, afirma Ferreira. Como há poucos dados sobre a influenza de baixa patogenicidade no Brasil, ela explica, não é possível conhecer onde ocorreram essas novas combinações.
“Nossos resultados destacam a complexidade da ecologia e da dinâmica de transmissão da influenza aviária e ressaltam a importância da vigilância genômica descentralizada e contínua”, escreveram os autores no artigo da Virology. Eles concluem com um alerta: “A detecção precoce e a caracterização sistemática de variantes emergentes são essenciais para mitigar os impactos na saúde animal, na produção avícola e nos potenciais riscos à saúde pública”. l


Consumo de drogas ilícitas cresceu cerca de 80% no Brasil de 2012 a 2023, puxado pelo aumento no uso de maconha e derivados
MARIANA CECI
Ouso de drogas ilícitas no Brasil aumentou, em média, 80% em pouco mais de uma década. De 2012 a 2023, a proporção de pessoas que experimentaram alguma substância psicoativa de uso proibido ao menos uma vez na vida passou de 10,3% para 18,7%. No mesmo período, a taxa de consumo recente desses compostos subiu de 4,5% para 8,1% (ver gráfico na página 62). Divulgados em dezembro, esses dados integram o caderno temático sobre o consumo de cannabis e outras substâncias psicoativas do 3º Levantamento Nacional de Álcool e Drogas (Lenad III), conduzido por pesquisadores da Universidade Federal de São Paulo (Unifesp).
Durante o ano de 2023, entrevistadores da empresa Ipsos Public Affairs fizeram visitas domiciliares a 16.608 pessoas em 349 municípios de todas as regiões do país. Os participantes relataram se, como e quando haviam utilizado qualquer substância psicoativa ao preencher um questionário aplicado de modo sigiloso. Eles recebiam um tablet no qual anotavam diretamente a resposta ou, quando não sabiam ler ou escrever, registravam em um áudio anônimo a réplica às perguntas previamente gravadas. Os questionários traziam os nomes coloquiais dos compostos, em geral empregados pelos usuários, para facilitar o reconhecimento das drogas. Nessa avaliação, não foram contabilizados o consumo de álcool e produtos à base de nicotina.
e derivados da cannabis são as drogas mais usadas pelos brasileiros
Nessa edição do Lenad, a equipe liderada pela psicóloga Clarice Sandi Madruga, da Unifesp, aferiu a taxa de experimentação e de consumo recente de 16 drogas ilícitas no país por meio de entrevistas realizadas com uma amostra representativa da população brasileira maior de 14 anos. Essa é a segunda edição do levantamento que coleta dados sobre o consumo de drogas e de outras substâncias psicoativas, compostos que modificam o funcionamento do sistema nervoso central e alteram o humor, as emoções ou a percepção da realidade e são de comercialização proibida.
A maconha e outros derivados da cannabis, como o skank e o haxixe, são de longe as drogas mais usadas no país. Também são as que mais contribuíram para o aumento observado no consumo de substâncias psicoativas ilícitas. Em 2023, quase um em cada seis brasileiros (15%) afirmaram já ter provado pelo menos uma vez na vida algum produto obtido a partir da cannabis, um crescimento de uma vez e meia em relação aos 6,2% registrados em 2012, no Lenad II. Entre uma e outra edição do levantamento, o consumo no último ano, um indicador de uso atual, passou de 2,8% para 6%.
Consumo geral aumentou, em média, 80%, mas crescimento foi mais elevado entre mulheres
A segunda droga mais utilizada foi a cocaína. Em 2023, 5,4% dos participantes relataram já ter experimentado alguma vez na vida, um aumento de 39% em relação a 2012. A proporção que afirmou ter feito uso recente permaneceu estável nos dois períodos, 1,8%. Na sequência, as substâncias psicoativas mais consumidas foram os estimulantes do grupo das anfetaminas; os inalantes à base de solventes, como lança-perfume, cola de sapateiro, entre outros; e o ecstasy (ver gráfico na página 63). O uso de crack permaneceu relativamente baixo – cerca de 1,4% já experimentou e 0,5% fumou no último ano – e concentrado em grupos específicos, sem sinais de expansão recente.
As maiores proporções de usuários estão nos estados do Sul, Sudeste e Centro-Oeste. Nessas regiões, a prevalência de experimentação e de consumo recente foram, respectivamente, 25,4% e 8,7% (Sul); 19,7% e 9,2% (Sudeste); e 18,5% e 8,7% (Centro-Oeste). O levantamento mostra ainda que o uso dessas drogas está concentrado nos jovens e nos adultos com menos de 50 anos. Em 2023, 27,4% das pessoas com idade entre 18 e 24 anos já haviam experimentado e 16,3% utilizado no último ano. Na faixa etária que vai dos 25 aos 49 anos, esses números foram, respectivamente, de 22,8% e 9,3%. A partir daí, os percentuais diminuem mais.
Homens ainda consomem mais do que mulheres, embora tenha ocorrido um crescimento proporcionalmente maior entre elas. No sexo masculino, a prevalência de experimentação cresceu 71%. Passou de 14% (2012) para 23,9% (2023). No feminino, o aumento foi de 99%, subiu de 7% para 13,9%. Elevação semelhante foi observada no consumo recente: cresceu de 6,5% (2012) para 10,8% (2023) entre os homens e de 2,7% para 5,6% entre as mulheres.
Os pesquisadores do Lenad III notaram um fenômeno curioso no que diz respeito ao uso recente de maconha e outros derivados de cannabis por adolescentes. O consumo diminuiu entre os jovens do sexo masculino com idade entre 14 e 18 anos: a prevalência era de 5,7% (2012) e baixou para 2,3% (2023). No feminino, observou-se o inverso. Aumentou três vezes e meia entre as adolescentes dessa faixa etária, saltando de 1,3% (2012) para 4,6% (2023). “O crescimento do consumo entre as meninas acompanha tendências observadas em outros países, nos quais as diferenças entre os sexos tendem a se reduzir ao longo da adolescência”, conta Madruga. No caso dos adolescentes do sexo masculino, a queda pode estar associada a mudanças nos padrões de lazer e comportamento. “Uma hipótese é a maior concorrência de outras atividades de forte apelo entre os jovens, como jogos, incluindo os aplicativos de apostas on-line”, avalia a pesquisadora (ver Pesquisa FAPESP nº 351).
Os pesquisadores associam o aumento no consumo por adolescentes e adultos de maconha e outros produtos contendo cannabis a dois fatores: a percepção de facilidade de acesso e de que é baixo o risco relacionado ao uso. Os pesquisadores mediram esses fatores ao aplicar um questionário específico a 4.732 entrevistados. Os resultados, antecipados com exclusividade para Pesquisa FAPESP, mostram que 70% dos adultos e 52% dos adolescentes acham fácil obter maconha. Para 60% do primeiro grupo e 42% do segundo, consegue-se acesso a solventes com facilidade, enquanto 57% e 36% pensavam o mesmo sobre a cocaína e 52% e 30% sobre o crack.
Adultos e adolescentes se mostraram condescendentes com a experimentação da maconha. Uma em cada quatro pessoas com mais de 18 anos e uma em cada três na faixa etária dos 14 aos 18 anos disseram que o risco de experimentar maconha e outros produtos da cannabis era baixo

ou inexistente. As taxas foram sempre inferiores a 10% para outras drogas. No que diz respeito ao uso regular de maconha, a percepção de risco baixo ou inexistente diminuiu para 8,8% entre adultos e 8,4% entre adolescentes. Entre aqueles que consumiram maconha no último ano, 76% dos adultos e 59% dos adolescentes diziam que o risco era baixo ou inexistente. Entre os usuários regulares, esses números foram, respectivamente, 44% e 49%.
“Muitas pessoas consomem maconha, que tem altos teores de THC [tetrahidrocanabinol], o principal composto psicoativo dessa droga, pensando estar fazendo uso medicinal da cannabis”, comenta Madruga. O levantamento indica que os adolescentes consomem cannabis na forma de cigarro (64%), cachimbos de água ou bongs
Números mostram como evoluiu a utilização de nove drogas ilícitas no Brasil no período
Estimulantes
Anestésicos
*Inclui outros derivados de cannabis
(11%) ou charutos (6%). “Os componentes da cannabis com ação medicinal não estão presentes nessas apresentações”, explica. “É comum ver jovens utilizando-as para tratar problemas como ansiedade, quando, na realidade, elas podem agravá-los ou até gerar outros problemas de saúde mental”, relata.
“A percepção de risco do adolescente para a maior parte das drogas costuma ser mais branda do que a dos adultos. Para os jovens, os problemas que as drogas podem causar parecem muito distantes”, diz o psiquiatra João Mauricio Castaldelli-Maia, da Universidade de São Paulo (USP), que não participou do Lenad, mas investiga como os jovens lidam com situações de risco. Na visão dele, o consumo de drogas funciona como um sinal de alerta para outros comportamentos perigosos.
Em um estudo publicado em agosto na revista International Review of Psychiatry, Castaldelli-Maia e colaboradores avaliaram a relação entre o uso recente de drogas e a iniciação sexual precoce em um grupo de 72,7 mil adolescentes brasileiros com idades entre 15 e 17 anos. De modo geral, o uso de substâncias psicoativas aumentou entre 47% e 91% a probabilidade de iniciar a vida sexual antes dos 15 anos. De acordo com os autores, os resultados reforçam a ideia de que o uso de drogas na adolescência não ocorre de forma isolada e se insere em um conjunto mais amplo de comportamentos associados à impulsividade, à menor percepção de risco e maior exposição a contextos adversos.
Para a epidemiologista Zila Sanchez, chefe do Departamento de Medicina Preventiva da Unifesp, estratégias eficazes de prevenção ao uso de drogas se apoiam em três eixos complementares: o desenvolvimento de habilidades que fortalecem a autonomia e a tomada responsável de decisões, a oferta de informações qualificadas sobre as substâncias e seus efeitos e o enfrentamento das crenças normativas que orientam o uso (por exemplo, se é socialmente aceitável).
Segundo Sanchez, os programas de prevenção não são voltados a uma substância específica, mas à redução de comportamentos de risco de forma geral. “Nesse contexto, o álcool é o foco inicial, por ser a substância mais consumida pelos adolescentes e geralmente a primeira na trajetória de uso. Ao prevenir o uso precoce de álcool, estamos reduzindo a chance de progressão para as drogas ilícitas, como a maconha”, explica. l
Os projetos e os artigos científicos consultados para esta reportagem estão listados na versão on-line.
Partículas freiam e perdem energia da mesma forma na água líquida e no gelo amorfo, descoberta importante para terapia contra o câncer
IGOR ZOLNERKEVIC

Entender como um feixe de prótons freia e deposita a maior parte de sua energia ao entrar em contato com um meio aquoso pode ser útil não só para o avanço do conhecimento básico, mas também para estudos e aplicações em áreas tão distintas como a medicina e a astrofísica. Essa é a contribuição principal de um artigo publicado em outubro de 2025 na revista Physical Review Letters, coordenado por pesquisadores do Brasil, com a participação de colegas da Espanha e da Austrália.
O trabalho empregou um novo método para determinar com precisão como os prótons desaceleram e perdem sua energia quando atravessam quatro fases (estados) da água: a líquida, o vapor, o gelo cristalino hexagonal, como o formado na geladeira, na neve e nas geleiras, e o gelo amorfo (um sólido constituído por moléculas de água desorganizadas, produzido em condições especiais em laboratório e no espaço). A conclusão do estudo é de que essas partículas subatômicas com
carga elétrica positiva interagem exatamente da mesma forma em duas fases distintas da água.
“Os prótons perdem energia na água líquida e no gelo amorfo de maneira equivalente”, diz o físico Flávio Matias, que faz pós-doutorado no Instituto de Pesquisas Energéticas e Nucleares (Ipen), em São Paulo, autor principal do estudo. O resultado abre a possibilidade de substituir, em experimentos realizados no vácuo, os jatos de água por placas de gelo amorfo, cuja espessura varia muito menos e facilita a realização de estudos. Também pode fornecer dados mais precisos para o aprimoramento de um tipo de tratamento que usa a energia das partículas subatômicas para combater certos tipos de câncer.
Na astronomia, os dados do trabalho podem, ainda, ser de grande valia. Poeira interestelar, cometas e outros corpos celestes gelados contêm grandes quantidades de gelo amorfo, que constantemente é atravessado por raios cósmicos compostos principalmente de prótons. A energia dessas partículas desencadeia reações químicas
Aparelho de protonterapia contra o câncer
no gelo que produzem compostos orgânicos relevantes para o estudo da origem da vida. Um cálculo mais preciso de como os prótons freiam no gelo amorfo pode melhorar as simulações dessas reações realizadas pelos astrofísicos.
Um tipo de radioterapia avançada, ainda não empregada no Brasil, a protonterapia utiliza feixes com milhões de prótons, disparados por um acelerador de partículas, para atingir em cheio minúsculos tumores que crescem em órgãos vitais extremamente sensíveis, como o cérebro, a medula óssea e os olhos. Quando desaceleram e param, os prótons transferem sua energia para o meio ou tecido que acabaram de atravessar. Por isso, conhecer em detalhes como esse processo se dá é uma forma de refinar o tratamento e garantir que as partículas depositem sua energia apenas nos tumores, e não em tecidos sadios vizinhos.
A precisão milimétrica desse procedimento, entretanto, ainda tem muito a melhorar, tanto para minimizar os riscos aos pacientes quanto para a mpliar sua aplicação a diferentes tipos de tumores. Um dos principais obstáculos é que os físicos a inda não conseguem medir com grande acurácia a capacidade de a água e de outras substâncias do corpo humano frear os prótons até eles pararem. “A incerteza sobre o comportamento dos prótons ao perderem energia ao atravessar o corpo humano é um ponto cego fundamental da protonterapia”, afirma Joel Mesa Hormaza, físico nuclear especializado na área médica da Universidade Estadual P aulista (Unesp), campus de Botucatu, que não participa da equipe que produziu o artigo. “Embora tenha se concentrado na água pura, o estudo estabelece uma base sólida para incorporar, no futuro, a complexidade do corpo humano.”
O trabalho começou quando Matias participava de um projeto do Ipen para medir o efeito de feixes de prótons em phantoms – simuladores de tecidos do corpo humano, feitos de água e acrílico. Ele percebeu que havia grande imprecisão nos dados de laboratório sobre como essas partículas freiam na água. Havia dificuldade de obter o chamado poder de freamento dos prótons nos experimentos, nos quais um feixe dessas partículas atravessa um meio material qualquer, por exemplo, tecidos do corpo humano.
Além do problema experimental, havia também uma dificuldade de cálculo. Em princípio, calcular exatamente o poder de freamento exigiria considerar a interação de um próton com cada elétron das moléculas de água ao longo do caminho. Alguns modelos teóricos já conseguiram simplificar essas interações a ponto de realizar os cálculos em supercomputadores, mas seus resultados não descrevem bem a região próxima ao fim da trajetória do próton, onde ele libera a maior parte de sua energia. Conhecida como pi-
co de Bragg, é essa descarga final de energia que provoca a morte das células cancerígenas na protonterapia, ao induzir quebras duplas na molécula de DNA. Subestimar ou superestimar a energia do pico, assim como errar a sua localização, pode causar danos aos tecidos sadios dos pacientes. Matias então se uniu ao seu ex-orientador de doutorado, o físico Pedro Luis Grande, da Universidade Federal do Rio Grande do Sul (UFRGS), para desenvolver um novo método de cálculo do poder de freamento de prótons na água e em outros materiais na região do pico de Bragg. Inicialmente, foi gerado um conjunto de resultados teóricos sobre o poder de freamento de prótons em um gás com elétrons livres e diferentes densidades. Essa etapa exigiu meses de processamento em supercomputadores. Por quase um ano, o grupo utilizou parte do poder computacional do cluster Sampa, instalado no Instituto de Física da Universidade de São Paulo (IF-USP) e financiado pela FAPESP.
Com esse banco de dados em mãos, os cálculos de poder de freamento podem ser estendidos a praticamente qualquer material (em diferentes estados e estruturas), desde que se forneça a função de perda de energia. Tal grandeza indica como os elétrons do material respondem às excitações. Essa função pode ser obtida por modelagem teórica ou por técnicas experimentais baseadas em microscopia eletrônica.
Em abril de 2024, em um artigo publicado na Scientific Reports, Matias, Grande e oito colaboradores demonstraram esse método pela primeira vez em polímeros orgânicos, incluindo o acrílico. O passo seguinte foi o trabalho mais recente com as quatro fases da água. Nesse estudo, os parceiros espanhóis das universidades de Múrcia e Alicante, que são especialistas na modelagem de funções de perda de energia, forneceram as descrições eletrônicas necessárias para aplicar o método de forma consistente em diferentes estruturas do mesmo material.
Os estudos sobre como os prótons perdem energia na água pura são apenas o começo de uma série de trabalhos com o método. Os pesquisadores planejam realizar experiências semelhantes em que, no lugar da água, utilizem a molécula do DNA, lipídios, proteínas, ossos e talvez até células inteiras imersos em gelo amorfo. Os experimentos deverão ser realizados pela equipe do colaborador de Matias, o físico Tiago Fiorini da Silva, do Laboratório de Análises de Materiais por Feixes Iônicos do IF-USP. l
Os projetos e os artigos científicos consultados para esta reportagem estão listados na versão on-line.

Carro voador da Eve, subsidiária da Embraer, faz primeiro voo e inicia testes visando à homologação do modelo; lançamento comercial está previsto para 2027
YURI VASCONCELOS
Cerca de 10 anos após anunciar a intenção de construir um veículo elétrico de decolagem e pouso vertical (eVTOL), aeronave conhecida como carro voador, a Embraer realizou em 19 de dezembro o primeiro voo do protótipo em escala real, dando início à fase de testes em voo. O aparelho da Eve Air Mobility, startup de mobilidade aérea urbana criada pela fabricante brasileira, fez um voo pairado e remoto (sem piloto a bordo), com aproximadamente um minuto de duração, no complexo de testes de Gavião Peixoto, unidade da Embraer no interior paulista.
Com o objetivo de obter a certificação do aparelho na Agência Nacional de Aviação (Anac), a empresa planeja realizar centenas de voos com o protótipo este ano. A certificação comprova que o eVTOL é seguro para voar e operar comercialmente em larga escala, atendendo critérios de desempenho, gerenciamento de energia, emissões, entre outros. Se tudo correr como o planejado, o carro voador deverá entrar em operação comercial em 2027.
A carteira de intenções de compra do modelo gira hoje em torno de 3 mil unidades. O custo da aeronave é estimado em aproximadamente US$ 1,5 milhão (cerca de R$ 8 milhões). “A conversão das intenções de compra em contratos firmes depende de marcos importantes de credibilidade, como a realização do primeiro voo”, destaca Luiz Valentini, diretor de Tecnologia da Eve.
Durante o voo inaugural, foi testada a integração de sistemas essenciais da aeronave, como o conceito de fly-by-wire (sistema de controle de voo por computador) de quinta geração e os rotores (ou hélices) dedicados ao voo vertical. Também

foram avaliados o gerenciamento de energia, a resposta dinâmica da aeronave e o nível de ruído.
Híbrido de avião e helicóptero, o eVTOL é uma nova modalidade de transporte aéreo ainda em desenvolvimento no mundo todo. Eles são considerados uma alternativa mais sustentável para a mobilidade aérea em centros urbanos. Dotad0s de motores elétricos e forte automação, decolam e pousam na vertical, como os helicópteros, e fazem voos de cruzeiro na horizontal, como os aviões. São projetad0s para realizar trajetos curtos, de 20 a 100 quilômetros, em cidades ou entre municípios próximos.
O protótipo da Eve fez o chamado hover flight, situação em que o eVTOL permanece imóvel no ar sobre um ponto fixo no solo, mantendo altitude e posição constantes. O voo, segundo a Eve, foi um sucesso. “Validamos elementos críticos. Agora seguimos para a fase de testes em voo com foco em evoluir a maturidade do produto”, declarou na ocasião Jorge Bittencourt, diretor de Produto da Eve. “O comportamento do protótipo em voo ficou dentro do esperado, conforme previsto pelos nossos modelos e em linha com os objetivos dessa etapa inicial”, completou Valentini. “Com esses dados, ampliaremos o envelope da aeronave e avançaremos para o voo de transição sustentado pelas asas.”
O envelope de voo mencionado por Valentini caracteriza os limites operacionais seguros de uma aeronave, ou seja, a faixa de parâmetros de operação na qual não há danos estruturais ou perda de controle. “Esses parâmetros incluem a velocidade mínima e máxima, a maior aceleração que a aeronave pode desenvolver durante manobras, a qual altitude chega, o peso que consegue carregar”, explica o engenheiro mecânico Domingos Rade, do I nstituto Tecnológico de Aeronáutica (ITA), em
O voo pioneiro do aparelho ocorreu em dezembro de 2025. Na página ao lado, protótipo em escala real do eVTOL durante feira de aviação na Inglaterra, em 2024
São José dos Campos (SP). “Isso significa que os testes já realizados cobriram uma parte limitada do envelope de voo definido no projeto.”
Segundo Rade, que coordena o Centro de Pesquisa em Engenharia para a Mobilidade do Futuro (Flymov), criado em 2023 pela FAPESP e a Embraer, o primeiro voo de um protótipo é de extrema importância porque, além de marcar a finalização da primeira parte do programa de desenvolvimento, permite avaliar diversas premissas adotadas no projeto, bem como verificar o funcionamento integrado de sistemas relevantes. “No caso do aparelho da Eve, mesmo em voo pairado e com pilotagem remota, os testes permitem avaliar a performance dos propulsores elétricos, do fluxo de energia e gerenciamento térmico das baterias, o comportamento dos sistemas de controle, entre outros”, diz o pesquisador do ITA.
Oengenheiro mecânico Marcelo Alves, do Departamento de Engenharia Mecânica da Escola Politécnica da Universidade de São Paulo (Poli-USP), avalia que o voo de dezembro foi um marco crítico na campanha de desenvolvimento do eVTOL. “Valida a arquitetura básica do produto, confirma a integridade estrutural e os sistemas de controle em condições reais”, diz. “Com esse voo experimental, a Eve demonstrou que o protótipo é capaz de operar de forma segura em um ambiente controlado, pavimentando o caminho para testes mais avançados e a certificação.”
Para dar sequência à campanha de ensaio em voo, a Eve construirá seis protótipos de certificação em sua fábrica em Taubaté (SP). “O uso de seis aeronaves permitirá realizar em paralelo atividades de teste, reduzir gargalos e aumentar a
Modelo conta atualmente com 3 mil intenções de compra
eficiência do programa rumo à certificação”, destaca Valentini. De acordo com ele, cada protótipo pode se dedicar a objetivos específicos, o que ajuda a acelerar o aprendizado e a evolução do projeto.
“Empregar múltiplos aparelhos em uma campanha oferece vantagens significativas”, destaca Alves, que é também diretor do Centro de Engenharia Automotiva da Poli-USP. Ao fazer testes paralelos, a empresa poderá acelerar a coleta de dados e diminuir o tempo de desenvolvimento, ressalta o engenheiro. “Outro benefício-chave é a possibilidade de ensaiar configurações distintas simultaneamente, como variações em sistemas de propulsão, aerodinâmica ou software”, declara.
DESAFIOS PELA FRENTE
Apesar do sucesso do voo inaugural, vários desafios ainda precisam ser superados para que o carro voador da Eve possa ser visto cruzando os céus das cidades brasileiras. A principal dificuldade para obtenção da certificação na Anac e em suas congêneres estrangeiras, como a Administração Federal de Aviação (FAA), dos Estados Unidos, e a Agência Europeia para a Segurança da Aviação (Aesa), envolve a novidade que representa essa modalidade de aeronave. Isso, explica Alves, exige a criação de novos padrões regulatórios para segurança, aeronavegabilidade e integração com o espaço aéreo urbano.
“O processo de certificação ainda não está totalmente maduro. Não são conhecidos todos os requisitos que os fabricantes terão que cumprir”, complementa o engenheiro mecânico especialista em aerodinâmica Fernando Catalano, do Departamento de Engenharia Aeronáutica da Escola de Engenharia de São Carlos (EESC) da USP. Outros obstáculos para que os carros voadores se tornem realidade no país são a construção
As asas fixas tornam o voo de cruzeiro mais eficiente do que o de helicópteros
Aparelho terá capacidade para 5 ocupantes, sendo 1 piloto e 4 passageiros
FONTE EMBRAER / EVE
a bateria e totalmente elétrico, tem baixo nível de emissões de poluentes e de ruído
É dotado de oito rotores dedicados ao voo vertical e uma hélice traseira
Com velocidade máxima de 200 km/h, é projetado para viagens curtas de até 100 km 15 metros 12 metros


A aeronave vista por dentro: detalhes dos assentos para os passageiros, do rotor para voo vertical e do painel de controle (em sentido horário)


de uma rede de vertiportos – nome dado às bases para pouso e decolagem dos eVTOL em aeroportos, terminais de transporte, shopping centers etc. –, a existência de uma sólida estrutura de carregamento elétrico e a criação de um sistema de gerenciamento de tráfego aéreo.
“São grandes desafios, mas é preciso considerar que os pontos de partida e chegada e as rotas a serem percorridas poderão ser implementados em pequeno número e expandidos progressivamente”, opina Rade. “Isso tornaria viável a criação programada da infraestrutura e facilitaria a implementação do gerenciamento operacional.” Para o engenheiro do ITA, em uma cidade como São Paulo faz sentido imaginar que rotas iniciais poderão ser criadas ligando os aeroportos de Congonhas, no sul da capital, e de Guarulhos, no município vizinho.
Será preciso também demonstrar a confiabilidade das baterias elétricas de alta performance e dos sistemas autônomos de voo, além de garantir que os carros voadores operem com baixos níveis de ruído. “Se drones de pequeno porte geram todo o ruído que ouvimos, imagine veículos maiores, bem mais pesados”, alerta o engenheiro aeronáutico William Wolf, da Faculdade de Engenharia Mecânica da Universidade Estadual de Campinas (Unicamp).
“Esse é um ponto crítico, já que essas novas aeronaves farão trajetos em centros urbanos”, reitera Catalano, que liderou um projeto voltado a avaliar a emissão de ruídos pelos rotores do aparelho da Eve. “Realizamos ensaios acústicos dos rotores. Medimos o ruído emitido e avaliamos diferentes configurações de rotores, a dis -
tância entre eles, o ângulo de inclinação e outros parâmetros”, afirma. O túnel de vento da EESC foi adaptado para a realização dos ensaios aeroacústicos e um novo, maior, está sendo construído com recursos da fabricante brasileira de aviões. Os rotores dos eVTOL, de acordo com Catalano, são menos ruidosos do que as hélices dos helicópteros, mas não se sabe ainda os limites de ruído que os carros voadores terão que atender. “A regulamentação sobre emissão de ruído ainda está sendo desenvolvida”, informa.
MERCADO E CONCORRENTES
Em 2025, a Eve divulgou um relatório com projeções do mercado de eVTOL. A empresa estima que até 2045 estarão em atividade no mundo 30 mil carros voadores. Essa frota transportará no período mais de 3 bilhões de pessoas, gerando uma receita de US$ 280 bilhões (mais de R$ 1,5 trilhão) resultante da venda e operação das aeronaves. Especialistas projetam que o mercado global dessa aeronave será bastante competitivo. Hoje, entre os principais concorrentes da Eve figuram as norte-americanas Joby Aviation e Archer, a chinesa EHang e a europeia Volocopter. Nenhuma tem aparelhos voando comercialmente, mas algumas estão em um nível de desenvolvimento mais avançado do que a Eve. A Joby fez em agosto de 2025 o primeiro voo tripulado de seu eVTOL entre dois aeroportos da Califórnia. A viagem durou 12 minutos. A empresa planeja iniciar a operação de seu modelo como táxi aéreo em Dubai no fim deste ano.
A EHang está adiantada na comercialização e certificação de suas aeronaves, projetadas para voos autônomos (sem piloto). O aparelho chinês, que voou no Brasil em 2024 (ver Pesquisa FAPESP no 345), custará o equivalente a US$ 410 mil (R$ 2,2 milhões) no mercado internacional, segundo a empresa.
“Embora, aparentemente, o desenvolvimento do eVTOL da Eve esteja atrasado em relação ao de alguns concorrentes, não creio que a empresa esteja em desvantagem”, avalia Rade. “A fabricante brasileira parece adotar uma abordagem que privilegia um tempo de desenvolvimento e certificação mais longo, porém com maior probabilidade de sucesso”, diz ele, destacando que alguns concorrentes ficaram pelo caminho, como a empresa alemã Lilium, que declarou falência em 2025. Alves, da USP, tem opinião parecida. Para ele, sair na frente oferece vantagens como captura de mercado e atração de investimentos, mas priorizar segurança e homologação é crucial em um setor tão regulado. “A posição da Embraer, via Eve, é forte devido ao respaldo técnico da empresa-mãe e foco em um caminho seguro e estável para certificação”, declara. l

Startup e universidade paulista desenvolvem equipamento para automatizar a produção de insumos agrícolas à base de fungos
FRANCES JONES
Três pesquisadoras de São Carlos, no interior paulista, desenvolveram uma tecnologia que pode intensificar no país a produção de insumos de origem biológica a partir de resíduos agrícolas. Em parceria com a Universidade Federal de São Carlos (UFSCar), a startup Ikove Agro, fundada por uma delas, depositou o pedido de patente, em julho de 2025 no Instituto Nacional da Propriedade Industrial (INPI), de um biorreator que procura tornar mais eficiente e escalonável um tipo específico de fermentação, a técnica básica para a produção de bioinsumos. O equipamento automatiza o processo da chamada fermentação em estado sólido, que em geral é feita manual-
mente com o uso de pequenos sacos plásticos. A inovação surge em um momento de crescimento do mercado de bioinsumos agrícolas (ver Pesquisa FAPESP nº 358).
O interesse por produtos biológicos para emprego na agricultura, uma alternativa a agrotóxicos e fertilizantes químicos, tem aumentado em razão da demanda por alimentos com menos resíduos químicos e produzidos a partir de técnicas sustentáveis. Segundo artigo publicado no ano passado no periódico científico Journal of Agricultural Sciences Research, h avia 546 produtos de controle microbiológico registrados no Brasil em 2025, sendo 31% deles à base de bactérias do gênero Bacillus e 58% criados a partir de fungos.
Colher com amostra de arroz usado para produção do fungo Trichoderma asperellum
A produção industrial de biocompostos com bactérias já tem uma tecnologia automatizada que se baseia em um processo de fermentação líquida ou submersa. A fabricação de ativos fúngicos, por sua vez, precisa ocorrer em meio sólido, a fim de que o produto gerado seja eficiente, resistente e tenha maior durabilidade. Esse p rocesso ocorre de uma forma praticamente artesanal, com o uso de sacos plásticos ou vidrarias laboratoriais, mesmo quando produzido em grandes quantidades.
Instalado na incubadora ParqTec, em São Carlos, o protótipo do biorreator para fermentação em estado sólido (BioFES) produz um dos principais agentes de controle biológico usados no Brasil, o fungo Trichoderma asperellum, em grãos de arroz. “Criamos o biorreator depois de ouvir de empresas de bioinsumos as dificuldades do processo em sacos”, conta a engenheira biotecnológica Fabíola Ribeiro de Oliveira, pesquisadora da startup e uma das desenvolvedoras da tecnologia.
Um dos grandes desafios do processo é que, ao crescer, o fungo libera calor e dióxido de carbono, o que faz a temperatura aumentar tanto que acaba por prejudicar seu desenvolvimento. Esse efeito piora conforme o aumento do volume da biomassa, o que o impede de ampliar a escala nos sacos plásticos. O método tradicional mais comum utilizado ocorre em sacos pequenos, com no máximo 100 gramas de arroz, a fim de homogeneizar a temperatura.
“Quando você coloca uma quantidade reduzida de arroz, a condição térmica da superfície é muito próxima à da encontrada no meio da massa. Por
Vaso produtivo, feito de inox e dividido em módulos, é o núcleo do aparelho
1. Colocados nos módulos, arroz ou outro material, como farelo ou palha de cana ou soja, são o substrato para o crescimento dos microrganismos
2. Cada compartimento tem perfurações para controlar as trocas de gás e está conectado a um módulo de aeração. Um sistema de umidificação é acoplado ao aparelho
outro lado, se você põe um volume maior, isso não acontece e pode haver um ponto de aquecimento no meio da massa de arroz”, explica a engenheira de alimentos Fernanda Perpétua Casciatori, do Departamento de Engenharia Química da UFSCar e também desenvolvedora do BioFES. Ela explica que não é possível mexer no material durante o processo por risco de atrapalhar o crescimento do microrganismo.
Pelo método convencional, portanto, para processar 20 quilos (kg) do ativo são necessários 200 saquinhos plásticos, o que torna o processo trabalhoso. Para simplificar, o novo equipamento foi projetado com vários compartimentos e um sistema de aeração, umidificação, aquecimento e refrigeração para controle e monitoramento dos parâmetros.
Obiorreator é semelhante a um grande vaso de inox com subdivisões internas (ver infográfico abaixo). “Ele tem capacidade de produção de 20 kg por ciclo, mas estimamos que, com ajustes, poderá chegar a 100 kg de insumo ou até mais”, comenta a engenheira-agrônoma Clarissa Okino-Delgado, fundadora da startup e pesquisadora responsável por dois projetos do programa Pesquisa Inovativa em Pequenas Empresas (Pipe) da FAPESP, que financiaram o desenvolvimento. O ciclo produtivo dura entre quatro e sete dias, em geral.
Em um primeiro momento, a equipe quis demonstrar às fabricantes de bioinsumos que o rea-
3. Válvulas e sondas permitem o controle e o monitoramento de temperatura, umidade e passagem de gases, como oxigênio e gás carbônico (CO2)
Entrada de ar
4. A liberação de calor e de CO2 indica aumento do metabolismo do microrganismo
5. Torre de controle facilita a visualização das condições internas do vaso de inox. O ciclo produtivo leva em torno de quatro a sete dias
O processo no BioFES é escalonável e mais fácil de controlar
tor pode ser incorporado ao processo conhecido de produção industrial, que utiliza grãos de arroz como substrato. Mas já foram realizados testes com outros insumos para os cultivos microbianos, entre eles subprodutos de cana-de-açúcar, café, cerveja e grãos, como soja e trigo.
“Não pretendemos reinventar a roda. Olhamos para tudo o que era usado nos biorreatores de fermentação submersa, aproveitamos o que pudemos e fizemos as adequações para a fermentação sólida”, ressalta Okino-Delgado. A tecnologia, diz ela, poderá ser aproveitada em outros setores, como os de biocombustíveis e de cosméticos. Biorreatores são utilizados na indústria farmacêutica e de biotecnologia para produzir antibióticos, enzimas e bebidas fermentadas.
deverá reduzir a contaminação cruzada durante o processo, otimizará tempo e recursos e permitirá maior reprodutibilidade. De acordo com ela, existem sistemas de fermentação em estado sólido criados e utilizados em outros países, mas com outra tecnologia. Em geral, diz Fleuri, esses aparelhos não integram as etapas mais críticas do processo, apresentam capacidade reduzida de produção e têm estruturas frágeis.
“Esse desenvolvimento possibilitará a geração de outras inovações pelo aproveitamento de resíduos agroindustriais para a fabricação de diversos bioprodutos”, diz a pesquisadora. Orientadora de mestrado e doutorado de Okino-Delgado na Unesp, Fleuri não participou diretamente do projeto e da construção do novo biorreator.
Diferentes etapas produtivas (esterilização, inoculação e fermentação)
ocorrem em um mesmo aparelho
Menor risco e frequência de contaminação, pois reduz a necessidade de manipulação do material
Outra vantagem da inovação seria a possibilidade de executar diversas operações no mesmo equipamento. “O que temos hoje são biorreatores para fazer apenas o cultivo celular, a fermentação propriamente dita”, detalha Casciatori. “No novo equipamento, congregamos etapas anteriores à fermentação, como a esterilização do substrato e a inoculação do microrganismo, e posteriores a ela, a extração e a recuperação do bioproduto”, explica Casciatori. “Temos mais etapas acontecendo no vaso. Isso é importante para a viabilidade econômica do processo. Além de reduzir o trabalho manual e o risco de contaminação, ajuda na rotina industrial.”
Para a bióloga Luciana Fleuri, coordenadora do Laboratório de Bioprocessos do Instituto de Biociências da Universidade Estadual de São Paulo (Unesp), campus de Botucatu, o BioFES


Clarissa Okino-Delgado segura módulo onde é feito o crescimento de ativos fúngicos. Acima, saco plástico usado na produção convencional do bioinsumo
Abióloga afirma que o BioFES poderá beneficiar suas pesquisas na Unesp. “Meu grupo produz biomoléculas por fermentação em estado sólido em frascos e sacos de cultivo, p ara a aplicação como aditivo na alimentação animal. Isso requer um trabalho intenso, demorado e exaustivo. Com o novo biorreator, poderemos produzir mais em menor tempo, de forma controlada e reprodutível.” Fleuri também antecipa a possibilidade de parcerias entre a u niversidade e empresas.
A engenheira química Beatriz Vahan Kilikian, professora aposentada da Escola Politécnica da Universidade de São Paulo (Poli-USP), desenvolveu no início dos anos 2000, com apoio da FAPESP, outro tipo de biorreator a fim de estudar a possibilidade de ampliar a escala de processos de cultivos. Um protótipo do aparelho com capacidade para a produção de 10,5 kg chegou a ser montado, mas a tecnologia não foi licenciada. Segundo Kilikian, o apelo ambiental do aparelho da Ikove é “inegável”, seja pelo emprego de resíduos agrícolas, seja pela redução no uso de fertilizantes químicos. “Dispor de uma tecnologia nacional e acessível ajudará em muito no aumento da produtividade de bioinsumos. É preciso, contudo, que o aparelho seja de fácil uso e tenha preço compatível com o do biofertilizante.”
Desde o depósito da patente, a inovação de São Carlos já chamou a atenção de pelo menos 10 empresas. “Representantes de grandes fabricantes de produtos biológicos têm vindo aqui conhecer o equipamento”, conta Okino-Delgado. Pelo menos três deles manifestaram interesse em estruturar testes no novo reator, conforme as pesquisadoras. l
Os projetos e os artigos científicos consultados para esta reportagem estão listados na versão on-line.
Células de óxido sólido criadas no Ipen para converter metano em etileno

Nova rota pode transformar importante gás gerador do efeito estufa em insumo para a fabricação de plásticos e combustíveis sintéticos
DOMINGOS ZAPAROLLI
Uma equipe do Instituto de Pesquisas Energéticas e Nucleares (Ipen), de São Paulo, desenvolveu uma rota eletroquímica para converter gás metano (CH₄) em etileno (C₂H₄) e gás de síntese . O primeiro é um insumo básico da indústria de plásticos e solventes químicos; o segundo é uma mistura de hidrogênio (H₂) e monóxido de carbono (CO) e é utilizado na produção de fertilizantes e de combustíveis sintéticos, como metanol e combustível sustentável de aviação (SAF). O método proposto pode abrir caminho para a produção mais econômica e com menor impacto ambiental de etileno e gás de síntese
Derivado do petróleo, o etileno é uma das moléculas mais usadas do mundo. Em 2024 foram produzidas mais de 170 milhões de toneladas e a consultoria norte-americana Market Research Future (MRFR) estima uma expansão de 5,3% ao ano até 2035.
O método predominante para a fabricação de etileno recorre ao craqueamento térmico a vapor em refinarias petroquímicas. Durante esse processo,
as grandes moléculas de petróleo são quebradas com o uso contínuo de alta temperatura, entre 400 graus Celsius (°C) e 800 °C. O craqueamento térmico do petróleo, que dá origem ao insumo, é uma das principais fontes de emissão de gases do efeito estufa (GEE) na atmosfera.
“A busca por rotas alternativas com menor impacto ambiental para a obtenção de etileno e outros hidrocarbonetos é uma preocupação global. Muitos núcleos de pesquisa estão direcionando seus esforços para obter métodos mais amigáveis ao ambiente”, diz o físico Fabio Coral Fonseca, gerente do Centro de Células a Combustível e Hidrogênio do Ipen e coordenador da pesquisa, que teve parceria da Universidade Federal do ABC (UFABC).
A principal rota estudada em centros ao redor do mundo para a conversão direta do metano em etileno é a catalítica. Nela, o metano reage com o oxigênio na presença de catalisadores óxidos metálicos sob alta temperatura, em torno de 800 °C. Catalisadores são substâncias que promovem a reação entre reagentes químicos, sem serem consumidos no processo.
Diferentes combinações de catalisadores já foram testadas em laboratório, mas nenhuma se mostrou adequada. Segundo Fonseca, os resultados de vários estudos realizados obtiveram a conversão do metano em etileno, mas com baixo desempenho. “O resultado típico dos testes é uma grande queima de metano e baixa obtenção de etileno. Não é um processo maduro, viável industrialmente”, afirma.
A rota do Ipen também é um processo catalítico, mas recorre a reatores de célula de óxido sólido (SOC) para realizar a conversão do metano. As
1. O processo começa com a introdução de ar, uma mistura de nitrogênio (N2) e oxigênio (O2), no polo positivo da célula de óxido sólido (SOC)
2. A SOC retira o N2 da reação e dosa o O2 na forma de íons (O2–), que são transportados para o ânodo
Abundante no planeta, o gás metano responde por cerca
5. A energia gerada no processo pode ser aproveitada na própria reação
FONTE FÁBIO CORAL FONSECA (IPEN)
SOC são dispositivos eletroquímicos cerâmicos que operam em altas temperaturas, também por volta de 800 °C. Ela é composta por um cátodo, um ânodo e um eletrólito cerâmico. Como explica Fonseca, o primeiro passo é introduzir ar – uma composição de nitrogênio (N₂) e oxigênio (O₂) –no cátodo. Na sequência, a SOC retira o nitrogênio do processo e dosa o oxigênio na forma de íons. Esses íons reagem com o gás metano introduzido no ânodo, onde se encontra o catalisador –uma mistura dos óxidos de cério e lantânio, dois elementos de terras-raras abundantes e acessíveis. A reação do metano na presença do catalisador gera etileno e gás de síntese, misturados, ao final do processo (ver infográfico abaixo).
A reação química é capaz de manter as placas SOC aquecidas em 800 °C, sendo necessário apenas o impulso inicial para atingir a tempera-
3. O metano (CH4) é inserido na camada catalítica e reage com a água (H20) na presença do catalisador (óxido de cério com óxido de lantânio), sendo transformado em etileno e gás de síntese
Etileno
Gás de síntese
4. O ânodo recebe uma fração de hidrogênio (H2), oriunda da reação do metano na camada catalítica. O H2 reage com os íons de oxigênio gerando água e elétrons (e–)

Refinaria de Cabiúnas, em Macaé (RJ), o maior polo de processamento de gás natural do país
tura adequada. Além de apresentar um consumo baixo, o processo tem como resíduo a geração de uma pequena quantidade de energia elétrica, que pode ser aproveitada para melhorar a eficiência energética do próprio sistema.
As placas SOC utilizadas nos experimentos em laboratório têm 5 centímetros (cm) de diâmetro. A avaliação de Fonseca é que serão necessárias placas maiores, de até 20 cm de diâmetro, para a conversão do metano em escala industrial. Como a tecnologia é modular, a ideia é empilhar centenas de placas SOC para realizar a conversão do metano de acordo com a quantidade de etileno ou gás de síntese que se queira produzir. “É um processo direto, que pode ser mais econômico e não demanda energia intensiva e grande infraestrutura industrial, como ocorre nas refinarias”, diz o físico.
O trabalho gerou um artigo publicado em novembro de 2025 no periódico científico Journal of Power Sources. Nele, os pesquisadores demonstram que as SOC funcionaram nos testes de forma estável e o processo conseguiu transformar metano em produtos de alto valor agregado e energia elétrica. O método de conversão é foco de um pedido de patente submetido ao Instituto Nacional da Propriedade Industrial (INPI). Mas, como reconhece Fonseca, a rota de conversão ainda precisa ser aperfeiçoada antes de ser apresentada como uma alternativa em escala industrial.
O que a equipe do Ipen busca agora é a melhoria da seletividade do processo, ou seja, a capacidade de gerar separadamente etileno e gás de síntese. O objetivo dos pesquisadores é aperfeiçoar o reator (as SOC e o sistema catalisador) para obter dois processos específicos para a produção de etileno ou gás de síntese.
A pesquisa teve origem no programa Metano a Produtos ( M2P), do Centro de Inovação em Novas Energias (Cine), financiado pela FAPESP
e pela companhia de petróleo anglo-holandesa Shell, concluído em 2023. A continuidade dos trabalhos teve apoio da Fundação por meio de projetos de pesquisa. O Ipen mantém duas parcerias internacionais para desenvolver a tecnologia, uma com a Universidade de Grenoble-Alpes, na França, e outra com a Universidade Estadual do Novo México, nos Estados Unidos.
Segundo o químico Tulio Matencio, do Departamento de Química da Universidade Federal de Minas Gerais (UFMG), a tecnologia SOC é madura e comprovadamente eficiente. Além disso, tem a vantagem de demandar catalisadores com materiais menos nobres, portanto mais econômicos. “A proposta de usar essa tecnologia para a conversão do metano é bem fundamentada”, diz o pesquisador. A experiência do Ipen com a tecnologia SOC é a ntiga. Em 2019, o instituto estabeleceu uma parceria com a montadora japonesa Nissan com o objetivo de desenvolver células a combustível de óxido sólido (SOFC), uma versão de SOC capaz de converter etanol em eletricidade para impulsionar automóveis (ve r Pesquisa FAPESP nº 308).
Em volume, o metano é o segundo maior contribuinte para o efeito estufa, atrás apenas do dióxido de carbono (CO₂). É um gás abundante no planeta, respondendo por cerca de 90% da composição do gás natural e por algo entre 50% e 80% do biogás, resultante da decomposição de matérias orgânicas, como resíduos agropecuários, esgoto e material de lixões e aterros sanitários. Os usos econômicos mais comuns do metano são a geração de energia elétrica, de calor e de combustíveis. Boa parte do gás, contudo, é desperdiçada. “O metano é queimado e resulta na chama que vemos sobre as chaminés em aterros, em refinarias e em campos de petróleo”, diz o engenheiro de materiais Cauê Ribeiro, pesquisador da Empresa Brasileira de Pesquisa Agropecuária (Embrapa) Instrumentação e orientador dos programas de Pós-graduação em Química das universidades Federal de São Carlos (UFSCar) e de São Paulo (USP), campus de São Carlos.
A queima é feita para transformar metano em CO₂ antes da dispersão na atmosfera. “O metano tem impacto 30 vezes maior no aquecimento global do que o dióxido de carbono”, compara o engenheiro. “Transformar o metano, que temos em excedente no Brasil e no mundo, em produtos de valor agregado como etileno e gás de síntese é uma iniciativa importante, tanto do ponto de vista econômico como ambiental”, destaca Ribeiro. l
Os projetos e o artigo científico consultados para esta reportagem estão listados na versão on-line.

No marco do seu centenário, o geógrafo Milton Santos é lembrado pelos conceitos que ajudaram a pensar o espaço e a realidade dos países pobres
ANA PAULA ORLANDI
Considerado um dos maiores geógrafos brasileiros, M ilton Santos completaria 100 anos em maio. “Com suas análises sobre as desigualdades sociais e territoriais, ele foi decisivo no mo vimento de renovação do pensamento geográfico nos anos 1970 no Brasil”, afirma a geógrafa Maria Adélia de Souza, professora aposentada da Faculdade de Filosofia, Letras e Ciências Humanas da Universidade de São Paulo (FFLCH-USP) e parceira intelectual do pesquisador baiano.
“Uma de suas principais contribuições foi definir o espaço geográfico como instância da sociedade.”
O conceito está no livro Por uma geografia nova ( Hucitec/Edusp, 1978), no qual defende a necessidade de estabelecer um objeto para a disciplina (no caso, o espaço geográfico) e que ele fosse t ão importante quanto a economia e a cultura. “Ele foi aprimorando essa ideia ao longo de sua trajetória até chegar ao ápice com o livro A natureza do espaço [Edusp, 1996], onde define o espaço pela indissociabilidade dos sistemas de objetos e de ações”, diz Bernardo Mançano
Fernandes, geógrafo da Universidade Estadual Paulista (Unesp), campus de Presidente Prudente. “Ou seja, as pessoas, as técnicas e as coisas produzem o espaço e são produzidas pelo espaço. Isso supera a definição clássica de espaço como sendo apenas área e superfície.”
Para a geógrafa Mónica Arroyo, da USP, Santos foi um intelectual comprometido com a sua época. “Ele buscou entender o mundo a partir de um campo do saber e de forma crítica. Isso demandou um grande esforço teórico em diálogo com outras disciplinas, como economia, sociologia, urbanismo e filosofia”, diz a pesquisadora, uma das organizadoras do seminário previsto para maio, na USP, em homenagem a Santos.
O evento será promovido pelo Departamento de Geografia em parceria com o Instituto de Estudos Brasileiros (IEB) da mesma universidade, que abriga o acervo do pesquisador com cerca de 60 mil itens. “O Fundo Milton Santos é formado por biblioteca e arquivo de documentos de diferentes momentos da trajetória do geógrafo baiano, que refletem sua atuação como professor e pesquisador em diversos países”, informa a geógrafa Flavia Grimm, que organizou o material doado em 2009 pela família de Santos e refletiu a respeito no estágio de pós-doutorado realizado na USP entre 2013 e 2016, com apoio da FAPESP.
Arroyo e Grimm são organizadoras de um livro ainda sem título definido, que deve ser lançado neste ano pela Edusp. A compilação reúne artigos escritos pelo intelectual no início da carreira, nos anos 1950. Santos não era geógrafo de formação: em 1948, graduou-se em direito na Universidade da Bahia, atual Universidade Federal da Bahia (UFBA). “Ele fez parte de uma classe média negra que vinha se formando no estado desde o final do século XIX”, diz o historiador Bruno de Oliveira Moreira, autor da tese de doutorado “Milton Santos e a ditadura civil-militar: Prisão, exílio e memória”, defendida em 2025, na UFBA. “Mesmo antes da Abolição, a Bahia já tinha uma comunidade de trabalhadores livres que se dedicavam a serviços u rbanos e, posteriormente, também ao magistério.”
Esse era o caso de seus pais, Francisco e Adalgisa, que trabalhavam como professores primários (hoje ensino fun-
damental I) e educaram o primogênito e m casa. Nascido na cidade de Brotas de Macaúbas, Santos cresceu em Itapira (hoje Ubaitaba) e Alcobaça, todas na B ahia. Aos 10 anos, foi estudar como interno no Instituto Bahiano de Ensino, em Salvador, onde começou a se interessar pela geografia. Mais tarde, em 1949, logo após se formar em direito, passou a lecionar a disciplina no Colégio Municipal de Ilhéus, no interior do estado.
Naquela cidade, onde permaneceu até 1953, era colaborador do jornal A Tarde, de Salvador. Ao retornar à capital baiana, tornou-se um dos redatores do diário. Na mesma ocasião, começou a lecionar geografia na Faculdade Católica de Filosofia de Salvador e se inscreveu para concorrer à vaga de docente de Geografia Humana na Universidade da Bahia, no concurso aberto em 1953.
Entretanto, sua inscrição foi indeferida e ele só conseguiu prestar o concurso sete anos depois, em 1960. O imbróglio começou após a instituição alegar que o candidato não tinha formação específica na área. “Ele entrou com recurso e depois judicializou o caso, inclusive porque vários professores da então Faculdade de Filosofia não eram diplomados nas áreas específicas que lecionavam”, prossegue Moreira, docente no Instituto Federal da Bahia, em Santo Amaro.
Com o caso em aberto, Santos partiu em 1957 para Estrasburgo, na França, a fim de realizar seu doutorado. O convite veio do geógrafo francês Jean Tricart (1920 -2003), que assistiu à apresentação de Santos no XVIII Congresso Internacional de Geografia, realizado em 1956, no Rio de Janeiro. Sob orientação de Tricart, a tese “O centro da cidade de Salvador. Estudo da geografia urbana” foi defendida em 1958.
Segundo Grimm, a produção do geógrafo na década de 1950 e na primeira metade dos anos 1960 é marcada pela análise da realidade baiana. Dessa fase fazem parte títulos como seu primeiro livro, O povoamento da Bahia (Imprensa Oficial, 1948). Trata-se da publicação do trabalho apresentado no concurso para professor em Ilhéus, em que discorre sobre atividades econômicas do estado. “Nesse momento, ele dialogava com a geografia regional francesa, com conceitos como ‘gênero de vida’ e ‘hábitat’, sobretudo em seus estudos sobre a zona cacaueira baiana”, observa Grimm, autora de tese de doutorado sobre a trajetória epistemológica de Santos, defendida em 2012, na USP, com apoio da FAPESP.
No início da carreira, o pesquisador (em registro sem data) foi influenciado pela geografia francesa 2

Na volta ao Brasil, Santos criou em 1959 o Laboratório de Geomorfologia e Estudos Regionais, na Universidade da Bahia. “Isso aconteceu a convite do então reitor, pouco antes de ele ser efetivado como professor da instituição”, relata Moreira. No ano seguinte, como representante de A Tarde, integrou a comitiva do então candidato à Presidência da República, Jânio Quadros (1917-1992), em visita a Cuba.
A aproximação com o político, eleito em 1960, rendeu-lhe um convite para o cargo de subchefe do Gabinete Civil da Presidência da República na Bahia, em 1961. Com a renúncia de Quadros, menos de sete meses após a posse, Santos assumiu, em 1963, o comando da Comissão de Planejamento Econômico (CPE) do governo baiano.
Quando veio o golpe militar de 1964, o pesquisador ficou detido entre abril e junho em um quartel do Exército em Salvador. “Ele foi acusado pelo regime de subversão por manter militantes de esquerda na equipe técnica do C PE”, diz Moreira. “Também levantaram suspeitas de corrupção em contratos e de descontrole nos gastos do órgão, mas nada foi provado nesse sentido, e o processo acabou sendo arquivado em 1969, quando foi para a Justiça civil.”
O geógrafo deixou o Brasil em dezembro de 1964. “É provável que um acordo entre autoridades baianas e os militares tenha possibilitado a viagem”, prossegue o historiador. “Ele não foi expulso formalmente do país, mas ainda assim







perdeu os empregos na Bahia e precisou sobreviver com contratos temporários com as universidades estrangeiras enquanto esteve fora do Brasil.”
Santos ficou 13 anos no exterior. Sua primeira parada foi na França, como professor associado nas universidades de Toulouse (1964-1967), Bordeaux (1967-1968) e Paris (1969-1971). Nesse período, dedicou-se sobretudo ao processo d e urbanização nos países em desenvolvimento e produziu livros como O p apel do geógrafo no Terceiro Mundo. A obra saiu primeiro na França, em 1971, e depois no Brasil, em 1978.
“Ele percebeu de forma mais evidente que as teorias elaboradas pelos geógrafos franceses não davam conta de explicar a realidade dos países subdesenvolvidos e começou a romper com a geografia fran-

2 Alguns dos livros do geógrafo, cuja obra circulou em português, francês, inglês e espanhol
cesa, que era a base de sua formação”, comenta a geógrafa Adriana Bernardes, da Universidade Estadual de Campinas (Unicamp). “Esse movimento de ruptura se intensificou ao longo da década de 1970, quando passou a construir sua própria teoria interpretativa”, acrescenta Fernandes, da Unesp.
Ao longo de 1971, Santos atuou como pesquisador no Instituto de Tecnologia de Massachusetts (MIT), nos Estados Unidos. Na ocasião, um de seus projetos em andamento era a formulação da teoria sobre os dois circuitos da economia u rbana, que seria concluída no Canadá, onde morou entre 1972 e 1973. A ideia foi apresentada em livro publicado originalmente em francês, em 1975, que no Brasil ganhou o título O espaço dividido (Francisco Alves Editora, 1979).
Na Venezuela, em 1969, durante o período em que esteve fora do Brasil por causa da ditadura militar
Segundo essa teoria, as cidades dos países em desenvolvimento abrigam dois sistemas econômicos originários do processo de modernização, sendo interdependentes e complementares. “Um deles é o circuito superior, representado por grandes empresas e caracterizado pelo acúmulo de capital e tecnologia, ao lado da baixa oferta de trabalho”, explica a geógrafa Livia Cangiano Antipon, atualmente em estágio de pós-doutorado na USP sobre o tema, com apoio da FAPESP. “Há também o circuito inferior, organizado pelas classes empobrecidas e marcado pela profusão de trabalhadores em pequenos negócios, como oficinas e salões de beleza.”

A pesquisadora aplicou essa teoria na tese de doutorado sobre o comércio de alimentação em São Luís (MA), q ue defendeu em 2024, na Unicamp, também com bolsa FAPESP. “Muitos teóricos europeus nas décadas de 1950 e 1960 separavam ‘riqueza’ e ‘pobreza’ em suas análises, como se elas não fossem interdependentes”, conta Antipon. “ Na contramão disso, Milton Santos chamou a atenção para a economia dos pobres urbanos e para as realidades periféricas.”
Para o pesquisador baiano, a modernização nem sempre era sinônimo de progresso. “Milton dizia que as condições do processo de modernização em nosso país, caracterizado pela chegada de empresas internacionais, geraram mais pobreza e reforçaram desigualdades”, comenta a geógrafa Amelia Damiani, da USP. “Ele tratava da relação entre modernidade e atraso por meio de conceitos como ‘involução metropolitana’, que desenvolveu na década de 1980.”
Enquanto esteve fora do Brasil durante a ditadura militar, Santos passou p or outros países, como Venezuela e Peru. Entre 1974 e 1976, ajudou a implementar um programa de pós-graduação em geografia na Universidade de Dar es Salaam, na Tanzânia, África. Por fim, atuou como professor na Universidade Columbia, em Nova York, em 1977.
Naquele ano, decidiu retornar em definitivo ao Brasil, ao lado da segunda mulher, a geógrafa francesa Marie-Hélè-
ne Tiercelin, grávida de Rafael, segundo filho do geógrafo. Seu primogênito foi o economista Milton Almeida dos Santos Filho (1955-1996), do primeiro casamento com a comerciante Jandira Rocha. Ele h avia visitado o país pouco antes: em 1975 para um evento na Unicamp e no ano seguinte para o encontro anual da Sociedade Brasileira para o Progresso da Ciência (SBPC), em Brasília. “Apesar de não ter sido admoestado pelo regime, foi vigiado nessas duas oportunidades”, diz Moreira.
Nos Estados Unidos, Santos participou das discussões da chamada geografia r adical, influenciada pelo marxismo, que tinha entre seus partidários o geógrafo inglês David Harvey. “A partir da década de 1970, o conceito de espaço geográfico seria revisto em diferentes países”, conta Grimm. “No Brasil, isso aconteceu por meio de autores como Milton Santos que procuravam alcançar uma teoria social crítica a partir da geografia.”
Na volta ao país, enquanto buscava retomar o cargo de docente na UFBA, trabalhou como professor convidado na Faculdade de Arquitetura e Urbanismo e de Design (FAU) da USP, entre 1978 e 1982, e na Universidade Federal do Rio de Janeiro (1979-1982). Em 1983 se tornou professor titular do Departamento de Geografia da USP, onde ficou até
2001, quando faleceu em consequência de câncer.
Com Maria Adélia de Souza, o pesquisador liderou nos anos 1980 a criação na USP do Laboratório de Geografia Política e Planejamento Territorial e Ambiental (Laboplan). Mais tarde, em 1994, recebeu o Prêmio Internacional de Geografia Vautrin Lud, considerado pelos geógrafos como equivalente ao Nobel. Apenas naquele ano conseguiu ser reintegrado como professor da UFBA.
“Na década de 1990, ele foi um dos primeiros intelectuais a criticar o processo de globalização na América Latina”, afirma a geógrafa Catia Antonia da Silva, da Universidade do Estado do Rio de Janeiro (Uerj). Outro ponto destacado pela pesquisadora são os estudos sobre a informação. “Com o que chamava de ‘meio técnico-científico e informacional’, ele buscava entender como se dava a disseminação da informação pelo espaço geográfico e seus impactos.”
A natureza do espaço, um de seus livros mais importantes, foi escrito naquela década. “Além de tratar da ordem global e da informação, nessa obra ele reforça a força política e cultural das periferias nas grandes cidades do mundo”, diz Bernardes, da Unicamp. “Milton nunca abriu mão do olhar crítico, mas sempre foi um otimista. Em sua opinião, a mudança na sociedade começaria nesses espaços.” l
Os projetos e os artigos científicos consultados para esta reportagem estão listados na versão on-line.

Letristas populares inserem sotaque próprio no espaço público
ANA BEATRIZ RANGEL
Em 2007, durante um período como professora convidada da Universidade de Buenos Aires, a designer paulistana Priscila Farias se encantou pelo filete portenho, estilo ornamental típico da capital argentina. “Além da moldura e do fundo colorido, as placas que seguem essa tradição têm letras ornamentadas que remetem a um tempo a ntigo”, conta a pesquisadora, que é docente da Faculdade de Arquitetura e Urbanismo e de Design da Universidade de São Paulo (USP) e estudiosa da forma das letras no espaço público. Em geral, filetar quer dizer pintar com um pincel fino, como explica a designer. “No Brasil, os pintores também designam como ‘filete’ os ornamentos que fazem nas carrocerias de madeira dos caminhões”, diz. No caso argentino, a t radição que data da virada do século XIX para o XX veio com os imigrantes italianos. “Eles decoravam carroças e, posteriormente, veículos motorizados como caminhões e ônibus”, prosse-

A partir da esquerda, chiva, híbrido de ônibus e caminhão da Colômbia; e o filete portenho em uma banca de Buenos Aires
gue a pesquisadora. “Na década de 1970, devido a mudanças na legislação argentina, esse tipo de pintura desapareceu dos veículos comerciais e de transporte público, que foram padronizados. Mas o estilo permaneceu, por exemplo, em letreiros e fachadas de lojas.”
O fi lete portenho é um dos exemplos analisados por Farias no capítulo “Latin American vernacular lettering” (ou Letra vernacular latino-americana), que integra o livro The bloomsbury handbook of global typography. Com lançamento previsto para meados de fevereiro pela editora britânica Bloomsbury, a obra é organizada por pesquisadores da Universidade de Reading e da British Academy, no Reino Unido, e da Universidade St. John’s, nos Estados Unidos.
A lém da Argentina, Farias se debruça sobre a tradição das letras populares em outros países como México e Colômbia. A respeito desse ú ltimo, discorre sobre a chiva, híbrido de ônibus e caminhão que costuma servir de meio de t ransporte público para populações rurais em direção aos grandes centros. “É um serviço informal, realizado por motoristas particulares, que capricham na decoração multicolorida e nas letras tridimensionais para chamar a atenção dos clientes”, observa Farias. “Nos casos analisados, muitas vezes a letra é uma forma de diferenciação que ajuda a identificar lugares ou meios de transporte mais pelas cores e formas do que pelo que realmente está escrito ali.”
O design popular de letras passou a despertar a curiosidade de pesquisadores no Brasil a partir da década de 1990. “Incluir a produção dos letristas populares na memória gráfica brasileira é uma forma de abrir nosso olhar para o que está acontecendo nas ruas”, defende a designer Fátima Finizola, da Universidade Federal de Pernambuco (UFPE), que desde 2007 desenvolve o projeto “Abridores de letras de Pernambuco”.

Em algumas partes do país, o termo “abrir letras” define a prática dos letristas que utilizam o pincel para traçar letras e executar de forma artesanal as encomendas dos clientes.
Ainiciativa rendeu um livro homônimo, lançado pela Editora Blucher, em 2013, organizado por Finizola em parceria com a designer Solange Coutinho, também docente na UFPE, e o fotógrafo Damião Santana. A lém disso, foram realizadas exposições , a exemplo da mostra com mesmo título que esteve em cartaz no Sesc Campo Limpo, na capital paulista, em 2016. Uma pequena parcela do acervo fotográfico , que contém ao todo cerca de mil imagens registradas nas cidades de Gravatá, Caruaru, Recife, Arcoverde, Salgueiro e Petrolina, está reunida no site do projeto.
Finizola começou a investigar o tema, com foco na capital pernambucana, no mestrado em design concluído em 2010 na UFPE. No doutorado, defendido em 2015, na mesma instituição, e xpandiu o escopo e englobou localidades do interior do estado. Além dos aspectos formais da linguagem visual dos letristas e do processo de produção dos letreiros, a pesquisadora analisou o perfil dos profissionais. Segundo ela, o o fício em Pernambuco é exercido sobretudo por homens de 30 a 70 anos, que aprenderam a atividade de forma autodidata ou por meio da relação mestre-aprendiz. “Mas essa realidade não é exclusiva do nosso estado e pode ser observada em outras partes do Brasil e da América Latina”, comenta.
Esse é o caso dos abridores de letras na região amazônica, como relata a designer paulista Fernanda Martins. Formada em artes visuais pela USP e especializada em tipografia, ela se mudou



para Belém em 2004. Ao visitar uma comunidade ribeirinha na região do município de Boa Vista do Acará (PA), ficou fascinada pelas letras que decoravam os barcos atracados no local. Na sequência, resolveu investigar o que chama de letra decorativa amazônica para o trabalho final da especialização em semiótica e cultura visual, que concluiu em 2008 na Universidade Federal do Pará (UFPA). O encanto pela temática se desdobrou também no projeto “Letras que flutuam”, criado em 2 006, em parceria com a designer Sâmia Batista, para valorizar o ofício desses artistas populares. Isso inclui, por exemplo, zelar para que o t rabalho dos pintores não seja apropriado para fins comerciais sem o devido reconhecimento de seus autores. A iniciativa, que levou à criação
do instituto com o mesmo nome do projeto, em 2024, vem mapeando há 13 anos os profissionais em Belém e em outras localidades do estado, como a Ilha de Marajó. “Até agora levantamos 140 nomes”, diz Martins.
Segundo a designer, esse tipo de letreiramento amazônico é caracterizado pelas letras maiúsculas, coloridas, decoradas e com sombra. “Como é d ividida em duas partes, cada uma leva uma cor diferente. O efeito de sombra ou de volume é resultado de uma pintura dégradé, denominada ‘matizado’. Ao final da pintura, os profissionais ainda decoram a letra: é o ‘caqueado’”, escreve a designer no livro Letras que flutuam (Secult/PA, 2021).
As letras são encontradas em embarcações de madeira, tanto nas particulares como naquelas que fazem serviço de transporte de carga ou de passageiros, mas elas extrapolam os rios e estão também em murais e letreiros de estabelecimentos comerciais. É difícil definir sua o rigem. De acordo com Martins, uma das hipóteses está em um decreto federal de 1925, que obrigou os barcos do país a serem registrados e identificados por um nome em seu casco. “A comunidade ribeirinha passou então a nomear os barcos a princípio com letras simples, que ao longo do tempo ganharam decoração e diversidade de cores”, conta.
A pesquisadora identifica nas letras presentes nos barcos amazônicos traços da tipografia decorativa do século XIX. “As letras daquele período são sempre maiúsculas, grossas, com fios de contorno, o que permite a inserção de enfeites. Uma das técnicas mais populares na ocasião era a simulação da tridimensionalidade por meio de sombras”, enumera. Segundo Martins, os letreiros dos barcos amazônicos apresentam essas mesmas características, que são reinterpretadas com tempero local e acrescidas do uso de um código cromático específico. “Muitos dos nossos entrevistados contam que aprenderam a pintar entre os anos 1940 e 1970 e alguns deles citam terem feito cursos por correspondência, em que recebiam catálogos de tipografia clássica. Talvez possa haver uma conexão aí”, considera. Ao mesmo tempo, ela lembra que esse imaginário visual, das letras decorativas, circulava h á muito tempo no Pará. “Com a liberação da navegação na região amazônica, em 1867, e a expansão econômica do ciclo da borracha, entre 1879 e 1912, uma grande variedade de material impresso da Europa e dos Estados Unidos aportou na região, gerando a chamada belle époque belenense. Logo, essa estética passou a influenciar as letras em placas e anúncios publicitários”,

Catálogo com tipografia decorativa comum no século XIX, em registro do Instituto Letras que Flutuam
relata Martins, autora da tese “Impresso no Pará, 1820-1910: Memória gráfica como espírito de época”, defendida em 2017 na Escola Superior de Desenho Industrial da Universidade do Estado do Rio de Janeiro (Uerj).
O fluxo de barcos ao longo da região amazônica, em especial nas bacias dos rios Amazonas e Tocantins, fomenta, muitas vezes, uma “competição informal” pela letra mais bonita. “Os barcos levam as letras de um lugar a outro. Esse é um saber transmitido pelo fluxo do rio”, constata Martins. Segundo ela, o ofício de abrir letras na Amazônia sofre o risco de desaparecer. “Na Ilha de Marajó, por exemplo, se percebe o crescimento da pintura com pistola, conhecido na região como grafite”, comenta. “Esse tipo de pintura vem ganhando espaço entre os jovens porque agiliza a entrega do trabalho. O desafio é encontrar formas de como essas linguagens, as tradicionais e as inovadoras, poderão coexistir de maneira construtiva.”
Na avaliação de Farias, da USP, a sobrevivência dessas tradições está ligada à sua valorização. Na Argentina, por exemplo, os filetes portenhos foram reconhecidos como patrimônio cultural de Buenos Aires em 2006, e, mais tarde, como

Patrimônio Cultural Imaterial da Humanidade pela Organização das Nações Unidas para a E ducação, a Ciência e a Cultura (Unesco), em 2015. “É fundamental que os letristas valorizem o próprio ofício. Isso ajuda na transmissão da atividade e atrai o interesse dos jovens”, defende. Finizola concorda. “O interesse dos pesquisadores sobre o tema pode ajudar nesse sentido. Percebo que ao longo desses 18 anos de pesquisa, muitos abridores de letra passaram a olhar para a atividade com outros olhos, estimulados pela curiosidade da academia sobre aquela produção”, conta. “Em geral, esses profissionais não têm uma percepção clara de sua relevância para a cultura visual e a memória gráfica brasileira.” Para o designer Vinicius Guimarães, a pesquisa sobre a memória gráfica brasileira é fundamental para superar a ideia de que a atividade do design gráfico no país teria começado a partir da segunda metade do século XX, com a institucionalização da profissão no Brasil. “O uso de ferramentas quase exclusivamente digitais pode contribuir com a falsa impressão de que fazemos algo novo, por isso é importante ter contato com o que foi produzido em uma história muito mais longeva”, observa o pesquisador.
Na tese “Lettreiros e taboleta: Letreiramento público no Rio de Janeiro em fotografias e periódicos de 1860 a 1910”, defendida em 2021, na Uerj, Guimarães utilizou como fontes de pesquisa as i magens dos letreiros comerciais e os anúncios dos serviços dos letristas nos periódicos cariocas da época. Por meio das peças publicitárias, ele conseguiu mapear o perfil dos profissionais na cidade: no grupo, predominavam os imigrantes europeus que vinham para o Brasil já formados nos seus respectivos ofícios, cujo conhecimento era transmitido aos aprendizes nas oficinas.
De acordo com Guimarães, cerca de 60% dos letreiros feitos artesanalmente eram compostos por modelos de letras semelhantes aos encontrados em manuais de pintura de letras publicados nos Estados Unidos. No entanto, os profissionais que atuavam no Rio de Janeiro na época também modificavam os modelos dos manuais, indicando a existência de um estilo local. Um exemplo é a letra “E” com a barra horizontal central mais curta, e o “G” com a barra horizontal posicionada abaixo do centro da letra. “É o que podemos chamar de um sotaque tipográfico carioca”, conclui o pesquisador. l
Os artigos científicos e os livros consultados para esta reportagem estão listados na versão on-line.

Sobrecarga, baixos salários e múltiplos vínculos trabalhistas marcam a realidade desses profissionais no Brasil
GISELLE SOARES ilustrações ANA MATSUSAKI
Mulheres na faixa etária entre 30 e 39 anos e residentes na região Sudeste compõem a maior parte da força de trabalho da enfermagem com formação superior no Brasil. Além da intensificação das jornadas e do avanço de vínculos trabalhistas mais instáveis, como contratos temporários e terceirizações, há estagnação ou queda da remuneração média dos profissionais do setor, sobretudo entre auxiliares e técnicos. Outro problema é a diminuição de vínculos estatutários (relação jurídica do servidor público com o Estado, que garante, por exemplo, estabilidade no emprego) e a predominância de formas de contratação menos vantajosas, do ponto de vista salarial e de benefícios.
Essas e outras informações constam do relatório “Demografia e mercado de trabalho em enfermagem no Brasil”, divulgado pelo Ministério da Saúde no fim do ano passado, que avaliou dados do setor de 2017 a 2022. O levantamento foi coordenado por pesquisadores da Faculdade de Enfermagem e do Instituto de Medicina Social, ambos da Universidade do Estado do Rio de Janeiro (Uerj), e da Escola de Enfermagem da Universidade Federal de Minas Gerais (UFMG).

No Brasil, a enfermagem é composta por trabalhadores com diferentes níveis de formação: enfermeiros (ensino superior), técnicos de enfermagem (nível médio técnico) e auxiliares de enfermagem (curso profissionalizante). As mulheres representam cerca de 85% desses profissionais e o setor público concentra 61,9% dos vínculos de trabalho. Dados do Conselho Federal de Enfermagem (Cofen) indicam que, em dezembro de 2022, o Brasil contava com 634.058 enfermeiros, 1.403.475 técnicos de enfermagem e 242.711 auxiliares de enfermagem. Entre 2017 e 2022, período que inclui a pandemia de Covid-19, o número de postos de trabalho nos três níveis de cuidado cresceu quase 44%, passando de cerca de 1 milhão de vínculos para aproximadamente 1,5 milhão. Esse total, contudo, não corresponde ao número de profissionais, já que um mesmo trabalhador pode ocupar mais de uma vaga. A expansão foi observada em todas as regiões do país, com variações que vão de 34,9% no Sudeste a 57,3% no Centro-Oeste. Enquanto isso, Nordeste, Norte e Sul registraram crescimento de 46,3%, 43,8% e 44,6%, respectivamente. A distribuição desses profissionais é desigual: em 2022, S ão Paulo reunia o maior contingente (517.130), enquanto o Acre registrou o menor (8.464).
Atualmente, cerca de 67% dos contratos são regidos pela Consolidação das Leis do Trabalho
(CLT), com carteira assinada, e a maioria dos enfermeiros cumpre jornadas semanais entre 31 e 44 horas. Há anos, a categoria reivindica a regulamentação de uma jornada máxima de 30 horas, sob o argumento de que a carga horária vigente sobrecarrega os profissionais, compromete a saúde deles e afeta a qualidade do atendimento aos pacientes. Em discussão no Congresso Nacional, a Proposta de Emenda à Constituição nº 19 (PEC 19), de 2024, apoiada pelo Fórum Nacional da Enfermagem, vincula o piso salarial à jornada reduzida e prevê reajuste anual com base na inflação acumulada.
Outra informação que consta no documento refere-se a uma mudança significativa na composição da força de trabalho. Enquanto técnicos e enfermeiros ganharam espaço, houve uma redução expressiva de auxiliares. Em 2012, os técnicos respondiam por 44,8% dos vínculos formais, proporção que subiu para 58,7% em 2021. No mesmo período, a participação dos enfermeiros passou de 21,5% para 27,1%, enquanto a dos auxiliares caiu de 33,6% para 14,1%, sinalizando o gradual desaparecimento dessa função no país.
Coordenador do estudo e professor no Instituto de Medicina Social da Uerj, o pediatra Mario Dal Poz explica que a pesquisa foi pensada para qualificar o debate público sobre o futuro
da enfermagem diante de mudanças tecnológicas, demográficas e do mercado de trabalho. “A combinação entre salários baixos e a lógica do segundo emprego tende a empurrar profissionais para jornadas que se acumulam e comprometem a qualidade de vida”, diz o médico, que foi coordenador de Recursos Humanos em Saúde da Organização Mundial da Saúde (OMS), na Suíça, entre 2002 e 2012.
Também integrante da equipe de coordenação da pesquisa, a enfermeira Kênia Lara da Silva, da Escola de Enfermagem da UFMG, afirma que não é raro encontrar profissionais adoecidos que continuam trabalhando em vários locais para tentar melhorar a renda insuficiente. “Mesmo que os salários tenham crescido nominalmente, quando ajustamos os valores pelo IPCA [Índice Nacional de Preços ao Consumidor Amplo], fica evidente a perda do poder de compra da categoria”, constata. Para a enfermeira Helena Leal David, da Faculdade de Enfermagem da Uerj, outra coordenadora da pesquisa, esse cenário se soma a um desgaste cotidiano que muitas vezes antecede o adoecimento. “Com salários baixos e jornadas acumuladas, cresce o risco de exaustão e de falhas na assistência, em um trabalho que exige atenção e tomada de decisão constantes”, alerta.
Dal Poz, Silva e David são coautores de um artigo publicado em agosto de 2025 na revista Enfermagem em Foco. Liderado pelo enfermeiro Ricardo de Mattos Russo Rafael, diretor da Faculdade de Enfermagem da Uerj, o trabalho utiliza a base de dados da Relação Anual de Informações Sociais (Rais), do Ministério do Trabalho e Emprego.
Os pesquisadores analisaram mais de 9 milhões de vínculos formais de emprego de profissionais da enfermagem entre 2013 e 2022, a partir de informações como raça/cor, sexo, rendimentos médios anuais, carga horária semanal contratada, idade e escolaridade. Tomando 2022 como referência, o artigo mostra que, para ganhar o mesmo que uma mulher negra em 30 horas de trabalho, homens brancos precisariam trabalhar 6h42 a menos, mulheres brancas 5h20 a menos e homens negros 2h16 a menos, evidenciando desigualdades salariais por gênero e raça no setor.
No cenário internacional, o relatório “Situação mundial da enfermagem 2025: Investindo em educação, empregos, liderança e prestação de serviços”, divulgado no ano passado pela OMS em parceria com o Conselho Internacional de Enfermeiros (ICN) e outros parceiros, estima que o salário de entrada de profissionais de enfermagem em 2023 foi, em média, de US$ 774 p or mês (ou aproximadamente R$ 4.163,50 na
cotação de janeiro de 2026), com diferenças expressivas entre as divisões regionais da OMS e por faixa de renda.
Em nações de alta renda, o valor foi duas vezes maior do que em países de renda média alta e três vezes maior do que em países de baixa renda. Em 31 países com dados desagregados, entre eles o Brasil, a diferença salarial entre homens e mulheres é de 7%. Além da disparidade salarial, o documento identificou que os profissionais de enfermagem estão expostos à sobrecarga, falta de proteção e de suporte à saúde mental.
A desvalorização do cuidado, os baixos salários e as condições de trabalho que levam ao adoecimento são temas investigados pela socióloga Helena Hirata, pesquisadora do Centro de Pesquisas Sociológicas e Políticas de Paris, na França, e colaboradora do Departamento de Sociologia da Universidade de São Paulo (USP), em três contextos distintos: Brasil, França e Japão. No livro O cuidado: Teorias e práticas (Boitempo, 2022), ela recorre a critérios estabelecidos pela Organização das Nações Unidas (ONU) para classificar o perfil etário desses países.
Segundo o estudo, o Japão é uma sociedade “superidosa” (com pessoas de 65 anos ou mais representando cerca de 20% da população total), a França pode ser definida como uma sociedade “velha” (entre 14% e 20%) e o Brasil está prestes a se tornar uma sociedade “em envelhecimento” (entre 7% e 14%). “Nos três países, o trabalho de cuidado, que inclui a atuação de enfermeiros, é desvalorizado, o que é incompreensível, considerando o cenário de envelhecimento das populações”, disse a Pesquisa FAPESP
risco de falhas na assistência
Em 2022, a Lei nº 14.434 fixou o piso salarial nacional de R$ 4.750 para enfermeiros no Brasil, mas sua implementação tem enfrentado diversos entraves, sobretudo devido ao impacto financeiro sobre instituições públicas e privadas. “Embora a medida tenha representado uma conquista para a categoria, ela até hoje não foi inteiramente efetivada nos setores privado e filantrópico, que reúnem um expressivo contigente de profissionais”, comenta Ellen Peres, conselheira federal do Cofen e coautora do artigo publicado na revista Enfermagem em Foco mencionado anteriormente. Por meio de nota divulgada em dezembro, o Cofen afirmou que 2026 exigirá o enfrentamento de desafios estruturais que afetam o cotidiano da enfermagem, como altos índices de adoecimento

ocupacional, episódios recorrentes de violência nos serviços de saúde e a sobrecarga associada ao envelhecimento acelerado da população.
Artigo publicado no ano passado na revista Physis chama a atenção para a superexploração da força de trabalho no setor de saúde no Brasil. “A chamada pejotização e a terceirização agravam o problema ao converter relações de trabalho em contratos entre pessoas jurídicas, diluindo a dimensão humana”, alerta o sociólogo Paulo Henrique de Almeida Rodrigues, do Instituto de Medicina Social da Uerj, primeiro autor do estudo.
Pesquisadores das universidades Federal do Ceará (UFC) e Estadual do Ceará (Uece), e da Faculdade Luciano Feijão, também naquele estado, analisaram em estudo publicado em 2025, na revista Saúde e Sociedade , como relações de poder no cuidado interferem na rotina de enfermeiros e de outros profissionais de saúde. A pesquisa foi realizada entre fevereiro e dezembro de 2020 em Sobral (CE), com entrevistas e observação no serviço de emergência de um hospital público de referência e em duas Unidades Básicas de Saúde (UBS).
Os depoimentos de 33 profissionais, entre enfermeiros, médicos, odontólogos e fisioterapeutas, revelam que fatores como conhecimento técnico, gênero, experiência e categoria profissional ajudam a explicar por que determinadas vozes têm maior peso na definição de condutas clínicas. Essas assimetrias não se restringem à relação entre médicos e enfermeiros. Elas aparecem também entre profissionais de diferentes níveis de complexidade assistencial.
Nos relatos, há sentimentos de medo e impotência diante de decisões com as quais os entre-
vistados não concordam. “Às vezes vejo [condutas erradas] e não consigo falar... Não falei buscando evitar conflitos, sei que não é certo, mas foi procurando evitar conflitos, com a gestão, com o paciente, com o colega”, disse uma enfermeira da atenção primária à saúde.
“É o medo do conflito que faz as pessoas se calarem”, afirma o enfermeiro José Jeová Mourão Netto, coordenador do curso de enfermagem da Faculdade Luciano Feijão e primeiro autor do estudo. O silêncio desses profissionais pode decorrer, ainda, do receio de não dispor de argumentos suficientes para confrontar aqueles colegas percebidos como detentores de maior conhecimento. Na avaliação do pesquisador, por atuar na linha de frente e transitar entre decisões clínicas, demandas da gestão e pressão de pacientes e familiares, a enfermagem fica mais exposta aos tensionamentos decorrentes das relações de poder nos serviços de saúde.
Coautor do artigo, o sociólogo e antropólogo Leonardo Sá, da UFC, acrescenta que, além de renda e jornada, é necessário considerar a dimensão subjetiva do trabalho em saúde, marcada por sentimentos e emoções que atravessam as rotinas de profissionais de enfermagem e de outras categorias do setor. Para ele, essa camada se manifesta tanto na relação com pacientes e equipes quanto na forma como os profissionais se percebem diante da sociedade e do Estado. “Há uma tendência nas pesquisas de enfatizar os aspectos quantitativos, o que é muito importante, mas essa outra dimensão, ligada a sentimentos e emoções no cotidiano, pode inspirar reflexões sobre os dilemas existenciais dos profissionais de saúde”, conclui. l
Os artigos científicos, os relatórios e o livro consultados para esta reportagem estão listados na versão on-line.
em
de suas 14 viagens ao continente gelado

Rubens Villela foi o primeiro cientista do país a chegar ao polo Sul geográfico e abriu caminho para a pesquisa brasileira na Antártica
GUILHERME COSTA
Océlebre verso de Os Lusíadas, de Luís de Camões (?-1580), sobre mares nunca navegados caberia para descrever a trajetória pessoal do meteorologista Rubens Junqueira Villela, professor e pesquisador do Instituto de Astronomia, Geofísica e Ciências Atmosféricas (IAG) da Universidade de São Paulo (USP). Em novembro de 1961, integrando uma expedição de pesquisadores norte-americanos, ele foi o primeiro cientista brasileiro a pisar no polo Sul geográfico, ponto por onde passa o eixo imaginário de rotação da Terra, situado a 90 graus de latitude Sul. Villela morreu em 21 de janeiro, aos 95 anos, vítima de pneumonia.
O trabalho do meteorologista foi importante para a consolidação de uma visão integrada entre atmosfera, oceano e criosfera (superfície terrestre coberta por gelo). “Ele foi fundamental na articulação entre comunidade científica, Marinha do Brasil e órgãos governamentais,
bem como na defesa da ciência antártica como vetor de soberania, diplomacia científica e produção de conhecimento climático e oceanográfico”, comenta a oceanógrafa Janice Trotte-Duhá, do Instituto Nacional de Pesquisas Oceânicas (Inpo), organização social vinculada ao Ministério da Ciência, Tecnologia e Inovação (MCTI).
Antes de Villela, o médico e jornalista pernambucano Durval Sarmento da Rosa Borges (1912-1999) visitou a região. Borges, que era também professor da Faculdade de Higiene e Saúde Pública da USP, em março de 1958, tornou-se o primeiro brasileiro a chegar à Antártica com um grupo de pesquisadores norte-americanos. Seus relatos foram publicados no jornal Correio da Manhã , do Rio de Janeiro, e renderam o livro Um brasileiro na Antártica (1959), publicado pela Sociedade Geográfica Brasileira.
Villela nasceu em São Paulo e passou parte da infância em uma fazenda no mu-
nicípio de Cristais Paulista, no interior paulista. Fez vestibular para engenharia eletrônica na USP, mas não passou. Foi para os Estados Unidos, começou o curso de engenharia de minas e depois o de engenharia elétrica até se encontrar no curso de meteorologia na Universidade do Estado da Flórida, que iniciou em 1953 e concluiu em 1957. Naquela época não havia cursos similares no Brasil.
De volta ao país, chefiou o serviço de meteorologia da Real Aerovias, companhia aérea extinta em 1961. Fez o mestrado e abdicou do doutorado por causa das consultorias que completavam seus ganhos de professor em tempo parcial no IAG-USP, onde lecionou de 1974 a 2000, quando se aposentou.
Villela participou da criação do Programa Antártico Brasileiro (ProAntar), que apoia pesquisas no continente gelado e administra a Estação Antártica Comandante Ferraz, na ilha Rei George, reinaugurada em 2020. Em 1982, quando o ProAntar foi implementado, ele era um dos 12 pesquisadores a bordo do navio oceanográfico Prof. W. Besnard, da USP, para a primeira missão brasileira naquele continente.
A viagem assegurou a posição do Brasil na comunidade científica internacional antártica e facilitou a aceitação do país, no ano seguinte, como membro consultivo, com direito a voto, no Tratado da Antártica, que estabelece as regras internacionais para ocupação pacífica do continente gelado (ver Pesquisa FAPESP no 287). Além de trabalhar em suas próprias pesquisas, Villela cuidou da segurança da viagem, fazendo as previsões meteorológicas a partir de informações que chegavam por rádio.
O Prof. Besnard fez 150 viagens, das quais seis à Antártica. “Como partia de Santos, a gente descia para o litoral para se despedir e ficava um tempo andando pelo navio”, relembra o geógrafo Fernando Villela, filho de Rubens e professor do Departamento de Geografia da Faculdade de Filosofia, Letras e Ciências Humanas da USP. “Eu tinha pouco mais de 10 anos e estar ali criava todo um imaginário. Na volta, meu pai trazia muitas histórias que gostava de contar usando slides, que me marcaram bastante.”
Seu irmão, Franco Villela, é meteorologista do Instituto Nacional de Meteorologia (Inmet). Ele integra o projeto
Criosfera 1, um laboratório criado em 2012 e instalado no interior do continente antártico, onde as temperaturas chegam a 55 graus Celsius negativos.
Fernando guarda uma cópia do relatório feito por Villela para o Conselho Nacional de Desenvolvimento Científico e Tecnológico (CNPq) sobre sua p rimeira expedição, de 1961. Ele embarcou no navio como meteorologista e radiotelegrafista, função que exercia em uma agência de notícias, e só conseguiu integrar a missão após muita negociação, atuando como correspondente. Foi nessa condição que, já durante a viagem, recebeu do CNPq o título de observador científico.
P or quatro meses, de janeiro a abril, Villela navegou em um navio quebra-gelo da marinha norte-americana pelo mar de Ross, no oceano A ustral (ex-oceano Antártico), explorando a Costa de Eights. Em novembro de 1961 ele foi de novo até o polo S ul, desta vez em um avião Hércules C-130, a convite do almirante norte-americano George Dufek. Depois, voltou 12 vezes à Antártica, das quais nove em missões inteiramente nacionais. Uma de suas especialidades eram as cartas sinóticas, mapas meteorológicos de superfície usados para representar,
em um determinado momento, as condições atmosféricas em grandes áreas. A ntes dos satélites e da internet nas estações polares, Villela elaborava essas cartas manualmente de mensagens codificadas transmitidas por rádio a partir de navios, aviões e estações meteorológicas de diferentes países, decifrando os dados e desenhando à mão o quadro do tempo, com o traçado das frentes frias e massas de ar vindas do ambiente polar. Essa habilidade se tornou uma marca de sua atuação como meteorologista e era fundamental tanto para a pesquisa científica quanto para a previsão meteorológica, que garantia a segurança de operações aéreas, navais e o trabalho de pesquisadores na Antártica.
OA primeira missão brasileira ao continente gelado assegurou a posição do país na comunidade científica internacional antártica
geógrafo Francisco Aquino, do Departamento de Geografia da Universidade Federal do Rio Grande do Sul (UFRGS), o viu trabalhando em 2000 na Estação Antártica Comandante Ferraz. “Com rapidez e precisão, Villela copiava os dados das estações meteorológicas argentinas, chilenas, chinesas, uruguaias, coreanas, norte-americanas e, à mão, traçava a carta sinótica na hora”, relata o geógrafo. Como a internet ainda era precária, o monitoramento do tempo dependia da escuta, a cada três horas, das mensagens transmitidas via rádio por estações e navios que operavam na região. Essas comunicações eram enviadas por meio de códigos internacionais, criados para economizar tempo e reduzir erros na comunicação. Cada grupo de números e letras reunia informações como pressão atmosférica, temperatura, direção e velocidade do vento, cobertura de nuvens, visibilidade e ocorrência de fenômenos como neve ou chuva.
“Rubens estava interessado em meteorologia antes mesmo da criação do ProAntar”, destaca o glaciólogo Jefferson Cardia Simões, da Universidade Federal do Rio Grande do Sul e atualmente cientista líder do programa e delegado nacional no Comitê Científico de Pesquisa Antártica, organização do Conselho Internacional de Ciência (ISC). “Ele foi o mentor de vários colegas que trabalham com meteorologia e climatologia antártica”, disse.
Villela deixa dois filhos e dois netos, além da esposa, Marqueza, de 92 anos. l

Galdino Ramos ajudou a moldar a ciência das impressões digitais no início do século passado
MARIANA CECI
Em 18 de março de 1976, o pianista brasileiro Francisco Tenório Júnior, que integrava a turnê de Vinicius de Moraes (1913-1980) e Toquinho pela América Latina, saiu sozinho durante a madrugada de um hotel em Buenos Aires, na Argentina, para comer. Não voltou mais. No ano passado, quase meio século depois, foram as impressões digitais que permitiram identificar seus restos mortais e encerrar um episódio traumático da repressão política no continente. O caso de Tenório, assassinado aos 35 anos, ajuda a explicar por que a papiloscopia – a ciência que estuda os relevos da pele para a identificação humana – continua a ser uma ferramenta central da ciência forense, dentro e fora do universo policial.
Muito antes de bancos de dados digitais e sistemas automatizados de comparação, popularizados por filmes policiais, a ideia de que marcas deixadas pela pele poderiam servir como prova
científica começou a ser sistematizada no início do século XX. Embora nomes como o do polímata britânico Francis Galton (1822-1911) e dos franceses Victor Balthazard (1872-1950) e Edmond Locard (1877-1966), pioneiros da ciência forense, apareçam com frequência nessa história, um dos trabalhos decisivos para a consolidação da área surgiu no Brasil.
Em 1906, o médico Galdino Ramos (1880-1964), nascido em Picos, no Piauí, defendeu na Faculdade de Medicina do Rio de Janeiro a tese “Da identificação”, um estudo que analisou criticamente os métodos disponíveis à época e sustentou, com base científica, a superioridade das impressões digitais – inclusive em fragmentos parciais – como meio confiável de identificação humana. Na época, tese era uma monografia feita como conclusão da graduação, obrigatória para os médicos, e não o resultado de um doutorado como se conhece hoje. Durante um congresso científico realizado no Rio de
Os 44 pontos assinalam pontos característicos e indicam que a digital é da mesma pessoa, antes e depois da cicatriz que cortou as linhas (à esq.).
Ao lado, retrato de Galdino Ramos em 1905, aos 25 anos
Janeiro em 1905, ele encontrou a questão que se tornou central em sua tese: qual o sistema preferível para a identificação de indivíduos, o antropométrico (medições corporais) ou o dactiloscópico (impressões digitais)?
Segundo o estudo publicado em maio de 2025 no Boletim do Museu Paraense Emílio Goeldi , de autoria do papiloscopista Gabriel Ângelo da Silva Gomes, da Polícia Federal do Paraná, após ter escrito a tese, Ramos manteve uma atuação intelectual ativa. A partir de 1909, foi redator da revista Amazonas Médico. “A publicação tinha como proposta a produção de conteúdo científico para a região amazônica, algo inovador na época, e incluía artigos sobre datiloscopia”, afirma a historiadora e bibliotecária Maria Cláudia Santiago, do Instituto de Comunicação e Informação Científica e Tecnológica em Saúde da Fundação

Oswaldo Cruz (Icict-Fiocruz). Em 1918, Ramos tornou-se o primeiro diretor do Gabinete de Identificação do Amazonas, que contribuiu para a expansão dos serviços de identificação civil e criminal no Norte do país. Além de trabalhar como médico, foi professor na Faculdade de Medicina em Manaus. Em 1926, elegeu-se deputado estadual no Amazonas. Embora seu nome tenha permanecido por décadas à margem das narrativas clássicas da ciência forense, segundo Santiago, suas ideias circularam entre pesquisadores de dentro e fora do Brasil.

É nesse contexto que se situa a datiloscopia, técnica da papiloscopia voltada especificamente à identificação por impressões digitais . Cada impressão digital é formada pelos desenhos em relevo da pele na ponta dos dedos, conhecidos como cristas papilares, que surgem ainda durante a gestação e permanecem praticamente inalterados ao longo da vida. Ao tocar uma superfície, esses relevos podem deixar marcas visíveis ou invisíveis, passíveis de serem coletadas, reveladas e comparadas com registros existentes. Um dos princípios básicos da datiloscopia é que não existem duas impressões digitais iguais, nem mesmo entre gêmeos idênticos. Na análise, os peritos observam pequenos detalhes do traçado – como pontos onde as linhas terminam ou se bifurcam – que funcionam como uma espécie de assinatura da pele, permitindo confirmar a identidade de uma pessoa mesmo a partir de fragmentos de uma impressão.
Junto com os exames de DNA e de arcada dentária, a identificação a partir das impressões (digitais, palmares ou da planta dos pés) é considerada um dos métodos primários de identificação. A escolha entre eles depende do contexto e do tipo de material disponível. A papiloscopia se destaca por ser rápida, de baixo custo e pouco invasiva, o que a torna altamente eficiente na maioria das situações rotineiras, como investigações criminais e identificação civil. Já o DNA e a análise odontológica ganham importância em cenários mais complexos, como desastres em massa ou casos em que o corpo está muito degradado e as impressões digitais não podem ser utilizadas.
Edmond Locard, pioneiro da ciência forense na França que acompanhou o trabalho de Galdino Ramos, com a coleção de armas confiscadas de criminosos
Ao articular conhecimentos de medicina legal, estatística e prática policial, Ramos ajudou a estabelecer princípios que mais tarde seriam incorporados à formulação clássica da papiloscopia moderna. “Havia uma grande dúvida sobre qual era o método mais adequado para a identificação de indivíduos, e foi essa pergunta que o Galdino quis responder em sua tese”, afirma Gomes, que integra o grupo de pesquisa em papiloscopia forense da Academia Nacional de Polícia da Polícia Federal.
Ramos examinou os procedimentos então utilizados para a identificação,


como marcas corporais e tatuagens, e avaliou o sistema antropométrico do criminologista francês Alphonse Bertillon (1853-1914), baseado em medições do corpo humano. Apontou suas limitações, sobretudo a variabilidade do corpo ao longo do tempo e os erros associados à medição, e discutiu métodos alternativos, como os baseados em características oculares, considerados pouco viáveis na prática. Em seguida, voltou-se para a datiloscopia, com ênfase no sistema desenvolvido pelo antropólogo croata-argentino Juan Vucetich (1858-1925), analisando sua base biológica, estabilidade ao longo da vida, capacidade de classificação e potencial estatístico. Segundo Gomes, a partir dessa comparação, Ramos concluiu que as impressões digitais ofereciam o meio mais confiável, preciso e aplicável para a identificação humana.

“Da identificação” foi uma das bases utilizadas por Locard na formulação da chamada regra tripartite da identificação por impressões digitais, um dos primeiros esforços para estabelecer critérios de confiabilidade a partir da coincidência de pontos característicos em impressões incompletas.
De acordo com Gomes, a contribuição de Ramos foi particularmente importante para o debate sobre s uficiência – quantos elementos seriam necessários para sustentar uma identificação – tema que permanece importante na ciência forense contemporânea. Mesmo citada de forma indireta ou incompleta por autores posteriores, seu estudo ajudou a consolidar a noção de que fragmentos de impressões digitais podem ter alto valor identificatório.
A tese pode ter se tornado conhecida no circuito internacional por diferentes caminhos. Como mostra Gomes em a rtigo publicado no Journal of Forensic Identification em julho de 2024, Locard já acompanhava atentamente, antes mesmo de 1906, o desenvolvimento da datiloscopia na América do Sul, como indicam textos em que analisou o sistema de Vucetich e a produção sul-americana sobre identificação por impressões digitais. É plausível que o estudo de Ramos tenha chegado ao conhecimento de Locard inserido nesse a companhamento do que se produzia fora da Europa. Há também a hipótese de um contato posterior: o brasileiro esteve em Paris entre 1911 e 1912, período que antecede a publicação, em 1914, da regra tripartite de Locard – justamente o trabalho em que ele é citado. Somam-

-se a isso as redes pessoais e institucionais da época, já que Ramos dialogava com Vucetich e com o jornalista Félix Pacheco (1839-1935), responsável por traduzir textos de Locard para o português. Embora não haja evidência de uma t radução formal do estudo para outras línguas, Gomes argumenta que o texto provavelmente circulou em português dentro dessas redes especializadas, o que ajuda a explicar tanto sua influência quanto os equívocos posteriores –como a atribuição indevida a Ramos de um cálculo probabilístico originalmente proposto por outros autores.
A redescoberta da tese ocorreu mais de um século após sua defesa, a partir de uma inquietação acadêmica. Durante o mestrado em estatística na Universidade de Brasília (UnB), Gomes encontrou referências recorrentes a Ramos em textos de autores consagrados da ciência forense internacional, os quais deixaram explícito que não puderam encontrar a obra original. O pesquisador recorreu então à biblioteca de obras raras da Fiocruz, no qual, com o apoio de Santiago, o estudo foi localizado nos arquivos da Academia Nacional de Medicina. A partir daí, teve início um trabalho sistemático de resgate da memória científica de Ramos, conduzido por Gomes em parceria com Santiago e com o orientador de mestrado na UnB, o físico e estatístico Raul Matsushita. O esforço resultou na análise detalhada da tese e na recuperação do papel do médico piauiense na história da papiloscopia.
Esse resgate histórico ajuda a entender como os critérios de identificação
A identificação por meio da digital depende da combinação entre tipos e raridade dos desenhos da pele
por impressões digitais se transformaram ao longo do tempo. No início do século passado, a regra tripartite de Locard levava em conta quantidade e qualidade dos pontos coincidentes que podiam ser identificados. Com o passar das décadas, essa abordagem foi simplificada e cristalizada na chamada regra dos 12 pontos, adotada como critério fixo e, por muito tempo, considerada como incontestável em diversos países, incluindo o Brasil.
A papiloscopia contemporânea, no entanto, vem revisitando esse modelo à luz de novas evidências. Um exemplo são estudos publicados em 2024 por Gomes e outros especialistas na Revista Brasileira de Ciências Policiais e na Forensic Science International , que analisaram dezenas de milhares de minúcias em impressões de diferentes dedos, padrões e g rupos populacionais. Na papiloscopia,

os chamados pontos característicos – ou minúcias – são pequenos detalhes do desenho das cristas da pele, como bifurcações, convergências e ilhotas, que f uncionam como marcadores usados na comparação de impressões digitais. O que diferencia esses pontos não é apenas sua forma, mas a frequência com que aparecem na população. O estudo feito por Gomes mostra que alguns pontos característicos da impressão digital s ão extremamente comuns, enquanto outros são raros. Esses achados corroboram a ideia de que a força identificatória de uma impressão não depende de um número fixo de coincidências, mas da combinação entre tipo, raridade e contexto das minúcias, além da qualidade da marca analisada.
Também a inteligência artificial vem transformando a papiloscopia. Um estudo publicado em 2 024 na revista Science Advances, do estudante de ciência da computação Gabe Guo, da Universidade Columbia, nos Estados Unidos, q uestionou a ideia de que impressões digitais de dedos diferentes de uma mesma pessoa não teriam semelhanças relevantes entre si. Usando algoritmos de redes neurais profundas, os pesquisadores mostraram que essas semelhanças e xistem e podem ser detectadas com alto grau de confiança. Na prática, isso pode ter impacto direto em investigações criminais. Em cenas de crime, é c omum encontrar fragmentos de impressões digitais sem saber de qual dedo v ieram. Segundo o estudo, essas marcas poderiam ser usadas para reduzir o n úmero de possíveis suspeitos nos bancos de dados, funcionando como um filtro preliminar antes da análise pericial tradicional.
Atualmente, as digitais servem também para desbloquear o celular e outros aparelhos eletrônicos
“O campo está passando por uma transição”, resume Matsushita. “A área começa a operar de forma cada vez mais multidisciplinar e incorpora modelos computacionais capazes de lidar com grandes volumes de dados e padrões complexos.” São ferramentas, ressalta o estatístico, que não substituem o trabalho do perito, apenas ampliam as possibilidades de identificação. l
Os artigos científicos consultados para esta reportagem estão listados na versão on-line.

Curador no Museu Field, em Chicago, nos Estados Unidos, o paraibano Anderson Feijó estuda mamíferos mundo afora
Cresci em João Pessoa e os únicos estados que eu conhecia até entrar na universidade eram Pernambuco, onde nasci, e Paraíba, onde eu morava.
Sempre fui curioso e decidi fazer biologia porque um professor me disse que era possível fazer experimentos em laboratórios. Quando passei no vestibular na UFPB [Universidade Federal da Paraíba], em 2006, precisei esperar seis meses para começar, porque a universidade estava se recuperando de uma greve. Consegui estágio voluntário no Laboratório de Limnologia [estudo de ambientes de água doce] de lá. Logo percebi que organismos microscópicos não me atraíam. Acabei no laboratório de mamíferos.
Organizava o laboratório e lavava utensílios, e comecei a viajar para trabalhos de
campo. Meu primeiro projeto foi ajudar um aluno de graduação que coletava em áreas da Mata Atlântica com diferentes níveis de regeneração. Eu não tinha nenhuma experiência de acampar, nenhuma habilidade específica. Mas fui aprendendo e vi que era isso que eu queria fazer.
Fiz a pós-graduação na UFPB e no doutorado passei um ano, com bolsa-sanduíche, no museu em que estou agora –o Field, em Chicago. Trabalhei com um professor bem conhecido na área, Bruce Patterson. Foi a primeira vez que vi neve. Aqui, percebi que muitas coisas que me interessavam poderiam ser feitas trabalhando com coleções científicas, como projetos sobre evolução e adaptação a diferentes ambientes. Quando eu voltei ao Brasil, tinha uma visão mais ampla do que poderia fazer como profissional.
Terminei o doutorado em 2017, uma época de pouco investimento em ciência no Brasil. Mandei sete pedidos de pós-doutorado para diferentes instituições, e nada. Então busquei alternativas fora do país. Uma delas foi em Beijing, na China. Encontrei o site de um professor e me candidatei a uma vaga de pós-doutorado com a proposta de explorar u ma fauna diferente da que conhecia. Três meses depois, eu embarcava para a China.
No Instituto de Zoologia da Academia Chinesa de Ciências, onde trabalhei, me comunicava em inglês, mas fora do ambiente acadêmico poucas pessoas falavam esse idioma. Fiz um esforço para aprender mandarim suficiente para sobreviver no dia a dia. Em 2021, fui contratado como professor no mesmo instituto.
Em 2022, Patterson me avisou que tinha se aposentado e me encorajou a me candidatar à vaga para substituí-lo. Imaginei que procurariam um pesquisador sênior, mas deu certo e há dois anos sou curador de mamíferos do Field.
Tenho quatro responsabilidades: pesquisa, curadoria (que é cuidar da coleção, propor formas de aumentá-la e torná-la acessível a pesquisadores), serviço (atuar em comitês e participar na montagem de exposições abertas ao público) e educação (orientar alunos, dar aulas e workshops). O museu é independente, mas sou associado às universidades de Chicago e de Illinois. Agora tenho quatro alunos desenvolvendo o doutorado, inclusive uma brasileira que também fez o mestrado em João Pessoa.
Trabalhei em uma variedade de lugares, do Brasil ao Tibete. Há muitas similaridades, porque seguimos métodos parecidos de coleta, mas a fauna é totalmente diferente. Vindo de João Pessoa, eu não tinha contato com montanhas.
Na China, começávamos a trabalhar a 2 mil metros [m], que são altitudes relativamente baixas para eles. Ao longo do mês, subíamos aos poucos até cerca de 4,5 mil m. Nos hospedávamos em vilas pequenas, onde muitas vezes os habitantes nunca tinham visto um estrangeiro. As crianças vinham tirar foto comigo.
Fazíamos inventários para documentar como os diferentes grupos de mamíferos mudam à medida que a elevação aumenta. Também trabalhei com um grupo de coelhos chamado pika, que se originou no Tibete e consegue sobreviver a altitudes até 6,2 mil m. Minhas pesquisas buscavam entender como isso é possível. Descobrimos vários genes ligados

ao sistema imune que permitem a esses animais lidar com as mutações causadas pela intensa radiação ultravioleta.
No Brasil, uma das minhas espécies preferidas é o tatu-bola-da-caatinga [Tolypeutes tricinctus], o único tatu endêmico do país. Desde 2014, atuo como um dos coordenadores executivos do Plano de Ação Nacional organizado pelo ICMBio [Instituto Chico Mendes de Conservação da Biodiversidade]. A ideia é reunir um grupo de pesquisadores com diversas especialidades para conseguir mais informações sobre a espécie e com isso ajudar a definir programas de conservação. No doutorado, trabalhei com a diversidade do tatu-galinha [ gênero Dasypus]. Descobri que existiam bem mais espécies do que se achava, principalmente na região amazônica.
Para fazer esse trabalho visitei 41 coleções na América do Sul, nos Estados Unidos e na Europa. Usando minha bolsa de doutorado para financiar essas visitas, fiz uma viagem de seis meses de ônibus, saindo do Rio Grande do Sul e passando pelo Uruguai, até a Venezuela, visitando cada coleção. Eu nunca tinha saído do Brasil e não sabia nada de espanhol, fui aprendendo ao longo da viagem. Nesse percurso, conheci pesquisadores e professores com quem hoje colaboro.

Em frente ao seu local de trabalho atual, em dezembro de 2025, e em 2018 usando cesto tradicional para carregar armadilhas em Sichuan, na China DEPOIMENTO CONCEDIDO A
Estou iniciando novos projetos nos Andes e no Caribe, buscando entender como diferentes grupos de mamíferos respondem e se adaptam às mudanças climáticas. Também planejo continuar fazendo viagens à China para manter projetos e colaborações. Atualmente,
sou pesquisador visitante no instituto onde trabalhei por sete anos.
Moro em um bairro com forte cultura asiática, com influência da China, do Vietnã e da Tailândia. Fica a 10 minutos da praia daqui, que na verdade é o lago Michigan. Isso supera um pouco a carência de mar que sinto. O mais difícil para mim é o inverno, as temperaturas chegam a -25 graus Celsius (°C).
Na minha trajetória, viajando por diversos países, nunca me senti discriminado. Sei que isso não é habitual, acho que tive sorte ou não notei. Na China, percebia nas pessoas uma curiosidade autêntica por entender o que eu estava fazendo lá, como era a vida no meu país.
Já estou acostumado com a vida em inglês, quando vou ao Brasil preciso de uns dias para retomar o meu sotaque nordestino. Durante minha estada na China, visitei poucas vezes o Brasil, mas agora quero voltar a fazer projetos de campo na Caatinga e aproveitar o verão brasileiro para fugir do inverno daqui.
Sou muito agradecido ao apoio dos meus pais ao longo da minha formação. Tive o privilégio de me dedicar exclusivamente à graduação e pós-graduação e não precisei trabalhar para me m anter financeiramente. O fato de eu ter sido criado e formado em João Pessoa, e não em um grande centro, não foi limitante na minha carreira. Como cientista em uma instituição renomada, tenho como objetivo pessoal retribuir as oportunidades e dar espaço à nova geração de estudantes. l
ROBERTO CONDURU

Elisa Martins da Silveira nasceu em Teresina, no Piauí, em 1912. Em 1945, após se divorciar, passou a viver no Rio de Janeiro, onde faleceu em 2001. Professora e depois funcionária pública, ela começou a estudar arte com Ivan Serpa no Museu de Arte Moderna, em 1952. A convite dele, Elisa integrou o grupo Frente, reunido em torno da ideia de experimentação, que incluía Hélio Oiticica, Lygia Clark, Lygia Pape, entre outros. Desde então, suas obras foram expostas em museus, bienais e galerias comerciais, sendo premiadas e incorporadas a coleções públicas e privadas no Brasil e no exterior.
XVIII em referência à simplicidade e grandeza da arte dos antigos gregos, a alcunha de primitiva foi mudando de objeto desde então, sendo aplicada à arte de contextos tão variados quanto a Itália antes do Renascimento, o Japão e a África, mas também à de pessoas internas em hospitais psiquiátricos, crianças, entre outras.
Tal como primitivo é um termo de cunho não somente pejorativo, a arte assim considerada era objeto de uma complexa atração, que valorizava sua potência plástico-simbólica e oposição à arte acadêmica, mas estava embebida em colonialismo, racismo, classismo, patriarcalismo e misoginia.
Editora 7Letras
164 páginas
Fosse pela economia plástica de sua pintura –farta em figuras não ilusionistas, minuciosamente descritas, várias padronagens e cores vívidas – ou por ser nordestina, de meia-idade e autodidata, Elisa foi classificada como artista naïf, ingênua, espontânea e popular. De início, ela participou tanto de exposições com obras de variadas tendências artísticas quanto de mostras dedicadas exclusivamente à arte considerada primitiva, nicho ao qual seu trabalho ficou restrito a partir dos anos 1970.
Elisa Martins da Silveira: “Arte naïf” posta em questão contribui para a história da arte no Brasil não apenas por ser o primeiro livro dedicado exclusivamente ao trabalho dela. Com sua precisa ambiguidade, o título anuncia a amplitude da leitura de Felipe Scovino, professor da Escola de Belas
A rtes da Universidade Federal do Rio de Janeiro (UFRJ), e lança uma pergunta: quem questiona a ideia de arte primitiva, a pintura ou a historiografia? Ele responde ao longo do volume: ambas.
O historiador revê criticamente a trajetória da pintora e o modo como sua obra tem sido enquadrada por agentes e instituições do meio da a rte, discutindo a difusão da ideia de arte primitiva no Brasil desde meados do século XX. Não por acaso, ele entrelaça esses caminhos. Por um lado, é necessário desmontar a moldura em que o trabalho de Elisa ainda está inserido para melhor experimentá-lo; por outro, a trajetória e a obra dela constituem um caso singular com o qual critica o entendimento de arte primitiva ainda vigente.
Em The preference for the primitive (2002), E. H. Gombrich mostra como o primitivismo era intrínseco à modernidade. Adotada no final do século
Scovino mostra que Serpa e os críticos Mario Pedrosa e Ferreira Gullar concebiam o primitivo de modo positivo, porém não isento de preconceitos. Também no caso brasileiro, a ideia de arte primitiva estava associada a distinções hierarquizantes a partir de marcadores sociais como classe, raça e gênero. A “arte primitiva” era uma vertente de um modernismo ambiguamente inclusivo no qual Elisa chegou a ser considerada uma “primitiva especial” e até uma “pseudoprimitiva”.
Muito do que foi inicialmente taxado de primitivo, depois deixou de ser assim avaliado. Não é negativo o entendimento de primitivo quando associado à arte italiana produzida entre os séculos XIII e XV. Carl Einstein começa seu livro Negerplastik (1915) excluindo do método de análise da arte africana o “falso conceito de primitivismo”. Não obstante, essa pecha ainda ofusca a obra de Elisa.
Analisando as telas dela, aproximando e diferenciando-as de obras de outros artistas classificados como primitivos – José Antônio da Silva, Djanira da Motta e Silva, Maria Auxiliadora da Silva, entre outros –, Scovino começa a desmantelar o enquadramento institucional que as aprisiona. No futuro, será crucial libertar Elisa Martins da Silveira da cela do primitivismo. Pensar como seu trabalho se transformou ao longo do tempo. E retomar a convivência de suas pinturas com as obras de seus colegas no grupo Frente, assim como promover diálogos com outras criações, ultrapassando barreiras sociais, de tempo e espaço.
PRESIDENTE
Marco Antonio Zago
VICE-PRESIDENTE
Carmino Antonio de Souza
CONSELHO SUPERIOR
Antonio José de Almeida Meirelles, Carlos Gilberto Carlotti Junior, Felipe Ferreira Guimarães Figueiredo, Franklim Shunjiro Nishimura, Helena Bonciani Nader, Herman Jacobus Cornelis Voorwald, Marcílio Alves, Maria Arminda do Nascimento Arruda, Pedro Wongtschowski, Thelma Krug
CONSELHO TÉCNICO-ADMINISTRATIVO
DIRETOR-PRESIDENTE
Carlos Frederico de Oliveira Graeff
DIRETOR CIENTÍFICO
Marcio de Castro Silva Filho
DIRETOR ADMINISTRATIVO
Fernando Menezes de Almeida
ISSN 1519-8774
COMITÊ CIENTÍFICO
Luiz Roberto Giorgetti de Britto (Presidente), Ana Claudia Latronico, Ana Claudia Torrecilhas, Ana Cristina Gales, Ana Maria Fonseca de Almeida, Carlos Frederico de Oliveira Graeff, Daniel Scherer Moura, Dario Simões Zamboni, Deisy de Souza, Douglas Zampieri, Eduardo Magalhães Rego, Eduardo Zancul, Fabiana Cristina Komesu, Fernando Menezes de Almeida, Flávio Henrique da Silva, Gustavo Dalpian, Helena Lage Ferreira, João Pereira Leite, José Roberto de França Arruda, Lício Augusto Velloso, Liliam Sanchez Carrete, Luiz Nunes de Oliveira, Luiz Vitor de Souza Filho, Marcio de Castro Silva Filho, Marco Antonio Zago, Mariana Cabral de Oliveira, Marta Arretche, Michelle Ratton Sanchez Badin, Nina Stocco Ranieri, Paulo Schor, Richard Charles Garratt, Rodolfo Jardim Azevedo, Sergio Costa Oliveira, Sidney José Lima Ribeiro, Sylvio Canuto, Vilson Rosa de Almeida
COORDENADOR CIENTÍFICO
Luiz Roberto Giorgetti de Britto
DIRETORA DE REDAÇÃO
Alexandra Ozorio de Almeida
EDITOR-CHEFE
Neldson Marcolin
EDITORES Fabrício Marques (Política Científica e Tecnológica), Carlos Fioravanti (Ciências da Terra), Marcos Pivetta (Ciências Exatas), Maria Guimarães (Ciências Biológicas), Ricardo Zorzetto (Ciências Biomédicas), Yuri Vasconcelos (Tecnologia), Ana Paula Orlandi (Humanidades) e Christina Queiroz (editora assistente)
REPÓRTER Sarah Schmidt
ARTE Claudia Warrak (Editora), Júlia Cherem Rodrigues e Maria Cecilia Felli (Designers), Alexandre Affonso (Editor de infografia)
FOTÓGRAFO Léo Ramos Chaves
BANCO DE IMAGENS Valter Rodrigues
SITE Yuri Vasconcelos (Coordenador), Jayne Oliveira (Coordenadora de produção), Kézia Stringhini (Redatora on-line)
MÍDIAS DIGITAIS Maria Guimarães (Coordenadora), Renata Oliveira do Prado (Editora de mídias sociais), Vitória do Couto (Designer digital )
VÍDEOS Christina Queiroz (Coordenadora)
RÁDIO Fabrício Marques (Coordenador) e Sarah Caravieri (Produção)
REVISÃO Alexandre Oliveira e Margô Negro
REVISÃO TÉCNICA Ana Cristina Gales, Ana Maria de Almeida, Célio Haddad, Emmanuel Dias-Neto, Gabriela Pellegrino Soares, Gustavo Romero, José Luiz Proença Modena, José Roberto Arruda, Isabela Benseñor, Luiz Aragão, Maria de Fátima Morethy Couto, Maurice de Koning, Sidney Ribeiro de Lima, William Wolf, Yara Frateschi
COLABORADORES Ana Beatriz Rangel, Ana Matsusaki, Domingos Zaparolli, Gilberto Stam, Giselle Soares, Guilherme Costa, João Paulo Marques, Igor Zolnerkevic, Mariana Ceci, Roberto Conduru
MARKETING E PUBLICIDADE Paula Iliadis
CIRCULAÇÃO Aparecida Fernandes (Coordenadora de Assinaturas)
OPERAÇÕES Andressa Matias
SECRETÁRIA DA REDAÇÃO Ingrid Teodoro
É PROIBIDA A REPRODUÇÃO TOTAL OU PARCIAL DE TEXTOS, FOTOS, ILUSTRAÇÕES E INFOGRÁFICOS SEM PRÉVIA AUTORIZAÇÃO
TIRAGEM 25.050 exemplares
IMPRESSÃO Plural Indústria Gráfica
DISTRIBUIÇÃO R AC Mídia Editora
GESTÃO ADMINISTRATIVA FUSP – FUNDAÇÃO DE APOIO
À UNIVERSIDADE DE SÃO PAULO
PESQUISA FAPESP Rua Joaquim Antunes, nº 727, 10º andar, CEP 05415-012, Pinheiros, São Paulo-SP
FAPESP Rua Pio XI, nº 1.500, CEP 05468-901, Alto da Lapa, São Paulo-SP
Secretaria de Desenvolvimento Econômico, Ciência, Tecnologia e Inovação
GOVERNO DO ESTADO DE SÃO PAULO


AMIR CALDEIRA
A importância do trabalho do físico Amir Caldeira não depende de um prêmio (“Quando a física muda de escala”, edição 359).
Rodolfo Valentin
A física quântica sempre traz surpresas incríveis.
Daniel Bryan
PLANTIO DE CANNABIS
Importantíssimo para pessoas com doenças neurológicas, como Parkinson (“Cultivo monitorado”, edição 359).
Ariela Boaventura
JUMENTOS
O que impressiona é que para evitar a extinção dos jumentos estão buscando outras formas de explorar esses animais (“Para salvar os orelhudos”, edição 359).
Luanda Francine
SORBONNE FORA
Excelente decisão o desligamento da Universidade Sorbonne de rankings acadêmicos produzidos pela revista Times Higher Education (“Metodologia questionada”, edição 358). A que servem tais rankings que comparam
ASSINATURAS, RENOVAÇÃO E MUDANÇA DE ENDEREÇO
Envie um e-mail para assinaturaspesquisa@fapesp.br
PARA ANUNCIAR
Contate: Paula Iliadis E-mail: publicidade@fapesp.br
EDIÇÕES ANTERIORES
Preço atual de capa acrescido do custo de postagem. Peça pelo e-mail: assinaturaspesquisa@fapesp.br
LICENCIAMENTO DE CONTEÚDO
Adquira os direitos de reprodução de textos e imagens de Pesquisa FAPESP E-mail: redacao@fapesp.br
o incomparável, uma vez que descontextualizam as realidades das instituições, cultural e historicamente?
Michele Schultz
HISTÓRIA DO TELEJORNALISMO
A nota “Relíquias do telejornalismo” (edição 358) permite que professores da educação básica, como eu, conheçam acervos audiovisuais que vêm s endo disponibilizados ao público.
A divulgação de telejornais da TV Tupi pode se tornar uma ferramenta muito interessante para o ensino de história e, ao mesmo tempo, evidenciar as transformações da mídia no Brasil.
Rubens Baldini Neto
Gostei muito da retrospectiva “Ciência em imagens: retrospectiva 2025”. Abordou o máximo de áreas possível.
Flávio Viana Gomide
Obrigada pelo vídeo “O punk no Brasil”. Com ele consegui fazer meu projeto e finalizar minha graduação.
Sthael Langbehn
Sua opinião é bem-vinda. As mensagens poderão ser resumidas por motivo de espaço e clareza.
CONTATOS
revistapesquisa.fapesp.br
redacao@fapesp.br PesquisaFapesp pesquisa_fapesp @pesquisa_fapesp PesquisaFapesp pesquisafapesp cartas@fapesp.br
R. Joaquim Antunes, 727 10º andar
CEP 05415-012
São Paulo, SP
Sua pesquisa rende fotos bonitas? Mande para imagempesquisa@fapesp.br Seu trabalho poderá ser publicado na revista.

Quem já se deparou com amendoim ou milho mofado talvez possa culpar o fungo Aspergillus flavus. Ele reveste a semente com um biofilme e produz uma substância cancerígena, a aflatoxina. Com uma nova técnica de microscopia desenvolvida por João Paulo Marques, o grupo coordenado pelo biólogo Gilberto Úbida Leite Braga, da Universidade de São Paulo (USP), campus de Ribeirão Preto, consegue fazer a reconstituição tridimensional da matriz extracelular (verde) e das hifas fúngicas entremeadas (vermelho), que pode ser examinada ao longo do tempo. Com isso, busca formas de intervir nesse processo, investigando como o biofilme se desenvolve. O trabalho faz parte do doutorado da bióloga Camila Guedes Francisco.
Imagem enviada pelo biólogo João Paulo Marques , do campus de Pirassununga da USP
O MELHOR DO JORNALISMO CIENTÍFICO NA SUA CAIXA DE ENTRADA
Escolha o que quer receber: conteúdo completo da edição mensal, destaques semanais do site, novidades sobre inovação e empresas, notícias sobre integridade científica, dicas dos editores da revista e as versões em inglês e espanhol
INSCREVA-SE bit.ly/BoletimPesqFapesp



DO
DA
